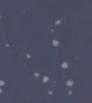

Ausgabe 2-2024
Hergestellt mit Unterstützung der























Ausgabe 2-2024
Hergestellt mit Unterstützung der



























BABYBOOMER: RISSE IN UNSERER GESELLSCHAFT
TRACHT: FRAUEN & LEBENSGESCHICHTEN
PATEN: KREBS-KINDERKLINIK TÜBINGEN
BULLDOG: MIT » RAMBO « NACH MERAN






Heftgratis für Sie zum Mitnehmen!



Liebe Leserinnen und Leser, unsere Gesellschaft scheint zerrissen: die Babyboomer, also die geburtenstarken Jahrgänge zwischen 1955 und 1969, sollen an allem schuld sein, der verseuchten Umwelt, dem kaputten Klima, der maroden Infrastruktur und der leergeräumten Rentenkassen - um nur einige der Vorwürfe der Zoomer-Generation (geboren zwischen 1996 und 2009) zu nennen (siehe Seite 12 ff).
Wir hätten ja schließlich keine Krisen erlebt, außer der Ölkrise, und wären im Wohlstand aufgewachsen. Wenn ich das mal aus meiner Warte aus betrachten darf, war in unserer Kindheit und Jugend nirgends etwas von einem Wohlstand zu spüren. Wir mussten sparen, wir gingen nie in Urlaub, jeder Pfennig wurde zur Seite gelegt, um ein Haus bauen zu können. Und Krisen habe ich in meinem Umfeld genug erlebt. Wir sind damals alle „körperfern erzogen“ worden, d.h. eine Umarmung oder ein „Sich-um-das-Kind-kümmern“ in emotionaler Form, besonders in der Öffentlichkeit, war nicht erwünscht, das stand sogar in einschlägigen „Erziehungsratgebern“ aus dieser Zeit.

Meine Mutter, die das „richtige Hauswirtschaften“ bei einer resoluten Schwäbin gelernt hat, sah ich bei uns zu Hause nur in einer schneeweißen Kittelschürze umherrennen und den Haushalt machen, den Garten mit Gemüsebeet bestellen, Kleidung für uns nähen, auf der Baustelle helfen – und das in totaler Perfektion. Mein Vater war auch den ganzen Tag arbeiten und außer Haus. Da war für Fragen nach den Hausaufgaben oder unseren „Befindlichkeiten“ kein Zeitfenster mehr übrig – leider! Es zählte Disziplin, Leistung und Gehorsam, auch in der Schule und in der Ausbildung. Wir hatten als Kind keinerlei Mitspracherecht, die Eltern haben alles entschieden. Wir hatten zu funktionieren ohne Widerrede. Meine ältere Schwester bekam in der Schule noch „Tatzen“, das waren Schläge mit dem Rohrstock auf die Finger, wenn man nicht parierte. Wir bekamen die Härte der im Krieg aufgewachsenen, traumatisierten Eltern und Großeltern zu spüren, die uns jedoch versorgt und schließlich alles aufgebaut haben. Die Wirtschaft kam ins Laufen, man wollte schnell nach vorne sehen, Neues erschaffen, eine Familie gründen, ein Haus bauen – in der Elterngeneration und auch bei uns Boomern. Doch hierfür musste man auch im Beruf vorwärtskommen – trotz großer Konkurrenz der Gleichaltrigen – und entsprechend Geld verdienen. Hierzu brauchte es Leistung, Wille und Arbeitskraft – 50-60-Stunden-Woche war normal. Es entstand der Begriff der Workaholics nicht umsonst. Wir waren so erzogen worden, Stillstand gab es nicht! Ob das richtig war? Mit dieser Boomer-Energie sind allerdings viele bahnbrechende Entwicklungen erst möglich geworden - auch das heutige Smartphone, das von den jungen Leuten heutzutage den ganzen Tag genutzt wird. Dass aber damit auch Energien, die klimaschädlich sind, verbraucht werden und Kinder in Afrika unter unmenschlichen Bedingungen die seltenen Erden für unsere neuen Techniken aus dem Boden fördern müssen, damit wir „grün“ unsere Elektro-Autos fahren können, will keiner wissen, auch die Zoomer nicht. Mittlerweile hat sich ja umweltschutztechnisch bei uns einiges getan, wenn ich aber die Weltkarte anschaue und die Kontinente wie Asien, Indien und Russland sehe, die weitermachen wie zuvor, und unser „Mini“-Deutschland jetzt die Welt retten soll, ist mein Verständnis sehr begrenzt. Können wir die weltweite Umweltverschmutzung aufhalten, obwohl viele Länder um uns herum nur sehr eingeschränkt bei der Lösung der Umwelt-/Klimaprobleme mitmachen? Klimagipfel hin oder her ...
Von gegenseitigen Schuldzuweisungen haben wir alle nichts. Wir sollten voneinander lernen, uns gegenseitig zuhören, für alle Generationen zusammenstehen und neue Ideen für unsere Probleme entwickeln. Gemeinsam könnten wir es schaffen, ich bin fest davon überzeugt.
Genießen Sie alle miteinander schöne Feiertage – und bleiben Sie gesund.
Ihre Simone Bok
IMPRESSUM
Herausgeberin/Gesamtherstellung:
Simone Bok, Agentur für Mediengestaltung, Hans-Wagenpfeil-Str. 4, 72160 Horb a. N., Tel. 074 51/62 26 53, info@bok-medien.de www.generationen-im-dialog.de
Redaktion verantwortl.: Simone Bok Erscheinungsweise: 2x jährlich April/Mai und November/Dezember; Erhältlich bei den Filialen der Sparkasse Pforzheim Calw,
INHALT: SEITE
Bauen & Wohnen, neue Bad-Ideen 4 – 9
Paten für krebskranke Kinder in der Uni-Klinik Tübingen10 – 11
ZDF „37°Leben“: Risse in unserer Gesellschaft12 – 15
Reisethemen: 14 – 15
• Weihnachtsschiff auf dem Bodensee 16
• Pferdemarkt in Ellwangen17
• Mit dem Bulldog nach Meran 18 – 19
Bastel- und Geschenktipps20 – 21
Spiele/Deko/Buchvorstellung22 – 23
ZDF „37°Leben“:
„Bei Anruf Baby“ 24 – 25
Der KreisSeniorenRat informiert 26 – 29
Rechtsberatung:
Isabell Hutter-Vortisch30 – 31
Trachtenausstellung im DZM in Ulm 32 – 33
Pflege, Einrichtungen, Hilfsmittel & mehr34 – 39
AOK: Fitness bis ins hohe Alter40
SPPS: 30-jähriges Jubiläum41
Kursangebot TherapieHaus/ SiWave-Schwingungsplatte42 – 43
Gesundheitstipps44 – 45
Hören & Demenz46 – 47
Kulturhaus Osterfeld: Varieté „Winterträume“ 48 – 49
Schmuckmuseum: Ausstellung „Gernot Leibold“50 – 51
Theater Pforzheim: Weihnachts- & Silvesterprogramm 52 – 53
Rezepte: Haferwraps, Dips, Franzi-Likör54 – 55
Vorsorge für die letzte Reise & Erinnerungsschmuck56 – 57
Sparen/Vorsorgen/Versichern58
Sparkasse Pforzheim Calw: Veranstaltungskalender59
Titelfoto: Großmutter mit Enkelin Foto: AdobeStock
beim KreisSeniorenRat Enzkreis –Stadt Pforzheim e.V., im Theater Pforzheim, bei allen Anzeigenkunden des Heftes, bei vielen gemeinnützigen Institutionen und Vereinen sowie bei der Herausgeberin.
Ob neue Fassadenverkleidung, Terrassenbodenaustausch oder barrierefreies Badezimmer –rund

Edles Lärchen-, Douglasien- und Zedernholz aus den Gebirgsketten der kanadischen Rocky Mountains sieht fantastisch aus und stammt bei Osmo aus nachhaltiger Forstwirtschaft.
(Foto: Osmo)




Dank eines speziellen UV-Schutzes sind HPL Bauund Fassadenplatten von widerstandsfähig gegen Witterung – ihre schöne Optik bleibt dauer haft erhalten. (Foto: epr/Gutta)



Das hochwertige Sanitärzubehör der Serie ViCare von lässt sich einfach nachrüsten, sodass sich das Bad auch barrierefrei nutzen lässt.
(Foto: epr/Villeroy & Boch)




Naturholzmöbel von verleihen mit ihrer kraftvollen Präsenz jedem Interieur das gewisse Extra.






WPC-Dielen von Trex sind resistent gegen Verziehen, Verrotten sowie Verblassen und Flecken. Der Hersteller gewährt sogar 25 bis 50 Jahre Garantie darauf. (Foto: epr/Trex Company)



Laut Gebäudeenergiegesetz (GEG) dürfen in Neubauten nur noch auf einem 65-prozentigen Anteil erneuerbarer Energien basierende Heizungen installiert werden. Die Fördermittel zur Heizungsmodernisierung werden bis zu 70 Prozent der Investitionskosten gewährt. Infos gibt es unter www.intelligent-heizen.info.

Digital statt analog: Die neuen Abrechnungsrege lungen der Heizkostenverordnung (HKVO) kommen Wohnungseigentümern sowie Mietern zugute. Neu installierte Messtechnik muss künftig aus der Ferne ablesbar sein, bestehende Messtechnik ohne Funk bis Ende 2026 nachgerüstet oder ausgetauscht sein. Infos: www.minol.de/connect.

Vollautomatische Pelletheizungen zeichnen sich durch saubere Verbrennung mit minimalen Feinstaubemissionen aus. Mit der von ÖkoFEN entwickelten ZeroFlame-Technologie können sie sogar dem Nullwert nahekommen. Die Pellets entstehen aus Reststoffen der Sägewerke, kein Baum wird gefällt. Eine weitere gute Lösung für grüne Wärme ist die Luft-Wasser-Wärmepumpe. Für den Einbau der modernen Heizsysteme sind Fördersätze von 9.000 bis 23.500 Euro drin. Infos: www.oekofen.com



Dialogfähigkeit ist keine Frage des Alters. Gute Nachbarn wissen das, gute Vermieter auch.

„Wenn wir unser Traumhaus entwerfen, soll dieses vor allem



Beruhigt schlafen kann der, der auf einbruchsichere Fenster setzt. Die im System KF 500 eingebaute I-tec-Lüftung ermöglicht, dass der Raum mit Frischluft versorgt wird, während das Fenster verschlossen bleibt.


ENTSPANNT LÜFTEN


Aus Sorge vor Einbrechern scheuen sich viele davor, die Fenster über eine längere Zeit offen zu lassen. Beim „Schlöffnen“ ist dies bedenkenlos möglich, dabei stellt sich der Fensterflügel zum Lüften um einen umlaufenden Spalt von circa sechs Millimetern vom Rahmen ab.











Die Mehrpunktverriegelung der MACO-PROTECTTürschlösser sorgt für mehr Sicherheit an der Haustür und macht Einbrechern das Leben schwer.

DIE SCHOTTEN DICHT MACHEN






Ein abschließbarer Fenstergriff der Marke Weru ergänzt einbruchhemmende Systeme optimal und bietet zusätzliche Sicherheit.



Flächenheizungen sind klassischen Heizkörpern überlegen, weil sie deutlich niedrigere Vorlauftemperaturen benötigen. In vorgefertigten Lehm-Trockenbauelementen, etwa vom Lehm-Trockenbaupionier naturbo, fügen sie dem energetischen Vorsprung weitere Vorteile hinzu. Ihre gesunde Wärmestrahlung ist bereits nach 10 Minuten zu spüren. Der Einbau der Trockenbauelemente ist unkompliziert: www.naturbo.de.
Von den Vorteilen einer Fußbodenheizung können auch Eigentümer älterer Gebäude profitieren. Im Zuge eines Heizungstausches bietet sich die Nachrüstung an, um neben dem Komfortgewinn von einer verbesserten Energieeffizienz zu profitieren. Für eine sichere und gleichzeitig wirtschaftliche Verlegung der Heizungsrohre sind etwa Calciumsulfat-Fließestriche gut geeignet. Sie lassen sich von Handwerkern einfach verarbeiten, sie trocknen schnell und ermöglichen geringe Aufbauhöhen. Info: www.vdpm.info






Elektrische Boden- und Wandheizungen geben eine milde, wohltuende Strahlungswärme ab. Die Ditra-Heat-E von Schlüter Systems entfaltet ihr volles Potenzial in Kombination mit keramischen Fliesen oder Natursteinplatten. In Kombination mit einer Smarthome-Technik lässt sich die elektrische Boden- und Wandheizung flexibel regeln mit wenig Energie. Infos: www.schlueter.de.
Anzeige

Hier wohnen Sie sicher
Auf uns können Sie sich ganz verlassen – Sie haben als Mitglied der Genossenschaft ein lebenslanges Wohnrecht.
Soziale Bindung inklusive
Bei der Organisation Ihres Alltags stehen wir Ihnen mit Rat und Tat zur Seite, z.B. mit der Vermittlung wohnbegleitender Dienstleistungen wie Einkaufshilfen, Wohnungsreinigung oder die Begleitung zum Arzt (betreutes Wohnen) u.v.m.

Frei bewegen ohne Barrieren
Viele Wohnanlagen sind mit Aufzug ausgestattet und haben einen barrierefreien Zugang zur Wohnung.

· Tel. 0 72 31 - 9 31 90
Mit dem cleveren Komplettset

Schlüter-KERDI-BOARD lassen sich
Waschtische individuell gestalten –bei Bedarf auch unterfahrbar.

Schwungvoller Start in den Tag für die ganze Familie, Ladestation für neue Energie am Abend, zwischendrin Oase der Entspannung: Ein modernes Generationenbad erhöht das Wohlfühlen und erleichtert den Alltag. Besonders wenn es um die Gestaltung geht, lohnt sich deshalb für Bauherren und Modernisierer ein Blick in die Zukunft. Denn Bedürfnisse wandeln sich im Laufe des Lebens – und was später einmal wichtig werden kann, wertet das Badezimmer bereits jetzt auf.
Der Wunsch nach zeitgemäßer Ästhetik ist dabei ebenso groß wie der nach Komfort und Barrierefreiheit. Intelligente Systemlösungen leisten beides. Für bodengleiche Duschen bietet Schlüter-Systems mit KERDI-LINE-VARIO ein elegantes Entwässerungssystem, das variabel angepasst werden kann und für die individuelle Badgestaltung in zwölf strukturbeschichteten
TRENDLINE-Oberflächen für bodengleiche Duschen: die Linienentwässerung Schlüter-KERDI-LINE-VARIO.

Elektrische Boden- und Wandheizung Schlüter-DITRA-HEAT-E.

TRENDLINE-Oberflächen zur Verfügung steht. Ein Extra an Flexibilität ist durch den um 360 Grad drehbaren Ablauf garantiert. Waschtische, so einzigartig wie die Einrichtungswünsche von Bauherren und Renovierern, entstehen mit Schlüter-KERDIBOARD: Es lässt sich nach Wunsch zuschneiden und befliesen – selbst in freischwebender Optik. Auch in die Wand integrierte Nischen und beheizbare Sitzbänke in oder neben der Dusche sind mit dem universalen Verlegeuntergrund problemlos realisierbar. Was ebenfalls eine wichtige Rolle im Bad spielt? Wärme und Licht. Punktgenaue Wärme auf dem Boden und an den Wänden schafft die elektrische Flächenheizung SchlüterDITRA-HEAT-E. Mehr Sicherheit und Wohlbefinden verspricht zusätzlich ein abgestimmtes Beleuchtungskonzept mit dem Lichtprofilsystem LIPROTEC. Infos unter www.schlueter.de.




Die vielseitigen LED-Module der LIPROTEC-Produktlinie –kreatives Zusammenspiel von Licht und Keramik.



Schon längst hat das Bad sein Image als rein funktionale Nasszelle abgelegt – vielerorts entstehen gemütliche Wellness-Welten, die zum Entspannen einladen. Barrierefreiheit ist hierbei nicht nur ein wichtiger Komfortfaktor für die Gegenwart, sondern auch eine Investition in die Zukunft, um möglichst lange autark in den eigenen vier Wänden leben zu können. Dafür braucht es keine aufwendige Komplettsanierung. Mit barrierefreien Badezimmerlösungen von Villeroy & Boch sind zeit- und kostensparende Teilrenovierungen schnell und unkompliziert realisiert. Stolperfalle Nummer eins ist die Badewanne. Daher ist es sinnvoll, die vorhandene Wanne gegen eine durchgängige, bodenebene Dusche auszutauschen. Die ultraflache, randlose Squaro Infinity von Villeroy & Boch ist für Renovierungs- und Modernisierungsprojekte ideal geeignet, da sie sich flexibel an die vorhandene Bausituation anpassen lässt und dank fünf aktueller Trendfarben farblich harmoniert. Die rechteckige Duschwanne verfügt über eine Ablaufabdeckung und sorgt mit der höchsten Rutschhemmung (Klasse C) für maximale Sicherheit.
Bodengleiche Duschen wie die Squaro Infinity von Villeroy & Boch minimieren Stolperfallen und Rutschgefahr in cleanem Design.
Die Squaro Infinity lässt sich in Größe und Farbgebung den persönlichen Vorlieben und der Einbausituation vor Ort anpassen.


Waschtische der Serie ViCare verfügen über integrierte Haltegriffe, die körperlich eingeschränkten Menschen Sicherheit geben. Sie können mit einem Rollstuhl problemlos unterfahren werden.
Optisch ansprechend: Die ebenerdige Duschlösung Squaro Infinity sowie Waschtische und Accessoires aus der ViCareSerie bilden barrierefreie, designstarke Wellnessoasen.












Die Medizin-Studenten


Niclas Wiebe und Linda Maschke haben das Projekt „Medi-Paten“ am Tübinger Universitätsklinikum initiiert. Seit kurzem ist die Mitgründerin selbst an Krebs erkrankt.

Zwei Tübinger


Ob Linda Maschke Medizin studiert, sollte sich auf einer Station des Uniklinikums entscheiden, dort, wo es um Kinderknochenmarktransplantation ging. Vor fünf Jahren war das, und die Entscheidung war schnell getroffen: Medizin war das Richtige für sie. Aber noch eine wichtige Erkenntnis nahm die heute 24-Jährige aus dieser Zeit ihres Bundesfreiwilligendienstes mit: Ihr fiel auf, dass den Kindern oft langweilig war. Kleine Kinder, mittelgroße Kinder, große Kinder, die alle teils eine ziemlich lange Zeit in der Klinik sein mussten.
KAMPF GEGEN LANGEWEILE
Als Jahre später Niclas Wiebe zufällig hörte, dass Linda Maschke schon mal in der Kinderonkologie gearbeitet hatte, schrieb er sie sofort an. Beide studieren in Tübingen Medizin, und Wiebe suchte Mitstreiter. Er wollte etwas fur Kinder tun, ein Projekt starten. Am besten fur krebskranke Kinder.
Denn ein einschneidendes Erlebnis aus seiner Kindheit prägte ihn, erzählt er: Fruher, zu Schulzeiten, sei er stark übergewichtig gewesen, auch schlecht in
der Schule. Dann nahm er teil an einem Zirkusprojekt seiner Schule und wurde letztlich 30 Kilogramm leichter. Die Erlöse des Zirkusprojekts wurden an krebskranke Kinder gespendet. So erklärt sich Niclas Wiebe die Verbundenheit zu Projekten, die Kindern helfen. Deshalb wollte er selbst eins initiieren. Jetzt sitzen Linda Maschke und Niclas Wiebe in der Cafeteria der Medizinischen Klinik und erzählen von ihrem Projekt „Medi-Paten“. Im Sommer 2022 lernten sich die beiden kennen. Ziemlich schnell war klar, dass sie ein
Patenprojekt aufbauen wollen für krebskranke Kinder. Medizinstudierende, die einmal in der Woche zu einem Kind in der Klinik gehen, um mit ihm zu spielen, zu basteln, vorzulesen, zu kochen. Im Oktober 2022 startete die Testphase, mittlerweile haben sich rund 100 Medizinstudierende in der WhatsApp-Gruppe als Paten gemeldet. Warum nur Medizinstudierende?„Weil es eine Masernimpfung gibt und eine Schweigepflichterklärung schon unterschrieben ist“, sagt Wiebe. Sonst wäre das ein zu großer organisatorischer Aufwand. Vom Tübinger Förderverein für krebskranke Kinder haben Maschke und Wiebe Hilfe bekommen. Auch von Prof. Michaela Döring, die Linda Maschke schon während ihres Bundesfreiwilligendienstes in Tübingen kennengelernt hat. Eine Mitarbeiterin des Fördervereins und ein Mitarbeiter des Psychoonkologischen Diensts haben Linda Maschke und Niclas Wiebe schließlich auf der onkologischen Station in der Kinderklinik bekannt gemacht, mit Pflegern, mit Eltern, mit Kin-
dern. Das machen Maschke und Wiebe mittlerweile mit den Paten. Sie schauen, welches Kind zu welchen Paten passen würde, nehmen Kontakt zu den Eltern auf, zeigen den Paten die Station, vermitteln den Kontakt zu Eltern.
INITIATORIN AN KREBS ERKRANKT
Um genau zu sein, macht das seit ein paar Monaten Niclas Wiebe allein. Dass die beiden in der Medizinischen Klinik von ihrem Projekt erzählen, hat nämlich einen Grund: Linda Maschke soll momentan nicht mehr in die Kinderklinik, zu groß sei dort die Infektionsgefahr. Für sie. Sie ist selber an Krebs erkrankt und wird in der Medizinischen Klinik behandelt. Im August dieses Jahres wurde bei ihr ein hochaggressives B-Zell-Lymphom diagnostiziert, sie musste sofort mit einer Chemotherapie anfangen. Es begann schon im Mai, vor sieben Monaten. Ihr war übel und sie hatte Rückenschmerzen. Der Orthopäde fand nichts, die Blutwerte beim Hausarzt waren perfekt und der Besuch bei einem Osteopathen brachte auch keine Linderung. Bis Anfang August quälte sie sich durch die Schmerzen, dann entdeckte man im Ultraschall, dass die rechte Niere extrem
gestaut war. „Der Tumor im Becken war schon so groß wie eine Cola-Dose“, sagt Linda Maschke. Er drückte auf die Harnleiter und staute so die Niere. Es sei schon komisch, sagt die junge Frau: Sie setzt sich für krebskranke Kinder ein, jobbte beim STEP-Register (Register für seltene Tumorerkrankungen in der Pädiatrie), in dem Daten zu seltenen Krebserkrankungen an der Kinderklinik des Uniklinikums Tübingen gesammelt werden, schreibt ihre Doktorarbeit über die Therapie von schwarzem Hautkrebs bei Kindern –und bekommt nun selbst Krebs.
Das Medi-Paten-Projekt wird trotzdem weitergehen. Es hat sich schon ein kleines Organisations-Team gebildet, das Niclas Wiebe bei der Arbeit unterstützt. Auch Linda Maschke macht, was ihr möglich ist, etwa den neuen InstagramAccount über die Medi-Paten. Es soll aber nicht nur weitergehen, sondern auch als Vorbild für andere Städte dienen: Am Kinderspital in Zürich war nicht nur der Chefarzt, sondern auch die Fachschaft von dem Konzept begeistert und die Medi-Paten starten im Dezember. Auch mit Freiburg und Homburg sind Wiebe und Maschke in Gesprächen.

Schon ein wenig Vorlesen oder ein Bilderbuch zusammen anschauen hilft den Kindern, die Langeweile im Krankenhaus etwas zu vertreiben.
Der neue Instagram-Kanal mit seinen Infos über die Medi-Paten heißt medipaten.tuebingen , einen weiteren Account hat Linda Maschke unter lindas.cancer.journey.
SPENDENKONTO: Förderverein für krebskranke Kinder Tübingen e.V./ Kreissparkasse Tübingen, IBAN: DE10 6415 0020 0000 1260 63 oder Volksbank in der Region eG IBAN: DE14 6039 1310 0547 3180 06
Niclas Wiebe ist in Horb geboren und hier bei seiner Mutter Bettina und mit seiner Schwester Olivia aufgewachsen. Er besuchte die Gutermann-Grundschule, war einige Jahre am Martin-GerbertGymnasium und wechselte dann auf die Realschule Horb. Sein Interesse an naturwissenschaftlichen Themen weckten die Lehrer an der Gewerblichen und Hauswirtschaftlichen Schule in Horb. Hier, am Technischen Gymnasium, das damals einen Umweltzug anbot, machte Niclas Wiebe sein Abitur. 2018 zog es ihn zum Physikstudium nach Zürich an die ETH, eine der renommiertesten Hochschulen der Welt. Hier studierte schon Albert Einstein.
Nachdem die Ärzte bei Niclas Wiebe eine spastische Spinalparalyse diagnostiziert hatten, eine seltene neurodegenerative Krankheit, entschied er sich, zusätzlich Medizin zu studieren. Weil das parallel zu Physik in Zürich nicht möglich war, wechselte er an die Universität Tübingen. Inzwischen studiert er im 9. Semester Medizin und will das Studium in zwei Jahren abschließen. „Das Physikstudium“, sagt er und schmunzelt, „zieht sich wohl noch ein bisschen.“
Als Doktorand ist er derzeit in der Kinderonkologie der Uniklinik Tübingen. Nachdem er im vergangenen Jahr ein großes Charity-Event für den Förderverein krebskranke Kinder Tübingen mit den Basketballern der „Tigers“ im „Crossfit“ organisiert hat, ist er offiziell deren Botschafter. ik
– „37° Leben“:


„Jung gegen Alt“ – Gen Z gegen Boomer: Die Alten wollen ihren Lebensabend genießen, junge Menschen fühlen sich um ihr Aufstiegsversprechen betrogen. Steigende Mieten und Immobilienpreise, Inflation, Klima- und Krisenherde trüben ihre Perspektiven. Wie können sich Jung und Alt den Herausforderungen gemeinsam stellen?
Reporter Ben Bode trifft zwei Menschen ihrer Generationen. Tischlerin und Influencerin Isabelle Vivianne, Jahrgang 1996, hat sich mit ihrer eigenen Werkstatt selbstständig gemacht. Ihr Credo: Die Boomer hätten zwar einiges geschafft, würden sich jetzt aber aus der Affäre ziehen und alles auf die Jungen abladen. Journalist und Jurist Daniel Goffart, Jahrgang 1961, betont hingegen, die Generation Z ruhe sich auf dem hart erarbeiteten Wohlstand aus und verliere sich in Scheindebatten über Gendern oder Geschlechtervielfalt.
Ben Bode (BB), der Moderator, erklärt: „Boomer gegen Gen Z – selten haben sich zwei Generationen härter attackiert. Und ihre Lebensrealitäten könnten unterschiedlicher kaum sein. Während die Alten ihren Lebensabend genießen wollen und so gar keine Lust auf Verzicht haben, fühlen sich die Jungen um ihr Aufstiegsversprechen betrogen. Denn: Horrende Mieten und Immobilienpreise, Inflation, Klima


und Krisenherde verunsichern sie mehr und mehr. Die Verantwortlichen für die Misere stehen für die Jungen fest: Die Boomer. Das ist die Generation der geburtenstarken Nachkriegsjahrgänge bis 1970. Verschwenderisch hätten sie auf Kosten zukünftiger Generation gewirtschaftet, um sich jetzt aus der Affäre zu ziehen. Umgekehrt werfen die Alten den Jungen vor, sich mit Scheinproblemen aufzuhalten und den hart erarbeiteten Wohlstand zu verprassen. Ich will herausfinden: Warum ticken Boomer und Zoomer so unterschiedlich und wie können sie wieder zueinanderfinden?“
Daniel Goffart (DG): „Ich habe in der Diskussion mit meinen Söhnen, aber auch mit jüngeren Leuten in meinem beruflichen Umfeld schon gemerkt, dass sich immer mehr Dinge verhaken, dass die Diskussionen schwieriger werden und dass es immer schwieriger wird, einen Punkt zu finden und, dass man sehr rasch zu einer Situation kommt, wo man total auf gegenseitiges Unverständnis stößt.“
Ben Bode trifft sich mit Daniel Goffart in Brüssel. Er hat ein Buch über den Generationenkonflikt geschrieben.
BB: „Du bist hier Korrespondent für die Wirtschafts-Woche in Brüssel, das ist ein Karrierehöhepunkt, oder?“
DG: „Das ist schon ein toller Job, Karrierehöhepunkt wäre vielleicht Chefredakteur,


das hat jetzt nicht geklappt, aber ich fühle mich hier sehr wohl. Ich war immer Korrespondent, mein Leben lang, in Bonn, in Berlin und jetzt in Brüssel und das ist ein toller Platz hier – ich finde es toll!“
BB: „Hat das Boomer-Qualitäten gebraucht, um dahinzukommen?“
DG: „Ich glaube schon, also Boomer-Qualität heißt ja ein bisschen, dass man lernt sich durchzusetzen, dass man doch ein gewisses Leistungsethos hat, dass man oft die Arbeit vor das Privatleben stellt. Ob das jetzt immer mit Boomern verbunden ist, mag dahingestellt sein. Aber man muss schon was tun, es kommt nicht von allein auf einen zu.“
BB: „Du hast ja ein Buch geschrieben über den Generationenkonflikt und nimmst da die Rolle des Boomers ein. Dann kannst du mir ja bestimmt sagen: Was macht so einen Boomer denn aus, was hat der für Qualitäten?“
DG: „Wir waren sehr viele, wir haben gelernt, uns durchzusetzen, weil wir immer in einer großen Masse aufgetreten sind. Wir sind, glaube ich, viel strenger erzogen worden, es gab auch weniger Nachsicht gegenüber dieser Generation von unseren Nachkriegseltern, die uns ja erzogen haben in dieser Zeit. Und ich glaube, wir haben auch ein anderes Leistungsethos und Arbeitsethos mit auf den Weg bekommen, mehr nach dem Motto ,Ich muss was

schaffen!‘, als ,ich achte mehr auf mich selbst‘. Also, diese Art des VorankommenWollens, des Durchkämpfens, das ist, glaube ich, in der Generation besonders stark im Gegensatz zu vielen jungen Leuten heute.“
BB: „Okay, das sind die Qualitäten der Boomer. Wie würdest du denn die Gen Z charakterisieren, was wirfst du denen vor?“
DG: „Sie haben halt eine andere Einstellung zu vielen Dingen und das ist teilweise auch gut so und wir Älteren können auch davon lernen. Aber es gibt auch Dinge, die, glaube ich, für viel Ärger sorgen, für viel Verdruss und auch für viel Frustration. Zum Beispiel diese Vorwurfshaltung, die es immer gibt gegenüber den Älteren. Wir sind ja an allem schuld, am Klimawandel, daran, dass wir die Atmosphäre verpesten, an der Ungerechtigkeit dieser Welt, an allem sind die Boomer schuld. Und das wird in einer oft heftigen, vorwurfsvollen Art geäußert und das ist etwas, was diesen Konflikt zwischen den Generationen befeuert.“
BB: „Was denkst du mit Blick auch auf unseren Wohlstand über die Gen Z?“
DG: „Also, ich glaube, dass die Bereitschaft zur Leistung, die Bereitschaft, die Dinge, die wir alle haben, als selbstverständlich wahrnehmen … auch zu erarbeiten. Es wird viel geredet über Verteilung, es wird viel geredet über globale Gerechtigkeit, es wird viel geredet über ,Man muss den Reichen mehr Steuern abnehmen‘, damit man mehr soziale Wohltaten finanzieren kann. Das kann man alles machen, aber ich glaube, mit der Einstellung, die man halt oft antrifft, nicht generell, aber oft antrifft, ist der Wohlstand, den wir haben, kaum zu halten. Also, ich überspitze mal: Mit einer 36-Stunden-Woche, bei vollem Lohnausgleich, mit früher in Rente, mit jedes zweite Jahr ein Sabbatical, wird das nicht funktionieren. Und letzten Endes haben die jungen Leute sich ja auch sehr gut eingerichtet mit dem Wohlstand, den sie vorgefunden haben, also den Wohlstand, den ihre Eltern erarbeitet haben, also die Boomer sozusagen.“
Ben Bode trifft stellvertretend für die Generation Z in Hamburg Isabelle. Die Tisch-
ler- und Influencerin baut sich gerade eine eigene Werkstatt auf, um sich selbstständig zu machen.
Isabelle Vivianne (IV): „Ich bin Tischlerin geworden, weil ich schon immer Design und Einrichtung und Möbelbau und Möbel generell favorisiert habe. Also, ich habe quasi Playmobil-Häuser einfach jedes Mal neu eingerichtet und wenn es dann fertig war, dann habe ich alles wieder rausgerichtet und neu eingerichtet, weil mir ging es nicht darum, zu spielen in dem Sinne.“
BB: „Sag mal, die Boomer, die werfen eurer Generation ja gerne vor so wählerisch und kompliziert zu sein und vielleicht auch nicht so leistungsbereit. Was würdest du dem entgegnen?“
IV: „Achtzig Prozent der jungen Menschen stellen sich die Frage nach der Sinnhaftigkeit der Arbeit. Das heißt, vielleicht bedeutet wählerisch in dem Kontext das Hinterfragen ,wieviel Sinn mach eigentlich dieser Job?‘. Und dann unter Umständen kann man sagen, dass die jungen Leute wählerisch sind, weil sie halt was möchten, was für sie persönlich eine Erfüllung bedeutet, was Sinnhaftigkeit im Kontext der Klimakrise bedeutet.“
BB: „Also, man könnte so ein bisschen polemisch formulieren: Deine Generation ist vielleicht nicht mehr bereit, sich für das große Ganze kaputtzumachen. Aber man kann sich auch fragen: Ist das vielleicht eine ganz gute Einstellung, dass man sagt, man macht sich nicht kaputt?“
IV: „Ja, aber was ist bedeutet jetzt ,sich für das große Ganze kaputtmachen?‘ Denn, das große Ganze, aus der heutigen Perspektive, ist der Klimawandel, ist die Sicherung unserer Grundressourcen in der Zukunft und dafür hat sich ja die BoomerGeneration nicht kaputtgemacht, weil sie ja proaktiv daran mitgewirkt hat, dass wir weniger Ressourcen haben, dass wir mehr CO2 ausstoßen.“
DG: „Ich mag immer so diese pauschalen Vorwürfe, die dann oft geäußert werden, nicht. Und diese pauschalen Lösungsvorschläge, die sind auch mittlerweile bisschen unterkomplex.“
IV: „Nichtsdestotrotz stehen wir vor Herausforderungen an der Stelle und die gilt es auch, ernst zu nehmen und zu sehen,
dass wir einfach andere Probleme und Thematiken haben, die uns beschäftigen, als die Generation davor.“
BB und IV zusammen in der Werkstatt: „Mein Vater findet das auch extrem gut, dass ich Handwerkerin geworden bin. (...) Er hätte nie damit gerechnet, dass bei drei Töchtern eine davon wirklich ins Handwerk geht. Und aus der Perspektive kann ich nur sagen, habe ich das familiär wahrscheinlich schon immer mitbekommen, mein Opa ist ja auch Malermeister.“
BB: „Du machst dich hier ja selbstständig. Wo hast du denn vorher gearbeitet?“
VI: „Ich habe vorher in Berlin gearbeitet bei einem Tischlermeister, der war halt supercool, superoffen. Er hatte auch verschiedene Modelle implementiert in seinem Betrieb, wie man arbeiten kann. Also es gab Leute, die eine 4-Tage-Woche gemacht haben, es gab Leute die Teilzeit und es gab Leute, die Vollzeit gearbeitet haben. Und er hat dadurch so ein neues Schichtmodell etabliert und das hat sehr, sehr gut funktioniert. Ja, das war eine schöne Zeit, die mir viel gegeben hat.“ Und sie erklärt wie sie vorher in zwei anderen Betrieben gelernt hat. Hier herrschte hierarchisches Denken, der Azubi schien nichts wert zu sein. Aber es wollten alle, dass sie die Ausbildung fertig macht. Und sie sagt weiter: „Die Boomer haben mich irgendwie abgelehnt, aber irgendwie auch nicht.“
DG: „Man merkt es auch am Arbeitsmarkt. Also, sie sind umworben wie selten eine Generation zuvor. Und deshalb sind sie auch natürlich mehr Aufmerksamkeit gewöhnt, mehr daran gewöhnt, dass man auf sie zugeht, dass man sich um sie kümmert. Ich glaube, das ist auch die Abgrenzung von Frustrationstoleranz. Also, wir haben natürlich mit den Enttäuschungen umgehen müssen, die damit verbunden sind, dass man immer einer von vielen war und eben nicht alles funktioniert hat – Jobs, Praktika, Studienplätze, der Wunsch und die Wahl des Studienortes, alle diese Dinge. Und der Umgang mit Enttäuschungen, mit Misserfolgen, hat uns dann auch im ganzen Berufsleben begleitet, weil da war es ja auch nicht besser. Auch da gab es natürlich mehr Wettbe-
werb. Und man lebte natürlich auch noch in einer Berufswelt, die von den Chefs, die damals am Ruder waren, als ich noch jung war, das waren noch Leute, die kamen teilweise aus der Kriegsgeneration. Und da herrschte oft ein militärischer Ton, da herrschte Befehl und Gehorsam, da wurde nicht diskutiert, sondern angeordnet.“

IV: „Ich glaube, dass nie gerechtfertigt war, mit irgendeinem jungen Menschen in irgendeiner Zeit oder Epoche schlecht umzugehen, der auf den Arbeitsmarkt kommt. Das sind Schützlinge, die muss man auch beschützen und da muss man sich einfach drum kümmern, dass die in einem guten Umfeld ihre ersten Arbeitserfahrungen machen und somit auch zu guten Fachkräften werden. Jetzt kommen wir aber wieder zu dem Punkt, dass gerade die BoomerGeneration sich ja die Medaille auflegt ,Wir haben so hart gearbeitet, dass ihr das besser habt!‘. Jetzt haben wir es besser an der Stelle, weil wir einen Arbeitnehmermarkt haben und diesen Respekt und diesen Umgang einfordern können und jetzt wird gesagt: So aber nicht! Und das sehe ich nicht ein!“
BB: „Gerade in Ballungszentren ist es heute kaum denkbar, als Alleinverdiener mit Familie über die Runden zu kommen oder sich gar Wohneigentum leisten zu können. Früher war das ganz normal, hatte aber auch seinen Preis.“ Mein Gefühl für mich selbst ist, ich will es irgendwie anders machen als das mein Vater noch gemacht hat, aber auch diese Generation, glaub ich, gemacht hat, weil der schon sehr mit seiner Arbeit verheiratet war und einfach nicht so wahnsinnig präsent. Wie war denn das bei dir, du hast auch ganz schön Karriere gemacht. Ich kann mir vorstellen, dass du deine Kinder auch nicht so viel gesehen hast, wie du das jetzt im Nachhinein wollen würdest?“
DG: „In der Nachschau ist das richtig, ja!
Aber es war halt so. Also, man ging arbeiten und wenn man was erreichen wollte, ging man halt viel arbeiten und man ging früh raus und kam abends spät zurück.
Ich war schon sehr viel unterwegs. Und meine Ex-Frau war Ärztin, das heißt, sie musste auch im Krankenhaus arbeiten,
Schichtdienste, auch Wochenenddienste. Wir mussten uns sehr stark organisieren, damit das mit den Kindern geklappt hat.“ IV: „Unsere Generation hat schon den großen Konflikt, dass sie in ihrer Kindheit selbst erlebt hat, dass Arbeit für emotionale nicht vorhandene Verfügbarkeit sorgt und auch für physische Abwesenheit. Und das bedeutet: Wir als Kinder haben oft erlebt, Mama und Papa sind nicht da, weil sie arbeiten müssen, sie sind weg. Und wenn sie da sind, sind sie gestresst, also emotional nicht anwesend. Und daraus kommt natürlich der Gedanke, weil meine Generation natürlich auch ein Gefühl hat für: Ich möchte, dass meine Kinder es irgendwann mal besser haben, dass sie jetzt sagen ,Ich möchte mehr da sein, ich möchte mehr Zeit mit meinen Kindern verbringen‘. Das ist total richtig und wird, glaube ich, gerade für die Fachkräfte der Zukunft viele junge Menschen hervorbringen, die ein gutes, stabiles Familienumfeld haben und somit auch einen guten, stabilen Stand in der Gesellschaft“.

BB: „Das ist natürlich auch bei mir so, dass das mit Einbußen einhergeht. Wenn ich irgendwie sage, ich mache Elternzeit, wenn ich sage, ich nehme mich auch zurück in der Arbeit. Das ist weniger Kohle und das ist im Zweifelsfall auch weniger Karriere. Aber ich für mich habe entschieden, ich glaube, ich will das eher so.“
DG: „Ja, das passt auch. Ich glaube, das ist eben genau das, was du sagst, eine andere Herangehensweise eine andere Abwägung. Man muss, glaube ich, wenn man Prioritäten setzt, was ich gut und sympathisch finde, auch in deinem Fall, aber man muss dann auch bereit sein, die Konsequenzen zu tragen.“

BB: „Kannst du denn verstehen, dass die Gen Z – und im Grunde die Generation Y auch schon – da andere Prioritäten setzt und sagt: ,Uns ist es irgendwie wichtiger mehr zu erleben, wie die Kinder aufwachsen?‘“
DG: „Absolut, ich kann das sehr gut verstehen und ich höre das auch von meinen Kindern, nach dem Motto: ,Papa, wenn wir mal Kinder haben, wir machen das anders‘. Und die sagen das ohne Frust oder ohne Wut auf mich, nach dem Motto: ,Du hast uns nicht gut genug behandelt, du hast uns vernachlässigt‘. Aber man merkt schon, dass sie andere Schwerpunkte in ihrem Leben setzten oder auch setzen wollen. Insofern kann ich das sehr gut verstehen. Ich finde es auch ein gutes Ziel! Also wenn man sagt, man will sich mehr um seine Familie kümmern, dann ist das erstmal total positiv. Aber wir wissen beide, mehr zuhause sein, weniger arbeiten, heißt unter Umständen auch, weniger Geld zu verdienen, weniger Karriere machen. Du weißt das wahrscheinlich auch, du bist auch ein junger Vater. Also, das hat auch Auswirkungen! Und das muss man dann auch akzeptieren.“
IV: „Grundsätzlich ist mir ein vernünftiger Ausgleich zwischen Arbeitsleben und Privatleben wichtig, weil das meine mentale Gesundheit fördert. Und deswegen versuche ich schon darauf zu achten genug Rückzugszeit zu haben, in der ich Zeit mit meiner Familie, mit Freunden, verbringe, um dann eben wieder komplett mit Energie an die Arbeit zu gehen und da 120 Prozent zu leisten.“
BB: „Sag mal, deine Selbstständigkeit, könntest du das machen, ohne dass du unterstützt wirst, zum Beispiel von deinem Vater?“
IV: „Ich denke, eine Unterstützung von der Familie heraus ist superwichtig. (...) Viel wichtiger ist aber, dass ich die ganze Ausbildung wahrscheinlich nicht ohne die Unterstützung meiner Eltern geschafft hätte, weil ich habe nur 450 Euro verdient, habe aber schon in einer WG gewohnt und das in Hamburg. Das hat gerade mal gereicht für die Miete. Und dann müssen ja noch die Warmkosten bezahlt werden und Essen. Das heißt, da war es auf jeden Fall superwichtig, unterstützt zu werden.“
BB: „Kannst du verstehen, wenn dann Boomer manchmal sagen: ,Guck mal, eure Generation – ihr seid doch eigentlich ziemlich behütet aufgewachsen. Also, ihr habt doch ganz schön auch geschöpft aus dem Wohlstand, den wir aufgebaut haben?‘ Verstehst du das, dass die das auch unfair empfinden, wenn ihr so hart mit denen ins Gericht geht?“
IV: „Naja, jede Wahrheit ist immer irgendwo hart. Und das, was die Generation Z vorhält ist, dass im Endeffekt nicht alle Probleme gelöst sind und, dass wir nicht im Wohlstand leben. Denn wir werden in 20 Jahren kein sauberes Trinkwasser mehr für alle Menschen auf dem Planeten haben, währenddessen wird an der Börse schon auf Wasser spekuliert. Dann geht die Gradzahl des Planeten immer weiter hoch. Das bedeutet Klimaregionen: Wo ist es überhaupt noch möglich zu leben, weil es woanders zu heiß ist. Und das ist unsere Realität, das sind die Probleme, mit denen wir uns auseinandersetzen müssen. Ich finde es superwichtig, dass die ältere Generation, die Boomer, sich immer noch als unsere Eltern und unsere Großeltern sieht und uns auch so wahrnimmt. Ich glaube, dass ist das, was ich mir wünschen würde. Und nicht als so einen abgespacte Gruppe von Menschen, sondern wir sind literally eure Kinder und Enkelkinder und es wäre halt superschön, wenn ihr uns an die Hand nehmen könntet, uns Verständnis gegenüber bringen könntet und vielleicht auch manchmal Ängste ernst nehmen. Also, dieses ständige beruhigen … Du sitzt gerade gefühlt in einem brennenden Haus und jemand kommt zu dir und sagt so: ,Das wird schon alles wieder‘. Das kannst du mir doch nicht erzählen, ich bin ja nicht dumm, sondern wir wissen ja schon, dass wir hier Probleme haben! Und dann wäre es manchmal schön, einfach erwachsene Menschen zu haben, die superviel Lebenserfahrung haben, die superwichtige Jobs haben, die dann einfach sich hinstellen und sagen: Wir sehen euch, wir nehmen das Problem genauso ernst und uns irgendwie so abholen. Das würde ich mir wünschen.“
DG: „Also, es gibt natürlich schon in der Diskussion mit meinen Kindern, die eben beide unter 30 sind, also noch die jüngere Generation sind, schon Dinge, die mich sehr ins Nachdenken bringen. Eine Sache, die mich sehr berührt hat, war mal eine Diskussion mit meinem älteren Sohn, der dann sagte: ,Papa, guck mal, du bist schon überall gewesen, du hast zum Beispiel mal am Great Barrier Reef diese tollen Korallenriffe gesehen. Und die gibt es nicht mehr, die sind weg. Diese ganzen Korallen sind gestorben
im Klimawandel.‘ Und das sind dann Dinge, ja, das berührt mich sehr.“
BB: „Ich stehe jetzt hier im schönen Berlin gemeinsam mit Isabelle und Daniel. Ihr beide habt mir ja schon vermittelt, dass ihr als unterschiedliche Generation doch deutlich unterschiedliche Standpunkte habt. Aber es gab auch Gemeinsamkeiten. Bei dir habe ich zum Beispiel rausgehört, dass sich das Gespräch mit deinem Sohn ob des Korallenriffs, sehr berührt hat und, dass du da auch bereit wärst, Zugeständnisse zu machen. Welche wären das denn?“
DG: „Also, ich glaube, wir Alten sollten generell mehr zuhören und uns nicht in unserer jahrelang aufgebauten Selbstgewissheit sonnen, sondern mehr auf die jungen Leute zugehen und ernst nehmen, was sie sagen. Auch wenn uns manches vielleicht ein bisschen unplausibel vorkommt oder übertrieben. Sondern, das einfach mal auf uns wirken lassen, was da an Ängsten, Gefühlen und Sorgen rüberkommt. Und wenn wir uns darauf mehr einlassen, glaube ich, dann gibt es auch einen Weg zu einem besseren Verständnis miteinander.“
BB: „Isabelle, du bist zum Teil ganz schön hart mit den Boomern ins Gericht gegangen. Könntest du dir, wenn du das jetzt so hörst – diesen Schritt auf euch zu, auch vorstellen, da jetzt ein bisschen milder ranzugehen? Was wäre vielleicht ein Zugeständnis, was ihr machen könntet?“
IV: „Ich habe sowieso gar kein Problem damit, Kompromisse zu finden und deswegen stehe ich auch hier. Mir ist ein Austausch zwischen den Generationen sehr, sehr wichtig, denn ich bin der felsenfesten Überzeugung, dass wir am Ende lernen müssen, dass uns das Wissen weitergegeben werden muss, dass wir gut zuhören müssen, dass wir aber eben auch den Raum brauchen, um unsere Gedanken miteinzubringen. Weil wir am Ende nicht nur die nächste Generation sind, sondern auch die Zukunft mitformen und mitgestalten. Und deswegen ist unsere Perspektive eine sehr wichtige, die mit einbezogen werden sollte.“
BB: „Was ich total schön fand, was bei euch beiden rausgekommen ist – eigentlich, dass die Brücke, die wir schlagen können, schon da ist. Wir sind ja alle in Beziehun-
gen zueinander. Du mit deinem Sohn und du hast auch gesagt, vielleicht müssen wir wieder mehr sehen, dass die Boomer nicht irgendwelche anderen Aliens sind, sondern unsere Eltern und Großeltern. Und eigentlich sollten wir alle uns doch gegenseitig so viel wert sein, dass wir aufeinander zugehen und diesen Konflikt überwinden.“
IV: „Ja, zu hundert Prozent! Meine Großeltern haben sich, glaube ich, insbesondere dadurch, dass sie sieben Enkelkinder haben, sehr geöffnet und viele ihrer Weltanschauungen doch nochmal modernisiert. Und genau das passiert eben, wenn man als Generationen im Austausch steht und nicht die ganze Zeit den Finger aufeinander zeigt und versucht, die Schuld zuzuweisen, sondern Probleme adressiert, thematisiert und ihnen dann eben lösungsorientiert begegnet.“
DG: „Es ist ja auch nicht nur innerhalb der Familie, wir begegnen uns ja auch bei der Arbeit. Also, bei mir in der Redaktion der Wirtschaftswoche, da arbeiten vier Generationen, wenn man auch die Volontäre und die ganz jungen Leute dazuzählt, bis zu den Leuten wie ich, die jetzt nur noch ein paar Jahre haben bis zu Pensionierung. Und diese vier Generationen müssen ja miteinander arbeiten. Und das sind verschiedene Stile, verschiedene Ansichten, auch verschiedene Erfahrungen. Aber wir können uns ja nicht die ganze Zeit darüber unterhalten, was uns trennt, sondern müssen auch schauen, dass wir jede Woche ein Produkt hinstellen oder jede Woche in einem Betrieb arbeiten und da auch erfolgreich sind. Sonst funktioniert es auch einfach nicht.“ BB erläutert nun abschließend als Fazit: „Generationenkonflikte sind nichts Neues. Schon immer haben die Alten die Jungen für respektlos gehalten und sich gefragt, was aus denen mal werden soll. Und schon immer war es die Jugend, die auf Veränderung gedrängt hat. Mein Zusammentreffen mit Isabelle und Daniel macht mir aber Hoffnung, dass Jung und Alt das gemeinsam packen können.“


Diese Sendung kann in der ZDF-Mediathek jederzeit angeschaut werden.
Die Vorarlberger Landeshauptstadt ist das ganze Jahr hindurch ein wahrer Besuchermagnet. Im Winter versprühen die Bregenzer Weihnacht und die Lindauer Hafenweihnacht einen besonderen nostalgischen Charme.

Schwimmende Brücke: Die festlich geschmückte MS Austria bringt die Besucher von der Bregenzer Weihnacht über den Bodensee bis zur Lindauer Hafenweihnacht.



Verlockende Düfte, funkelnde Lichter, weihnachtliche Klänge und einladende, nostalgische Hütten –schöner kann das Warten auf das Christkind kaum sein.
Plätzchen, Lebkuchen und Glühwein verströmen ihren köstlichen Duft, zarte Schneeflocken wirbeln durch die Luft und funkelnde Lichter spiegeln sich auf dem Wasser – die Winterzeit am Bodensee versprüht ein unverwechselbares Flair. Dass hier das Warten auf das Christkind besonders leichtfällt und ein Weihnachtsmarkt so viel mehr sein kann als bloßer „Standard“, beweist die Vorarlberger Landeshauptstadt Bregenz.
Ende des Jahres verwandelt sich Bregenz in ein Weihnachtsparadies.





Mit der traditionellen Illuminierung des Christbaums am Leutbühel wird die Bregenzer Weihnacht eröffnet: Im Zentrum der Stadt präsentiert sich der Kornmarktplatz mit einladenden Hütten, verführerischen Aromen und tanzenden Lichterketten in nostalgischem Weihnachtsgewand. In der Oberstadt mit ihren mittelalterlichen, ge-
schichtsträchtigen Gebäuden erwartet die Weihnachtsbummler eine besondere Attraktion: das urige Kunst- und Handwerksmärktle am Fuße des Martinsturms. Künstler stellen vor den Augen der Zuschauer Schmuck, Skulpturen, Kleidung und andere handgemachte Kunstwerke her. Das bunte Kinderprogramm mit Eislaufen, Ponyreiten und Karussellfahren umfasst auch einen Besuch im Nikolaus-Haus, wo spannende Weihnachtsgeschichten für leuchtende Augen sorgen. Anschließend genießen Besucher auf der festlich geschmückten MS Austria eine romantische Fahrt über den Bodensee und können in behaglicher Atmosphäre nicht nur eine Krippenausstellung an Bord, sondern auch das eindrucksvolle Lichtermeer des weihnachtlichen Trubels an Land bewundern. Nach einer kurzen Überfahrt legt das Schiff direkt am Tor zur Lindauer Hafenweihnacht an, wo verschiedene Showeinlagen und ein zauberhafter Märchenwald samt musikalischer Untermalung locken. Und auch nach dem Fest geht es besinnlich weiter, denn bis zum 6. Januar hält der Kinderzauber am Leutbühel mit Karussell, Märchenbox, lebender Krippe und kulinarischen Verwöhn-Momenten Überraschungen für Groß und Klein bereit. Infos unter www.bregenz.travel.
Alles Glück dieser Erde liegt auf dem Rücken der Pferde“ – es gibt wohl kaum ein Sprichwort, das unter Reitern und Reiterinnen beliebter ist. Doch um glücklich zu sein, müssen Pferdeliebhabende nicht immer aufsteigen. Manchmal reicht auch ein Ausflug in den Osten Baden-Württembergs: Im Rahmen des „Kalten Markts“ verwandelt sich die Stadt Ellwangen vom 10. bis 15. Januar 2025 in ein Pferdeparadies der Extraklasse.
Wer beim Pferdeschaulaufen überzeugt, wird zur schönsten Stute gekürt.

Der große Festumzug belebt die historische Innenstadt.




Die Bürgergarde in historischen Kostümen führt den Festumzug an.




















Eleusippus, Meleusippus und Speusippus - Pferdefreunden sind die Namen der heiligen Drillinge bekannt. Ein Großteil der Reliquien der „Pferdeheiligen“ liegt seit über 1250 Jahren im ehemaligen Kloster Ellwangen und ohne sie würde es den „Kalten Markt“ nicht geben. Vermutlich seit dem 9. Jahrhundert gedenken Menschen ihnen im Januar in Form von Messe und Markt. Auch heute noch startet der „Kalte Markt“ offiziell mit der Reitermesse in der romanischen Basilika St. Vitus, bei der den heiligen Drillingen gedacht wird. Mehr als 300 herausgeputzte Pferde und Gespanne, gepaart mit der Bürgergarde in historischen Kostümen und Musikkapellen, verleihen Ellwangen am Montag ein festliches Ambiente. Ab 14 Uhr zieht der große Festumzug durch die historische Innenstadt und gibt den Blick frei auf stolze Araber,






Die Reitermesse in der Basilika St. Vitus findet traditionell am Sonntag nach Dreikönig statt.





wollige Isländer oder kleine Shettys mit originellen Zopfknotenfrisuren. Wer es an dem Tag früh aus dem Bett schafft, kann morgens zudem den Auftrieb der Pferde beobachten und live erleben, welche Stute die Jury zur schönsten wählt. Kutteln gehören zum „Kalten Markt“ genauso wie die zahlreichen Pferde. Ob in einem der gemütlichen Wirtshäuser, auf dem großen Krämer- und Ökomarkt oder beim verkaufsoffenen Sonntag: Die regionale Fleischspezialität kann an vielen Orten probiert werden. Der verkaufsoffene Sonntag bietet weiteres Highlight: Eisskulpturen-Schnitzen – live in der Fußgängerzone! Programm und Infos: www.ellwangen-tourismus.de.
Auch Amateure dürfen sich im Eis-Schnitzen versuchen.




Das Dreigespann: Magdalena, Karl-Heinz und »Rambo« auf dem Residenzplatz in Bamberg.




Der liebe Gott scheint da oben Kübel auszuleeren. Wolkenbruch. August. Und in Bernstadt (Alb-DonauKreis) tuckern gut gelaunt Karl Heinz Bender, 66, und seine Magdalena, 67, daher. Auf »Rambo«, einem mit bunten Plastikblumen geschmückten Bulldog.

Auf „Rambo“, einem mit bunten Plastikblumen geschmückten Bulldog. Magdalena Neubauer erzählt lachend: „Das muss sein, schließlich steht man ja im Mittelpunkt. Und ist auch ein Verkehrshindernis. Man muss ein Hingucker sein!“ Sie selbst hat die Lippen perfekt geschminkt, trägt Sonnenhut und Regenponcho. Denn weil „Rambo“ oben ohne ist, sind sie es auch. „Rambo“ ist der älteste der Dreien, ein selbst restaurierter „Eicher“, mit knapp 70. Er hat auch keine Lenkunterstützung: „Da ist noch Muskelkraft gefragt“, sagt der stolze Fahrer. Magdalena Neubauer sitzt auf „Rambos“ linker Seite. Rechts ist ein Rucksack befestigt, an seinem Hintern ein Metallund ein alter Lederkoffer. „Unser Kofferraum“, sagt die Frisörin. „Da ist auch mein Beautycase drin, mit Föhn, Haarspray, Bürste, Schminke.“
An diesem Morgen ist das Paar auf der Alb gestartet, daheim, in Heubach bei Heidenheim. Das Ziel: Meran, im Vinschgau - Bella Italia! Am Abend sollen sie für ihr Nachtquartier in Oberelchingen bei Ulm eintreffen (Sie werden dann nass sein, bis - unter - die Unterhose). Eigentlich nur 55 Kilometer, aber wer mit „Rambo“ unterwegs ist, braucht Zeit. Sein Name täuscht darüber hinweg, dass er nur 16 PS auf die Straße bringt. Karl Heinz Bender schiebt nach: „Bergab schafft er ja manchmal 19 oder sogar 20 Kilometer pro Stunde.“

Entschleunigtes Reisen auf Nebenstrecken.
Die Tour ist vier Jahre her. Mit dem Bernstadter Regenintermezzo haben damals Karl Heinz Bender, der mehr als 35 Jahre lang Reisebusfahrer gewesen ist, und Magdalena Neubauer, die selbstständige Frisörin, bewiesen: Echte Abenteurer sind


Fernpass und „Reschen“ - sind sie in Meran eingefahren. Und zwar: den Kopf voller Eindrücke vom Wegesrand. „Man sieht in jeden Garten, die Leute, im Umkreis von zehn Metern jeden Käfer, jeden Schmetterling“, sagt Magdalena Neubauer. Karl Heinz Bender ergänzt: „Als Reisebusfahrer bin ich jedes Jahr bis zu fünf Mal nach Südtirol gefahren, aber mit dem Traktor war es ganz anders. Ständig sagten wir: Hast du das gesehen? Hast du dies gesehen? Magdalena hat zum Beispiel eine Burgruine entdeckt, an der bin ich schon x Mal vorbei gefahren. Jetzt habe ich sie zum ersten Mal wahrgenom-

men.“ Er lacht und stimmt ein Loblied aufs entschleunigte Reisen an. Gerade heutzutage sei das etwas Besonderes, weil jeder nur immer schnell ans Ziel kommen will und von dem auch wieder schnell zurück. Ist das Erholung? Bei den beiden Heubachern ist, so abgedroschen es klingen mag, der Weg das Ziel. Das macht für sie Reisen aus. Dabei hilft einem die Langsamkeit. Bender: „Wenn dich dann Radler überholen, weißt du: Du bist wirklich langsam!“ Was für eine Auszeichnung. Für das Paar war es immer ein Traum, in der Rente gemütlicher zu reisen. Gemütlich … Sprich: Auf einem langsamen Oldtimer-Traktor, den sich Karl Heinz Bender zur Rente angeschafft und selbst restauriert hat. Dieser „Rambo“ hat neben Südtirol auch noch andere Ecken erlebt. Die Jungfernfahrt ging an Saar, Mosel und Rhein. „Rambo“ hat das Deutsche Eck in Koblenz gesehen. Bevor
Volkach nahmen sie mit. Über Würzburg und Karlstadt ging es nun ins Liebliche Taubertal. Der Fluss Kocher begleitete das Paar zur Hohenloher Hochebene und zum Schloss Langenburg.
Die Donauquelle.

Insgesamt seien die Leute auf den Straßen während ihrer Reisen entspannt gewesen. Auf der Reise nach Südtirol zum Beispiel hätten manche lachend gehupt, gewunken, den Daumen hoch gehalten. Magdalena Neubauer: „Uns haben Autos überholt, die in der nächsten Parkbucht hielten, um uns zu fotografieren oder für gemeinsame Selfies. Oder, um mit uns zu reden.“ Woher das Traktorpaar
er entlang des Neckars wieder ein Stück in den Süden fuhr. Ein andermal startete die Reise an der Donauquelle und das Dreiergespann begleitete die Donau bis Neuburg an der Donau in Oberbayern. Manchmal wichen sie mit ihm auf den Radweg aus, um in Donaunähe zu bleiben. „Aber wir waren guter Dinge, nicht erwischt zu werden“, erzählt Magdalena Neubauer. Über Riedlingen ging es vorbei an den Klöstern Zwiefaltern, Ober- und Untermarchtal und Wiblingen bis nach Ulm. Dann folgten auf bayerischer Seite: Günzburg, Dillingen, Höchstädt, Donauwörth und Neuburg. Im Jahr drauf führte die Route weiter die flussabwärts zum Kloster Weltenburg, wo sich die Donau imposant durch die Felsen bricht, und vorbei an der Befreiungshalle, hoch über der Donau thronend, bis zur Mündung der Altmühl. Weiter nun auf der Straße der Kaiser und Könige und entlang des Ludwig-MainDonau-Kanals. Auf der Strecke: Burgen und hübsche Städte. Über die fränkischen Städte Nürnberg, Forchheim und Bamberg lotste sie der Main nach Hassfurt. Auch den Blick über die Mainschleife bei
komme, wohin es wolle - wieso, weshalb, warum… Hochzeitsreise? Jubiläumstour? Karl Heinz Bender war im Laufe seines Berufslebens mit dem Bus in ganz Europa. Bis in Sankt Petersburg. „Jetzt aber haben wir nicht auf die Uhr geschaut, sondern waren einfach nach dem Prinzip unterwegs: Komme ich heut’ nicht, komm’ ich morgen.“ Der einzige Taktgeber: Wetter und Laune. Dabei nutzten sie keine Autobahnen sondern Nebenstrecken. Ohne Navi. Magdalena Neubauer: „Karl Heinz hat immer schöne Strecken herausgesucht. Er ist ja auf der Straße daheim. Deshalb war das für mich auch Vertrauenssache. Bei jedem tät ich mich nicht auf den Traktor setzen.“ Und er selbst sagt lachend: „Wenn meine Frau mir die Augen verbunden hätte, wären wir auch angekommen.“ So oft ist er schon nach Südtirol gefahren. Die ausführliche Reisebeschreibung gab es natürlich stets dazu. Und Magdalena Neubauer weiß jetzt: Kaum ein Hotel, an dem sie vorbei gefahren sind, in dem ihr Karl Heinz noch nicht übernachtet hat. Zurück dauerte die Fahrt dann nochmal ähnlich lang. Allerdings ging es diesmal

über den Südtiroler Jaufenpass hinüber nach Sterzing, dann weiter über den Brenner nach Innsbruck hinein ins Inntal. Dort suchte Karl Heinz Bender den Zirler Berg aus, um die Alpen zu überwinden. Teils 18 Prozent Steigung. Oha! Es herrschte viel Reiseverkehr und der Traktor musste ständig anfahren und bremsen. Karl Heinz Bender: „Bis erst „Rambo“ streikte (er rauchte) - und dann meine Frau.“ Also machten sie nach ein paar Kehren kehrt und fuhren eine Alternativroute. Eine demokratische Entscheidung. Zwei gegen einen. Übrigens: Einmal baute auf der Reise gerade ein Polizist eine Radarfalle auf. Karl Heinz Bender: „Da haben wir dann richtig Gas gegeben. Der Polizist hat uns noch angefeuert und ,schneller, schneller’ gerufen.“ Mit seinem Bus sei er nie von einem Polizisten angefeuert worden, Vollgas in eine Radarfalle hineinzufahren. Selbst für die Polizei war „Rambo“ zu langsam - für die Benders dagegen: genau richtig. Nach 935 Kilometern auf dem Tacho und 65 Stunden auf dem Traktor waren sie schließlich wieder zurück in ihrer Heimat. In Heubach auf der nicht ganz so steilen Ostalb.


Glücklich am Ziel angekommen: Beim Wahrzeichen des Vinschgau – der versunkene Kirchturm (von 1357) im Reschensee, in der Nähe des Reschenpasses.








WAS BRAUCHT MAN DAFÜR?


Kerzenlicht sorgt in jeder Jahreszeit für eine angenehme Atmosphäre. Zusammen mit einem dekorativen Windlicht in fröhlichen Farben und zeitlosen Motiven zaubert Kerzenschein in den Abendstunden ein dezentes Licht, das perfekt zur winterlichen Stimmung passt. Mit ein wenig Kreativität wird das selbst gestaltete Windlicht zum Hingucker.



Für die Windlichtform werden braunes Tonpapier, Transparentpapier, Kleber und eine Schere benötigt. Wer sich gestalterisch und farbig austoben möchte, sollte zudem passende Stifte parat haben. Zur Gestaltung mit ästhetischen Schriftzügen und schön geschwungenen Buchstaben eignet sich beispielsweise der Kalligrafie-Füller Parallel Pen von Pilot. Er ist für Kalligrafie-Anfänger genauso geeignet wie für Könner. Um dezente und frische Details auf die Windlichter zu zaubern, ist unter anderem der Druckbuntstift Color Eno von Pilot ideal. Der Druckbuntstift ist eine Alternative zum klassischen Holzbuntstift und besonders für Jugendliche und Erwachsene geeignet. Mit seinen feinen Minen lassen sich individuelle Details gestalten. Zudem sind alle acht erhältlichen Farben nachfüllbar, was den Stift besonders beliebt macht.
Schritt 1: Das Windlicht braucht im unteren Teil einen stabilen Rand, damit es nicht so leicht umfällt. Dafür wird aus dem braunen Tonpapier ein breiter Streifen geschnitten. Der Streifen muss lang genug sein, um als Kreis zusammengelegt die Kerze einmal ganz zu umschließen.
Schritt 2: Das Transparentpapier wird auf die gleiche Länge wie der Tonpapierstreifen geschnitten und am Rand festgeklebt.
Schritt 3: Nun lässt sich die Hülle des Windlichts bemalen. Mit dem Color-Eno-Druckbuntstift gelingen Blumen, Schmetterlinge
oder auch weihnachtliche Motive besonders gut. Vorzeichnen ist nicht nötig: Der Stift ist wie andere Buntstifte radierbar. Mit dem Kalligrafie-Füller werden die kunstvollen Buchstaben kreiert.
Schritt 4: Zum Schluss einfach beide Enden des Transparentpapiers zusammenkleben und fertig ist das individuelle Windlicht. Kerze hineinstellen, anzünden und angenehmen Kerzenschein genießen.












Mit dekorativen Schleifenbändern lassen sich zum Beispiel Foto-Grußkarten stilvoll in Szene setzen.
Fotosticker lassen sich auf eine Holzscheibe kleben und mit einer Schnur an einem Tannenstrauß befestigen.




















So werden aus schlichten Taschen zuckersüße Accessoires

Ob als Einkaufstasche, als Geschenk oder zum Verpacken: Stoff- und Jutebeutel können vielfältig genutzt werden und sind als Zeichen nachhaltigen Handelns bei immer mehr Menschen beliebt. Mit ein bisschen Kreativität und den richtigen Stiften lassen Stoffbeutel sich ganz einfach zu individuellen Accessoires in stimmungsvoller Weihnachtsoptik verwandeln.
DAS BENÖTIGTE MATERIAL:

Für die weihnachtlichen Beutel mit Zuckerstangen-Motiven braucht es nicht viel: Eine helle Stofftasche, ein Stück Pappe zum Unterlegen und passende Stifte zum Bemalen. Hierfür eignen sich beispielsweise die Pintor-Marker von Pilot besonders gut. Denn die Kreativmarker halten auf verschiedenen Oberflächen und sind mit ihrer robusten Spitze die perfekte Wahl für kreative Deko auf Stoffen wie Leinen, Baumwolle oder Jeans. Auch farblich ist für jede Idee gesorgt: Die Marker gibt es in 30 verschiedenen Farben - von weihnachtlich-klassischen Farbtönen wie Rot, Grün und Gold bis zu Trendfarben in pastell-, metallic- sowie Neonfarben.
Individuell gestaltete Jutebeutel sind vielseitig einsetzbar.


















Eine Pappe im Beutel verhindert das Durchdrücken der Farbe.

UND SO GEHT’S:























Mit einer Schablone werden alle Zuckerstangen gleich groß.






















Schritt 1: Zunächst wir d das gewünschte Weihnachtsmotiv auf Pappe vorgezeichnet und als Schablone ausgeschnitten. Am besten eignen sich einfache Formen wie Sterne, Tannenbäume oder Zuckerstangen, aber der Kreativität sind keine Grenzen gesetzt.
Schritt 2: Damit beim Bemalen die Farbe nicht auf der Rückseite des Beutels durchdrückt, wird nun ein großes Stück Pappe in den Beutel gelegt.

Schritt 3: Jetzt wird die Schablone auf die gewünschten Stellen platziert und die Umrisse des weihnachtlichen Motivs direkt auf den Beutel gemalt. Die Zuckerstangen können zum Beispiel mit einem roten Pintor in Strichstärke F oder M umrandet und ausgemalt werden, die Farbe trocknet schnell und deckt gut ab. So verschmiert nichts und mehrmaliges Nachmalen ist nicht nötig.
Schritt 4: Um die Kreation dauerhaft zu fixieren, wird der Beutel nach dem Trocknen der Farbe auf links gedreht und die Motive werden mit viel Dampf eingebügelt. Fertig!
Der stilvolle, weihnachtliche Beutel kann selbst ein Geschenk sein oder die Weihnachtsgeschenke nachhaltig verpacken.
Die Vorweihnachtszeit lässt kreative Herzen höherschlagen.
Die Dekoration der eigenen vier Wände sorgt für festliche Stimmung, außerdem werden viele Karten geschrieben und Präsente gestaltet. Persönliche Schnappschüsse schaffen dabei eine individuelle Note. Wer sich für die Weihnachtspost Inspirationen wünscht, findet etwa unter www.cewe.de zahlreiche Designs sowie Vorschläge für kurze, humorvolle oder besinnliche Festtagsgrüße. Für einen festlichen Blickfang im Zuhause sorgen individuelle Fotoanhänger. Dazu einfach Herzensmomente als runde Fotosticker zum Beispiel an einer der über 4.000 Fotostationen von Cewe ausdrucken, auf eine Holzscheibe kleben und mit einer Schnur an einem Tannenstrauß oder am Weihnachtsbaum befestigen – fertig ist der originelle Eyecatcher für den Advent.
Weihnachtskarten mit herausnehmbaren Fotos .














Styropor eignet sich ideal, um z.B. eigene Weihnachts- oder Blumenkugeln zu basteln. Hierfür braucht man Styroporkugeln in der gewünschten Größe, Schnur und kleine Deko-Stücke wie Sterne, Glitzersteine, Pailletten oder Blümchen.
Die Deko-Stücke lassen sich beispielsweise mit der Kids-Klebepistole von Steinel einfach auf der Styroporkugel festkleben. Dank der niedrigen Kleber-Temperatur und dem ergonomischen Griff können auch Kinderhände problemlos und sicher damit arbeiten. Am Ende etwas Platz lassen, um ein Stück Schnur zu befestigen. Einen Knoten machen und schon können die individuellen Weihnachtskugeln an den Baum gehängt werden. Wer nicht die gesamte Kugel mit Deko-Stücken versehen möchte, kann mit der Klebepistole anderweitig kreativ werden: Neben den neutralen Cristal-Sticks gibt es auch bunte und glitzernde Klebesticks für fantasievolle Bastelideen.
Individuell gestaltete Kugeln verzaubern jeden Weihnachtsbaum.



Gemeinsamer Bastelspaß: BlumenDeko für den Tisch.







Für die Blumenkugel befestigt man eine Kordel und Deko-Blumen auf einer halben Kugel Styropor. Für individuelle Weihnachtskugeln, die jeden Weihnachtsbaum verzaubern, klebt man Deko-Stücke wie Sterne oder Blümchen auf eine kleine Styroporkugel. Auf der letzten freien Fläche ein Stück Schnur befestigen – fertig ist ein Weihnachtsgeschenk.
Mehr Infos unter www.steinel-tools.de, UVP 13,99 Euro

















Eine oft gestellte Frage in Familien ist: „Was machen wir heute gemeinsam?“ Der Sohn möchte spielen, die Tochter malen. Alle Wünsche werden bei Spielen mit Würfelstiften erfüllt, also eckige Buntstifte – auf der einen Seite eine Mine und auf der anderen ein Würfel. Zum Gewinnen braucht man sowohl die richtige Strategie als auch ein Quäntchen Glück. Je nach Schwierigkeitslevel werden die Spielbögen an alle Mitspielenden verteilt. Wer am Zug ist, nimmt alle fünf Stifte, würfelt sie in die Tischmitte und sucht sich einen davon aus. Danach wählt die nächste Person einen Stift, bis alle einen haben. Die Symbole auf der oberen Seite des Stiftes geben an, wie viele Kästchen auf dem Spielbogen mit der ausgewählten Farbe ausgemalt werden müssen.
Bei der Edition „Gärten“ versuchen die Spielenden, durch cleveres Ausmalen Gärten und Bonusziele zu erreichen. Bei der Variante „Riffe“ muss man durch ausgeklügelte Routen Schätze zu bergen, Münzen einzusammeln und ebenfalls Bonusziele zu erreichen. Bei der Edition „Schatzkammern“ versuchen alle, durch cleveres Ausmalen in jeder Reihe und jeder Spalte Bonusziele zu erreichen und mit Farbgruppen zu punkten. Wer am Ende die meisten Punkte hat, gewinnt. Alle Varianten unter www.amigo-spiele.de.
Herausgeber: Amigo-Spieleverlag, Spiel für die ganze Familie ab 8 Jahren , 2 – 4 Spieler, UVP 12,99 Euro

Spielefans können ihr strategisches Denken an den eckigen Buntstiften unter Beweis stellen.















Zieht da etwa ein Gewitter mit Hagel auf? Hoffentlich nichtRegen ist viel besser für die Blumen auf dem Spielfeld.





Gesellschaftsspiele sind mehr als nur reine Beschäftigungsstrategie – sie fördern die geistige, soziale und emotionale Entwicklung. Hier sind kooperative Spiele besonders hilfreich. Diese basieren auf guter Zusammenarbeit, und die Spieler und Spielerinnen lernen, dass Erfolg nicht immer auf Kosten anderer geht, sondern dass man Ziele auch gemeinsam erreicht.
Beim kooperativen Spiel „Wolkenschiff“ zum Beispiel versuchen zwei bis vier Kinder, gemeinsam alle Blumenfelder zum Blühen zu bringen. Dafür müssen sie zwölf Blumen in die Blumenbeete auf dem Spielplan pflanzen, bevor ein Gewitter mit Sturm aufkommt. Für jede gewürfelte Blumenfarbe kommt jeweils eine Regenkugel in das Wolkenschiff. Alle Crewmitglieder heben nun das Schiff mithilfe der daran befestigten Schnüre gemeinsam an.






Leicht zu verstehen: Das Spiel bietet durch die einfachen Regeln einen schnellen Spieleinstieg und schult die Motorik. Unter www.amigospiele.de bekommen kleine Gärtner in einem bunten Video einen ersten Eindruck des Spiels. Eine Spielrunde dauert etwa 20 Minuten. Herausgeber: Amigo-Spieleverlag, Spiel für Kinder ab 6 Jahren , 2 – 4 Spieler, UVP 20,99 Euro








Fröhliche Einblicke in den Alltag einer Hundefamilie und eine Herzlichkeit und Wärme, die ansteckend sind.
„Gute Nacht, kleiner Flughund“ lautet der Titel einer fantasievollen Gutenachtgeschichte. Bluey will nicht ins Bett! Sie wäre viel lieber ein Flughund. Dann könnte sie die ganze Nacht herumfliegen und Abenteuer erleben. In weiteren Bänden wie z.B. im Such- und Wimmelbuch „Wo ist Bluey?“ können Kinder auf farbenprächtigen Wimmelbildern Bluey und Bingo suchen und auch viele andere spannende Dinge entdecken. Die kindliche Fantasie wird mit dem „Bastel- und Kreativbuch“ angesprochen. Eltern und Großeltern werden mit ihren Kindern und Enkelkindern und Bluey viel Freude haben.
Seit dem TV-Start 2018 im australischen Fernsehen erobert Bluey weltweit die Herzen von Kindern und Eltern. In mehr als 60 Ländern wird die beliebte und vielfach preisgekrönte Animationsserie für Vorschulkinder auf unterschiedlichen Kanälen ausgestrahlt. Hierzulande läuft sie auf dem Disney Channel, Disney+ und YouTube. Nun ist die kleine blaue Hündin im deutschsprachigen Raum erstmals auch in Buchform mit vielen weiteren Folgebänden erschienen – und eine schöne Geschenkidee für Kinder. Mittlerweile ist auch das passende Kuscheltier zum Liebhaben erhältlich.
Herausgeber: cbj Kinder- und Jugendbuchverlag, Bilderbuch für Kinder ab 3 Jahren, 24 Seiten, UVP 9,99 Euro


Schon ein Jahr lang sind Nicolina und Martin jetzt Eltern ihrer kleinen Tochter, die sie hoffentlich bald offiziell adoptieren werden.




Fast jedes zehnte deutsche Paar zwischen 25 und 59 ist ungewollt kinderlos. Auf 900 Kinder, die in Deutschland zur Adoption freigegeben werden, bewerben sich vier mal soviele Paare. Das ZDF-Filmteam von „37-Grad“ begleitet ein Paar im ersten Adoptionspflegejahr und ein Paar, das sich mit Geduld und Liebe den Problemen seiner 13-jährigen Adoptivtochter stellt. Ein Alltag mit emotionalen Höhen und Tiefen.
KANN ICH DAS KIND LIEBEN?
„Ich habe Ängste gehabt, ganz wilde Gedanken, was ist, wenn Du dieses Kind nicht lieben kannst, wenn du es siehst, und Du findest es blöd – oh Gott. Und ich bin in dieses Zimmer rein, in dem Linnéa lag, und es hat keine Sekunde gedauert, dass ich wusste, ich will und werde für diesen Wurm den Rest meines Lebens da sein. Ich bin direkt in Tränen ausgebrochen“, erinnert sich der 52-jährige Marc an die Fahrt ins Krankenhaus und den ersten Augenblick mit seiner Adoptivtochter Linnéa. Das kleine Mädchen wurde ein paar Tage zuvor geboren und lag mit einer Entzugsproblematik in der städtischen Kinderklinik. Ihre leibliche Mutter hat sie zur Adoption freigegeben, weil sie aus gesundheitlichen Gründen nicht in der Lage war, ihr Kind großzuziehen. Marc, der selbst adoptiert wurde, und seine Frau Katja sind bei ihrer Familienplanung sehr
offen gewesen. „Wir haben aufgehört zu verhüten und uns gleich zeitig beim Jugendamt als Adoptiveltern beworben und gedacht, mal sehen, was schneller geht“, erinnert sich Katja, 49 Jahre. Der Anruf vom Jugendamt kam schließlich schneller als eine Schwangerschaft.
ADOPTION ALS EINZIGE CHANCE
Nicolina (33) und Martin (38) dagegen können selbst keine Kinder bekommen. Doch ihr Wunsch nach einem eigenen Kind ist riesengroß – und Adoption ihre einzige Hoffnung auf Familienglück. Sie sind im Bewerberpool der Koblenzer Vermittlungsstelle des Sozialdienstes katholische Frauen (SkF) und hoffen täglich auf einen Anruf, der ihr Leben verändert. Als das ersehnte Klingeln ertönt, stehen ihre Gefühle Kopf, und sie erleben glückliche Tage mit ihrer kleinen Tochter. Martin gibt ganz klar zum Ausdruck, dass
es für ihn keinen Unterschied gäbe, ob angenommenes oder eigenes Kind. Das Paar ist überglücklich und können von Tränen gerührt ihr Glück kaum fassen. Sie dekorieren ihre Wohnung kindgerecht, hängen ein lustiges Mobile über den Wickeltisch, alles soll dem neuen Familienmitglied entsprechen. Der „neuen“ Mutter ist ihr Babyglück anzusehen, sie freut sich und strahlt. Martin ist auch aus dem Häuschen und geht behutsam mit der Kleinen um. So stellt man sich eine glückliche Familie vor.
Doch schon nach drei Wochen meldet sich die leibliche Mutter, die ihre Entscheidung rückgängig machen möchte und ihr Kind wieder zu sich nehmen will. Das darf sie nach geltendem Recht innerhalb der ersten acht Wochen. Nicolina und Martin freuen sich für das Kind –„aber für uns ist auch eine kleine Welt zusammengebrochen“, erzählt Nicolina traurig, „es war eine Gefühllosigkeit und Traurigkeit, dann aber auch eine riesige Dankbarkeit für die drei Wochen, in der wir das Mädchen hatten. Das möchten wir nicht missen, da sind wir uns darüber einig. Die Zeit mit ihr war wunderschön und war es auch wert, sie mit ihr zu verbringen.“ Martin gesteht, dass es für ihn

Katja (l.) und ihre 13-jährige Adoptivtochter Linnéa (r.) genießen das Zusammensein.
gefühlsmäßig so war, als wäre sie gestorben. Ihren Weg wollen sie trotzdem weitergehen. Sie hoffen, über den SkF ein anderes Kind vermittelt zu bekommen, das zur Adoption freigegeben wurde. „Wir freuen uns riesig über jedes Kind, das kommt“ gesteht Nicolina. Sie geht jetzt nach den drei Wochen – nach der ersehnten Mutterrolle – wieder zurück in den Beruf als Gesundheitsmanagerin, findet sich dort aber nicht so schnell zurecht und sie fragt sich schließlich, „was mache ich hier eigentlich?“. Ihr ist die Enttäuschung sichtlich anzumerken, doch noch immer ist sie optimistisch, dass es irgendwann wieder mit einer Adoption klappen könnte. Immer wieder kreisen ihre Gedanken jedoch um das kleine Mädchen, das sie nun für immer verloren hat. Nachdem ihr aber die leibliche Mutter ein Foto der Kleinen schickt, spürt sie Erleichterung, dass es dem Kind gut geht.
BEDINGUNGSLOSE LIEBE
Linnéa, die 13-jährige Tochter von Marc und Katja, hat bereits in der Schwangerschaft Traumatisches erlebt und durch den Drogenkonsum ihrer leiblichen Mutter wurde sie als Frühchen geboren. Sie musste erst einmal einen Entzug durchstehen. So hat sie verschiedene gesundheitliche Probleme mitgebracht. Sie war ein Schreibaby, hatte schweres Asthma und war Stammgast in der Kinderklinik. Hinzu kamen mit zunehmendem Alter Konzentrationsstörungen, Agressionsanfälle und ein erhebliches Aufmerksamkeitsdefizit – Diagnose ADHS. Sie sagt, sie sei sehr schreckhaft und sehr sensibel. Sie muss Medikamente nehmen und den Tag klar strukturieren. Viel Zeit mit der Familie, mit den Pferden auf dem Reiterhof und auch die Schule helfen ihr dabei. Der Umstand, dass sie nicht das leibliche Kind ihrer Eltern ist, wurde ihr nie verschwiegen, und sie fordert, wie für angenommene Kinder typisch, die bedingungslose Liebe ihrer Eltern immer neu heraus. Linnèa gibt zu, Verlustängste zu haben. Auch habe sie immer Angst, dass es Streit gäbe und eventuell etwas Schlimmes passieren könne. Daher ist sie sehr harmoniebedürftig.

Mit vier Jahren lernt sie ihre leibliche Mutter kennen und hat auch heute noch regelmäßig zur ihr Kontakt. Da sie selbst psychische Probleme hat, kann sie inzwischen die Beweggründe ihrer psychisch kranken leiblichen Mutter, sie als Kind wegzugeben, gut nachvollziehen. Linnéa hat erkannt, dass sie nicht einfach so abgegeben wurde und sie findet diese Entscheidung aus heutiger Sicht „ganz okay“ und sei dankbar darüber, ihre Herkunft zu wissen. Viele Kinder wüssten nicht, wo sie herstammen, sie kenne nun ihre leibliche Mutter. Der Vater jedoch bleibt weiter unbekannt, da ihre Mutter bei der Geburt den Vater nicht angegeben hat und sie auch weiterhin darüber schweigt. Katja, ihre jetztige Mutter, hat mittlerweile eine Beratungsstelle für Adoptiv- und Pflegefamilien gegründet, um ihre Erfahrungen zu teilen. Denn Marc und Katja mussten damals über zwei Jahre lang bangen und warten, ob die Adoption bewilligt wird, so lange war die Kleine ihr Pflegekind. Durch die Inobhutnahme durch das Jugendamt hat das Verfahren länger gedauert. Aufgrund der eigenen Adoptionsgeschichte kann Marc seiner Tochter stets versichern, dass er und Katja sie immer lieben werden, egal was passieren wird. Er sagt: „wenn Du selbst adoptiert bist, stellst Du dir die Frage nicht, ob das jetzt eine besondere Form der Familiengründung ist. Er hofft, seinen Töchtern mehr Sicherheit geben zu können, da er auch heute noch unter Verlustängsten leidet. Wenn Marc von seinen Eltern spricht meint er immer das Paar, das ihn damals angenommen und so viel für sein heutiges Leben mitgegeben hat. Dies bezeichnet er als tief emotionale Bindung. Schade findet er jedoch, dass er noch zwei Halbgeschwister hat, die er auch gerne kennengelernt hätte. Vor seiner Hochzeit hatte er es in den Unterlagen des Standesamtes gesehen und war darüber sehr überrascht. Hier sah er zum ersten Mal seine eigene Geburtsurkunde und stellte fest, dass er Geschwister hat und er ur-
Foto unten: Marc (r.), seine Frau Katja (l.) und ihre Töchter sind auf dem Spielplatz.

sprünglich einen anderen Vornamen hatte. Da er nun den Namen der leiblichen Mutter weiß, nimmt er Kontakt zu ihr auf. Sie schreiben sich Briefe und senden sich Fotos aus heutiger Zeit, doch die Verbindung reißt schnell wieder ab.
LEIBLICHE ELTERN SPIELEN
IMMER EINE ROLLE
Die Auseinandersetzung mit den leiblichen Eltern ist immens wichtig. „Der Umstand, dass sie nicht 'gewollt' waren, verursacht sehr häufig ein Trauma bei Adoptivkindern. Jede noch so kleine Information über die Eltern ist oft wie ein Schatz“, betont Claudia Iland, die seit 30 Jahren die Adoptions- und Pflegekindervermittlungsstelle des Sozialdienstes katholischer Frauen in Koblenz leitet. Darum versuchen sie und ihre Kolleginnen und Kollegen, auch unter den abgebenden Müttern, immer für eine offene Form der Adoption zu werben. Das bedeutet, dass leibliche Eltern und Adoptionseltern sich kennenlernen und die annehmenden Eltern ihren Kindern von ihren leiblichen Müttern erzählen können. Noch schöner ist es natürlich, wenn regelmäßige Besuchskontakte zwischen den Kindern und ihren leiblichen Eltern stattfinden können.
FAMILIENGERICHT ENTSCHEIDET
Das ist für Nicolina und Martin selbstverständlich, als sie zum zweiten Mal das Glück haben, ein kleines Mädchen vermittelt zu bekommen. „Wir erzählen ihr von Anfang an, dass sie eine Bauchmama hat“, berichten die jungen Eltern. „Wir stehen in Kontakt mit den leiblichen Eltern und wollen unserer Tochter das Gefühl geben, dass sie von uns allen geliebt wird.“ Gleichwohl hoffen sie inständig, dass sie dieses Mal mehr Glück haben und die Kleine nach einem Adoptionspflegejahr – in dem vom Jugendamt genau geprüft wird, ob es dem Kind an nichts fehlt – vor dem Familiengericht offiziell als „ihre“ Tochter annehmen dürfen.
Ein Film von Anabel Münstermann, der jederzeit in der ZDF-Mediathek angeschaut werden kann.

Die KSR-Geschäftsstelle in der Ebersteinstraße 25 (Ecke Salierstraße) in Pforzheim.


DER KREISSENIORENRAT ENZKREIS –STADT PFORZHEIM E.V. ist ein Informations- und Beratungszentrum für alle Generationen – auch für Menschen mit Behinderungen. Der KSR vermittelt Hilfe im Alter und fördert den Erfahrungsaustausch auf sozialem, wirtschaftlichem, kulturellem und gesellschaft lichem Gebiet. In der zentral gelegenen Geschäftsstelle steht ein dynamisches Büroteam für Auskünfte und Beratungen zur Verfügung.
PEDELEC-TRAINING
Der KSR bietet ein Fahrsicherheitstraining für E-Bike-/Pedelec-Fahrer:Innen an. Termin siehe Tagespresse.
FAHRSICHERHEITS-TRAINING
Für alle Veranstaltungen sind rechtzeitige Anmeldungen erforderlich!
Tel. 0 72 313 27 98
Im Mittelpunkt steht das aktive Ausprobieren eines sicheren Fahrstils. Unter Anleitung geschulter Moderatoren üben die Teilnehmer:Innen u.a. Bremsund Ausweichtechniken bei unterschiedlichen Fahrbahnbeschaffenheiten. Zusätzlich im Programm sind Tipps und Übungen zum Einparken, sei es in der Stadt am Straßenrand oder im Parkhaus. Die Gebühr beträgt 40 Euro, incl. Versicherung für das eigene Auto. Termin siehe Tagespresse.


sicherer Umgang mit PC und Bürosoftware erwünscht.
PLANUNG & BETREUUNG UNSERER NEUEN PROJEKTE, wie z.B.: Einrichten und Betreuen von Social-Media-Auftritten (z.B. in Facebook, Instagram, YouTube).
Durchführung von Recherchen (z.B. im Internet) zu verschiedenen Themen.
Aufbauen und Pflegen von Kontakten (Vernetzung) mit zukünftigen Partnern, z.B. zum Durchführen gemeinsamer Veranstaltungen. Anruf genügt: 0 72 313 27 98
VERKEHRSSICHERHEITSTAGE
Die Verkehrssicherheitstage finden auf dem Meßplatz bei der Feuerwehr statt. Es werden verschiedene Simulatoren bereit stehen, um die Reaktionsfähigkeit im Straßenverkehr zu prüfen. Die Teilnahme ist unverbindlich und kostenfrei. Termin siehe Tagespresse.
SENIORENKINO IM REX
An jedem 2. Mittwoch im Monat findet im Rex eine Kino-Veranstaltung mit einem speziell ausgewählten, qualitativ hochwertigen Film statt, Preis siehe Kasten. Anmeldung unter Tel. 0 72 31-13 70 11 oder info@rex-filmpalast.de
GALILEO-VIBRATIONSTRAINING
In der KSR-Geschäftsstelle gibt es die Möglichkeit, das GALILEO-VibrationsTrainingsgerät zum Gleichgewichtstraining und Muskelaufbau auszuprobieren oder regelmäßige Trainingseinheiten zu nehmen (s. Kasten rechts). Die Erstbetreuung, erfolgt donnerstags und freitags von 10 – 12 Uhr beim KSR unter der fachtherapeutischen Anleitung unserer Physiotherapeutin, Folgeanwendungen jeweils donnerstags. Vorherige tel. Anmeldung erforderlich.

VORSORGEMAPPE
Sie hilft Ihnen dabei, alle wesentlichen Infos für Notsituationen zusammenzustellen. Wichtige Daten, Angaben und Dokumente wie Vorsorgevollmacht, Betreuungsverfügung, Patientenverfügung, Testament, Bestattungsverfügung sind zentral an einem Ort zu finden.
Die vorgefertigten Vorlagen sind bequem per Hand ausfüllbar, so haben Sie schnell bei einem Unfall oder einer plötzlichen Erkrankung alles griffbereit.
Ein wichtiges Hilfsmittel, das beim KSR gegen eine Schutzgebühr von 3,– Euro erhältlich ist.
THEATER-VORSTELLUNGEN
Stadttheater Pforzheim:
• So., 29. Dezember 2024: A Christmas Carol –Eine Weihnachtsgeschichte, Musical von Alan Menken
• So., 2. Februar 2025: Tristan und Isolde, Tanzstück
• So., 25. Mai 2025: Singin in Rain, Musical
Anfangszeiten sind jeweils 15.00 Uhr.
KSR-Preis: 17,80 Euro pro Karte
Anmeldung: Tel. 0 72 31 - 39 29 69
GESCHÄFTSSTELLE:
Ebersteinstr. 25 (Ecke Salierstraße) 75177 Pforzheim (Nordstadt)
Telefon 0 72 31 / 3 27 98
E-Mail: info@kreisseniorenrat-pf.de Mo. – Fr. vormittags 10 – 12 Uhr geöffnet
VORTRÄGE
Patientenverfügung, Vorsorge, Testament, Erbschaft, um 15.00 Uhr, in der Geschäftsstelle; kostenfrei durchgeführt von der Erbrechtsanwältin Isabell Hutter. Termine siehe Tagespresse. Rechtzeitige Anmeldung erforderlich! Wenn zu wenige Anmeldungen vorliegen, fällt der Vortrag aus.
Weitere Vorträge: die Themen sind u.a. Demenz, Bestattungsvorsorge, Senioren im Straßenverkehr, Pflege, Einbruchschutz , Enkel-Trick und weitere. Termine siehe Tagespresse.
Rechtzeitige Anmeldung erforderlich!
SMARTPHONE, PC UND TABLET
Jeden Dienstag und Donnerstag gibt ab 14.00 Uhr der IT-Fachmann Uwe Vogt individuelle Beratung zum Smartphone, PC, Tablet. Anmeldung erforderlich! Preis siehe Kasten rechts.
„WIR“ – WOHNEN IN REICHWEITE W=WOHNEN I=IN R=REICHWEITE
Echte Nachbarschaft – selbstbestimmt leben, raus aus der Einsamkeit – rein in die Gemeinschaft. Wenn Sie eine Gruppe suchen, um neue Kontakte aufzubauen wenden Sie sich an die WIR-Gruppen:
„Leben im Quartier“ (ehemals WIR-Gruppe im Rodgebiet): Die Gruppe trifft sich mittwochs zum Laufen, Kegeln, Spielen oder anderes.
Bitte anrufen beim Ansprechpartner: Bernd Schnepf, Tel. 0 72 31-2 57 99 WIR-Gruppe Buckenberg: Treff jeden letzten Mittwoch im Monat, um 17.00 Uhr, Cafeteria AKS, AugustKayser-Str. 23.
Ansprechpartnerin:
– Waltraud Bopp, Tel. 0 72 31-6 44 10 – Dr. Angela Ulrich, Tel. 0 72 31-2 80 23 54
INFORMATIONS-NEWSLETTER
Regelmäßig erscheint per E-Mail der kostenfreie Info-Newsletter des KSR. Er informiert über Aktionen und Veranstaltungen, die durch den KSR organisiert werden – oft in Kooperation mit öffentlichen Trägern.
Anmeldung unter: www.kreisseniorenrat-pf.de oder per E-Mail: info@kreisseniorenrat-pf.de
AUSSCHUSS FÜR „SOZIALES UND BESCHÄFTIGUNG”
Hier ist der KSR beratendes Mitglied bei der Stadt Pforzheim und seit 15 Jahren Mitglied in der Steuerungsgruppe „Bündnis für Familie“. Auf kommunaler Ebene setzt sich der KSR für die Interessen der Senioren und Behinderten ein. Die Themen sind u.a.: barrierefreie Wohnungen, Wohnen für Hilfe, Barrierefreiheit im öffentlichen Raum, Sicherheit in der Stadt – z.B. in der Fußgängerzone, längere Grünphasen der Ampeln, seniorengerechte Optimierung der öffentlichen Verkehrsmittel, Freizeitangebote, Freihalten der Behindertenparkplätze und verschiedene Seniorentreffpunkte.
WOHNBERATUNG FÜR SENIOREN UND MENSCHEN MIT BEHINDERUNG Erfahren Sie mehr über die 4 Bereiche, in denen die Abteilung Wohnberatung des KSR für Senioren und Menschen mit Behinderung unterstützend tätig ist. Sie ist eine neutrale, unabhängig arbeitende Fachabteilung des KSR und berät Interessierte in der Geschäftsstelle zu barrierefreiem Wohnen und Leben im Alter und bei Behinderung. Die zertifi zierten Berater begleiten, unter Einbeziehung modernster technischer Möglichkeiten und Hilfsmittel, bei Neu- und Umbaumaßnahmen, die für ein eigenständiges und sicheres Leben notwendig werden. Wir beraten Sie gern!
Durch Ihre Mitgliedschaft mit einem Jahresbeitrag von nur Euro 35,- unterstützen Sie die Arbeit und Aktionen des KreisSeniorenRats Enzkreis Stadt Pforzheim e.V. für Seniorinnen und Senioren sowie Menschen mit Behinderung. Eine Ermäßigung des Beitrages um 50% auf Grund geringen Einkommens (z.B. Bezug von Grundsicherung oder ALG II) ist auf Nachweis möglich.


Diese Vorteile erhalten Sie mit Ihrer Mitgliedschaft:
Persönliche Mitgliedskarte des KreisSeniorenRats Enzkreis Stadt Pforzheim e.V., diese ermöglicht Ihnen die vergünstigte Teilnahme zu einigen Veranstaltungen, die durch den KSR Enzkreis Stadt Pforzheim e.V. organisiert werden, wie z. B.: Hilfe bei Fragen rund um PC, Tablet und Smartphone zum Preis von EUR 10,00 pro halbe Stunde für Mitglieder, anstatt EUR 15,00 für Nichtmitglieder. Übungen am Galileo-Gleichgewichts-Trainingsgerät unter fachlicher Anleitung zum Preis von EUR 5,00 für Mitglieder, anstatt EUR 7,00 für Nichtmitglieder. TEILNAHME AN WEITEREN INTERESSANTEN VERANSTALTUNGEN für Seniorinnen/Senioren und Menschen mit Behinderung, wie z.B.: regelmäßige ausgewählte Kino-Angebote zum Spezialpreis von EUR 5,50 für Mitglieder, anstatt von EUR 7,00 für Nichtmitglieder (Anmeldung direkt beim Kino Tel. 0 72 31 - 13 70 11 unbedingt erforderlich!). Es gibt jetzt wieder Kaffee und Kuchen im Anschluss des Filmes nebenan im „Chillers“, Preis 7,00 Euro. (Sitzplatzreservierung Tel. 0 72 31 - 13 70 11) . Rollatortraining, Fahrsicherheitstraining, und Pedelec-Training für Seniorinnen/Senioren (in Zusammenarbeit mit der „Verkehrswacht Pforzheim und Enzkreis e.V.“).
Wohnberatung (die Erstberatung ist kostenlos).
Vorsorgemappe mit Formularen direkt zum Ausfüllen (Vorsorgevollmacht, Betreuungsverfügung, Patientenverfügung, Testament, Bestattungsverfügung), inklusive ausführlicher nicht-juristischer Beratung in der Geschäftsstelle des KreisSeniorenRats zum Preis von EUR 4,00 für Mitglieder, anstatt von EUR 5,00 für Nichtmitglieder. weitere seniorenrelevante Infos, Beratungsleistungen und Veranstaltungen. regelmäßiger Newsletter per E-Mail mit aktuellen Infos zu Veranstaltungen des KreisSeniorenRats, Anmeldung unter: info@kreisseniorenrat-pf.de

Die Debatte über das Arbeiten im Rentenalter ist in voller Fahrt. „Und warum auch nicht noch ein paar Euro dazu verdienen?“ – ist Volkes Meinung. Doch die Möglichkeiten sind ungleich verteilt, deshalb tut eine Versachlichung in dieser Debatte Not. Meinungsforscher vom Unternehmen Civey haben herausgefunden, dass zwar jeder Zweite über 50 Jahren sich vorstellen kann, neben der Rente zu arbeiten. Die Motivation dafür ist bei einem Drittel der Befragten jedoch, dass das Geld im Ruhestand nicht reicht.
Mehr als 60 Prozent der Befragten nannten als Grund, dass sie gerne arbeiteten – auch nach dem Renteneintritt. Und natürlich stellt für fast 47 Prozent der Befragten die Möglichkeit, zusätzliches Geld zu verdienen, eine interessante Perspektive dar. Mehrfachantworten waren ebenfalls möglich.
Ein Blick auf den sozialen Status der Befragten verrät mehr. Zu wenig Geld zu haben, aufgrund niedriger Renten, gaben mit 50,4 Prozent Arbeiterinnen und Arbeiter an, Geschiedene liegen mit 46,7 Prozent knapp dahinter und Menschen mit Kindern im Haushalt waren rund 40,7 Prozent. Dagegen fällt auf, dass Beamte nur mit rund 10,2 Prozent finanzielle Nöte als Grund für eine Betätigung im Rentenalter angaben. Aber es gibt natürlich noch andere Gründe, weiter beruflich tätig zu sein. Einer ist die zunehmende Personalknappheit.
Allenthalben wird beklagt, dass die Bewerberlage gegen Null geht. Und in der Tat verlieren wir bis 2035 weitere 7 Millionen Arbeitnehmerinnen und Arbeitnehmer in den Ruhestand. Und eine wirkliche Kompensation zeichnet sich nicht ab. Deswegen sind bereits viele Betriebe dazu übergegangen, ihr in Bälde ausscheidendes Personal zu halten. Dagegen ist wohl auch nichts einzuwenden; allerdings sollte das nicht zu Lasten der Gesundheit gehen. Und wer bei Eintritt in die Regelrente noch „schaffen“ möchte, weil er dringend gebraucht wird, sollte auch steuerlich entlastet werden.
Frank Johannes Lemke, Kreisvorsitzender des KSR Enzkreis - Stadt Pforzheim

Das Team des KreisSeniorenRats Enzkreis – Stadt Pforzheim (v.l.n.r.): Teresa Neuhaus (2. Vorsitzende), Uwe Vogt (Beisitzer, Computerhilfe), Norbert Horn (2. Vorsitzender), Ilse Kästner (Beisitzerin, Bürotätigkeiten), Gabriele Bardow-Amanuel (Wohnberatung & Pflege), Frank Johannes Lemke (1. Vorsitzender), Siegfried Schwill (IT & Buchhaltung), Waltraud Bopp (Beisitzerin, Bürotätigkeiten & Revisorin), Andrea Überall (Wohnberatung & Pflege).
EINBAU EINES PERSONENAUFZUGS ZWECKS BARRIEREFREIHEIT
Bundesgerichtshof (BGH), Urteil vom 09.02.2024 – Az: V ZR 244/22
Im Urteil vom 09.02.2024 (Az: V ZR 244/ 22) entschied der Bundesgerichtshof (BGH) über den Anspruch auf Einbau eines Aufzugs zur Barrierefreiheit in einer Wohnungseigentümergemeinschaft. Die Kläger, Eigentümer von zwei Wohnungen im 3. und 4. Stock eines denkmalgeschützten Hinterhauses, beantragten in einer Eigentümerversammlung im Juli 2021 den Einbau eines allgemein zugänglichen Aufzugs. Die Eigentümergemeinschaft (GdWE) lehnte sowohl den Antrag als auch den Hilfsantrag, den Aufzug auf eigene Kosten zu errichten, ab. Daraufhin klagten die Kläger auf gerichtliche Ersetzung des abgelehnten Beschlusses. Das Landesgericht gab den Klägern Recht und sah einen Anspruch gemäß § 20 Abs. 1 WEG. Der BGH bestätigte dies und wies die Revision der GdWE zurück. Die Beschlussersetzungsklage nach § 44 Abs. 1 S. 2 WEG sei begründet, da die Kläger Anspruch auf einen Beschluss hätten, der ordnungsgemäßer Verwaltung entspricht. Es reiche aus, dass die Voraussetzungen für einen Grundlagenbeschluss (das „Ob“ der Maßnahme) vorliegen. Die genaue Ausgestaltung (das „Wie“) bleibe der GdWE vorbehalten.
Der Einbau eines Aufzugs ist gemäß § 20 Abs. 1 WEG eine privilegierte Maßnahme. Nach § 20 Abs. 2 S. 1 Nr. 1 WEG kann jeder Wohnungseigentümer angemessene bauliche Veränderungen verlangen, die Menschen mit Behinderung zugutekommen. Diese Voraussetzung ist erfüllt, wenn die bauliche Veränderung für die Nutzung durch körperlich oder geistig eingeschränkte Personen erforderlich oder förderlich ist. Dies trifft im vorliegenden Fall auf die Errichtung des Aufzugs zu. Es spielt keine Rolle, ob und in welchem Maße der Wohnungseigentümer oder seine Angehörigen selbst auf die Maßnahme angewiesen sind. Der Gesetzgeber wollte mit der Privilegierung bestimmter baulicher Veränderungen einem gesamtgesellschaftlichen Bedürfnis Rechnung tragen, nicht nur den Interessen einzelner
Wohnungseigentümer. Das Landesgericht stellte fest, dass bauliche Veränderungen, die einem der in § 20 Abs. 2 WEG genannten Zwecke dienen, in der Regel als angemessen gelten. Eine Ablehnung wegen Unangemessenheit kommt nur in Ausnahmefällen in Betracht, wenn die Nachteile die Vorteile überwiegen. Diese Nachteile müssen über die typischen Folgen wie Eingriffe in die Bausubstanz oder optische Veränderungen hinausgehen. Relevant sind nur Nachteile, die die Gesamtheit der Wohnungseigentümer betreffen und nicht durch Auflagen bei der Bauausführung abgemildert werden können (§ 20 Abs. 2 S. 2 WEG). Die Kosten der Maßnahme sind grundsätzlich ohne Belang und von den Eigentümern zu tragen, die die Maßnahme verlangen (§ 21 Abs. 1 S. 1 WEG). Die GdWE hat zwar Recht, dass der klagende Eigentümer die Darlegungsund Beweislast für die Angemessenheit trägt. Die Kläger haben jedoch die beabsichtigte Baumaßnahme ausreichend konkretisiert. Die Beklagte hat eine sekundäre Darlegungslast für nachteilige Umstände, die eine Unangemessenheit begründen könnten. Nur wenn solche Umstände vorgebracht werden, muss der klagende Wohnungseigentümer diese widerlegen. Die Beklagte hat jedoch keine Gründe für einen atypischen Ausnahmefall vorgetragen. Die vom Landesgericht als unerheblich eingestuften Nutzungseinschränkungen im Hof, Durchgang und Treppenhaus sowie die optische Veränderung und finanziellen Belastungen wurden zu Recht als unerheblich eingestuft. Das geplante Vorhaben bewegt sich innerhalb der Grenzen zulässiger baulicher Veränderungen gemäß § 20 Abs. 4 WEG. Die Errichtung des Aufzugs führt nicht zu einer grundlegenden Umgestaltung der Wohnanlage. Ob dies der Fall ist, hängt von den Umständen des Einzelfalls ab. Grundsätzlich wird eine solche Umgestaltung bei Maßnahmen, die einem der in § 20 Abs. 2 S. 1 WEG genannten Zwecke dienen, nicht angenommen. Außergewöhnliche Umstände, die eine Ausnahme begründen könnten, sind nicht ersichtlich. Das Landesgericht hat auch rechtsfehlerfrei eine unbillige Benachteiligung eines
Wohnungseigentümers verneint (§ 20 Abs. 4 Hs. 1, 2. Alt. WEG). Eine unbillige Benachteiligung liegt vor, wenn die Maßnahme bei wertender Betrachtung und Abwägung der Vorteile nicht von einem verständigen Wohnungseigentümer verlangt werden kann. In die Abwägung fließt ein, dass bestimmte Maßnahmen im gesamtgesellschaftlichen Interesse privilegiert behandelt werden. Eine besonders schwere Benachteiligung, die auf die genannte Norm zurückgreifen könnte, ist nicht erkennbar. Insbesondere wird eine solche nicht durch die Verschattung einzelner Wohnungen oder etwaige Lärmstörungen begründet.
Quelle: Magazin Rechtsdienst der Lebenshilfe, Ausgabe 3/24, Seite 135 und 136
Millionen von Menschen in Deutschland sind von Einsamkeit betroffen. Auch die Älteren in der Gesellschaft trifft es immer häufiger.
Mit der „Strategie der Bundesregierung gegen Einsamkeit“ soll das Thema übergreifend und mit einer Vielzahl von Maßnahmen angegangen werden. Die Ziele der Strategie richten darauf ab, die Öffentlichkeit über das Thema zu sensibilisieren, das Wissen um die Vorbeugung im professionellen Kontext und das Engagement auszubauen, die Arbeit von Praktikern in der sozialen Arbeit zu stärken, Einsamkeit als gesamtgesellschaftliche Herausforderung zu verstehen und Betroffene mit bedürfnisorientierten Angeboten zu versorgen. In diesem Rahmen wurde bereits zusammen mit dem „Kompetenznetzwerk Einsamkeit“ eine Auflistung der bereits existierenden Angebote für Betroffene erstellt:
HILFS- UND BERATUNGSANGEBOTE
Entsprechend der Vielfalt an Bedarfen gibt es eine Liste mit Kontakt- und Hilfsangeboten. Darunter die „TelefonSeelsorge Deutschland“, der „krisenchat“, die „Nummer gegen Kummer“, „Redezeit für Dich“ und andere Organisationen.
DIGITALE TEILHABE
Hier gibt es verschiedene Organisationen und Plattformen, die es sich zur Aufgabe gemacht haben, auch abseits der analogen Welt, der Einsamkeit entgegenzutreten. Hier helfen der „Digitale Engel“, „Weg aus der Einsamkeit e.V.“ und weitere Organisationen.
PROJEKTE, DIE VERBINDEN
Dabei geht es um Projekte, die Menschen aktiv zusammenbringen wie „1:1Tandem“, Besuchspartnerschaften oder auch digitale Plattformen wie „nebenan.de“, in denen sich Nachbarn näher kennenlernen und sich zu gemeinsamen Aktivitäten verabreden können.
MODELLPROJEKTE GEGEN EINSAMKEIT
Mit dabei sind die Mehrgenerationenhäuser, bei denen ein aktives Miteinan-
der der verschiedenen Generationen geschaffen und aktiv gelebt wird. Weiterhin das Projekt „Miteinander-Füreinander“ von Malteser mit Unterstützungs- und Begleitungsdiensten. Ebenso „DigitalPakt Alter“, diese Initiative setzt sich für die digitale Teilhabe der Älteren in der Gesellschaft ein.
APPS, DIE VERNETZEN
Hier finden sich Freizeit-Communities wie „GemeinsamErleben“, „Helpcity“ für den Austausch mit Personen mit ähnlichen Problemen. Bei „Meet 5“, kann man Leute finden, um etwas zu unternehmen oder gemeinsame Freizeitaktivitäten zu planen. Auch andere Apps wie „friendsUp“ sind mit dabei.
PROJEKTE ZUM THEMA ARBEITEN
Dabei werden mit dem Modell „Zukunftswerkstatt Kommunen“ 40 Kommunen bei der Gestaltung des demografischen Wandels begleitet und unterstützt. Ein Instrument dabei, der digitale Werkzeugkoffer: hier stehen Methoden, Konzepte und Dokumentationen für alle Interessierten kostenlos zur Verfügung.
Vielen Ehepaaren ist nicht bekannt, zu welchen Ergebnissen die sog. gesetzliche Erbfolge, d.h. Erben, wenn kein Testament vorhanden ist, führen kann. Das Erbrecht ist ein reines Verwandtenerbrecht, in dem der Ehegatte eine Sonderstellung einnimmt.
Deshalb erbt der überlebende Ehegatte nach dem Gesetz gemeinsam mit den Kindern und auch dann nicht allein, wenn keine Kinder vorhanden sind. In dem Fall sind die Erben der sog. 2. Ordnung – also Eltern oder Geschwister des Erblassers und, falls die Geschwister bereits verstorben sind, deren Abkömmlinge – zu ¼ am Nachlass beteiligt, wenn die Ehegatten in Zugewinngemeinschaft gelebt haben. Diese oft ungewollte Folge kann durch ein Testament zugunsten des Ehegatten vermieden werden. Nur wenn es keinerlei Erben in der 1. und 2. Ordnung gibt, erbt der Ehegatte auch ohne Testament allein.
DAS GEMEINSCHAFTLICHE TESTAMENT
IST NICHT IMMER DIE RICHTIGE WAHL
Nach dem Bürgerlichen Gesetzbuch dürfen Ehegatten gemeinsam ein Testament errichten, d.h., nur ein Ehegatte schreibt den gemeinschaftlich überlegten Text, der andere Ehegatte unterschreibt das Testament lediglich. Hierbei sollte allerdings beachtet werden, dass diese Testamentsform in anderen Ländern nicht üblich ist, so dass – sollte einer der Ehegatten nicht die deutsche Staatsangehörigkeit haben oder Vermögen, insbesondere Grundeigentum im Ausland vorhanden sein –zunächst zu klären ist, ob das gemeinschaftliche Testament die richtige Form hat und im Erbfall nicht zu Problemen führt.
DER INHALT DES „BERLINER TESTAMENTES“
Der „Normalfall“ eines Ehegattentestamentes ist das sog. Berliner Testament. Dabei wird der längerlebende Ehegatte Erbe des Zuerstversterbenden und weitere Personen werden als Erben auf den Tod des letzten der Ehegatten eingesetzt. Sollte es sich bei den Schlusserben auf den Tod des Längerlebenden um gemein-
schaftliche Kinder handeln, sind diese, da der überlebende Ehegatte nach dem Tod des Zuerstversterbenden Alleinerbe wird, automatisch „enterbt“, können also nur ihr gesetzliches Pflichtteilsrecht geltend machen.
PFLICHTTEILSSTRAFKLAUSEL UND STUNDUNG DES PFLICHTTEILS
Um zu verhindern, dass die Kinder durch das Pflichtteilsverlangen den überlebenden Ehegatten in finanzielle Schwierigkeiten bringen, wird häufig in das Testament aufgenommen, dass ein Pflichtteilsberechtigter, der nach dem Tod des Erstversterbenden seinen Pflichtteil geltend macht, auch nach dem Tod des zuletztversterbenden Ehegatten nicht erbt sondern wiederum nur den Pflichtteil erhält. Damit erhält ein Pflichtteilsberechtigter, der sich nicht an die Wünsche im Testament hält, jeweils nur die Hälfte der gesetzlichen Erbquote. Bei einer solchen Pflichtteilsstrafklausel sind jedoch verschiedene Fallkonstellationen zu beachten, denen meistens zu wenig Aufmerksamkeit geschenkt wird. Insbesondere sollte darauf geachtet werden, wie die Klausel formuliert ist, also, in welchen Fällen sie wirklich eingreift und ob es Möglichkeiten gibt, sollte sich der überlebende Ehegatte mit dem „untreu“ gewordenen Kind wieder versöhnen, die Enterbung für den zweiten Erbfall rückgängig zu machen. Häufig haben Ehegatten Angst, das Haus in dem sie wohnen im Erbfall verkaufen zu müssen, um die Pflichtteilsansprüche der Kinder befriedigen zu können. Sollte es sich bei dem Haus um den einzigen Vermögensgegenstand handeln und kein weiteres Vermögen vorhanden sein, aus dem sich der Anspruch befriedigen ließe, dann kann beim Amtsgericht Stundung des Pflichtteilsanspruchs beantragt werden.
DER WIEDERVERHEIRATUNGSFALL
Weiterhin ist auch darauf zu achten, dass geregelt wird, was passieren soll, wenn der überlebende Ehegatte sich erneut verheiratet. Das Gesetz sieht vor, dass er binnen eines Jahres nach der Eheschließung das Ehegattentestament anfechten und damit hinfällig machen kann. Dieses Anfechtungsrecht kann auch von dem neuen Ehegatten ausgeübt werden. Bei der Formulierung des Ehegattentestamentes ist daher darauf zu achten, ob solche Anfechtungsmöglichkeiten ausgeschlossen werden sollen oder eventuell noch weitergehende Maßnahmen ergriffen werden sollen, um den Kindern den Nachlass zu sichern, in dem der überlebende Ehegatte im Falle der Wiederverheiratung die Kinder an der Substanz des Nachlasses des vorverstorbenen Ehegatten zu beteiligen hat. Sollten keine Kinder vorhanden sein, kommen Regelungen für den Wiederverheiratungsfall normalerweise dann in Betracht, wenn einer der Ehegatten den Hauptteil des Vermögens in die Ehe eingebracht hat und für den Fall seines Vorversterbens sicherstellen möchte, dass dieses nicht einem neuen Ehegatten zugutekommt. Wichtig ist, dass diese Klauseln nicht zum absoluten Ehehindernis werden, dadurch könnte die Klausel unwirksam werden, oder der überlebende Ehegatte entscheidet sich gegen eine Wiederverheiratung.
DES TESTAMENTES Weiterhin sind die Abänderungsmöglichkeiten zu bedenken. Falls beide Ehegatten noch leben, können sie das Testament gemeinsam ändern, wenn sie sich einig sind. Sobald einer der Ehegatten nicht mehr in der Lage ist, Änderungen vorzunehmen, durch Demenz oder andere seine Testierfähigkeit beeinträchtigende Krankheiten, ist die Änderung nur noch durch den vollständigen Widerruf des Testamentes möglich, was jedoch zur Folge hat, dass der nicht mehr testierfähige Ehegatte kein neues Testament mehr abfassen kann, nach ihm also die gesetzliche Erbfolge gilt. Hier muss der andere Ehegatte gut ab-
wägen, wie er weiter vorgehen möchte. Aber auch Änderungen nach dem Tod eines Ehegatten vorzunehmen, kann schwierig sein, da die in einem Ehegattentestament getroffenen Verfügungen häufig mit dem Tode des ersten Ehegatten eine solche Bindungswirkung entfalten, dass der überlebende Ehegatte sie kaum aufheben kann. Deshalb sollten Ehepaare, die ein gemeinsames Testament abfassen, in dieses Testament eine Abänderungsklausel aufnehmen. Solche Abänderungsklausel ist auf den jeweiligen Bedarf abzustimmen und kann eine generelle Abänderungsmöglichkeit für den überlebenden Ehegatten beinhalten, so dass er ein komplett neues Testament erstellen kann. Sie kann aber auch nur die Möglichkeit eröffnen, bezüglich der zu Schlusserben eingesetzten Kinder, die Erbquoten abzuändern oder auf Katastrophenfälle in deren Familien zu reagieren.
HÄUFIG NICHT BEDACHT:
DIE ERSATZERBEN
Viele Ehegatten, insbesondere wenn keine Kinder vorhanden sind, überlegen den Fall, dass die auf den Tod des letztversterbenden Ehegatten eingesetzten Erben vorher versterben, nicht. Dadurch läuft das Testament auf den Tod des Längstlebenden ins Leere, nach ihm gilt die gesetzliche Erbfolge, obwohl dies häufig nicht gewollt ist. Insoweit sollten die Ehegatten überlegen, wer als Ersatzerbe in Betracht kommt. Sollte es sich dabei um eine oder mehrere caritative Organisationen, auch z.B. Stiftungen, handeln, ist es sinnvoll, für diesen Fall einen Testamentsvollstrecker einzusetzen.
Dazu kann der Erblasser in seinem Testament jede Person bestimmen, zu der er das Vertrauen hat, dass sie den Nachlass in seinem Sinne regelt. Aufgaben eines Testamentsvollstreckers können insbesondere sein, für die Bestattung zu sorgen, den gesamten Nachlass abzuwickeln und den verbleibenden Geldbetrag den jeweiligen Erben zur Verfügung zu stellen. Er kann darüber hinaus aber auch dazu verpflichtet werden, zu überwachen, dass im Testament genannte Zwecke, die von den Erben zu erfüllen sind, auch wirklich erfüllt werden. Die Testamentsvollstreckung ist bereits im Testament anzuordnen, nur dann kann eine Person als Testamentsvollstrecker tätig werden.
Auch die Familienverhältnisse, insbesondere, ob alle Kinder aus der gemeinsamen Ehe stammen, ist von entscheidender Bedeutung. Eltern in Patchwork-Familien sind erbrechtlich zu besonderer Aufmerksamkeit aufgerufen. Betroffen sind die Familien, in denen wenigstens einer der Partner Kinder aus einer früheren Verbindung in eine Ehe einbringt. Vielen ist gar nicht bewusst, dass solche Familienverhältnisse für den Erbfall einer besonderen Vorsorge bedürfen, damit gewährleistet ist, dass sowohl der Partner als auch die Kinder zu ihrem Recht kommen. Hier ist das Berliner Testament, in den meisten Fällen nicht geeignet, da durch diese Testamentsform die Kinder des Zuerstverstorbenen quasi gezwungen sind, ihren Pflichtteilsanspruch geltend zu machen. Auch besteht häufig das Interesse,
den leiblichen Kindern den eigenen Nachlass zuzuwenden, ohne die Kinder des anderen Ehegatten daran teilhaben zu lassen, insoweit ist die Regelung von Vor- und Nacherbschaft, oder eine Erbeneinsetzung der eigenen Kindern mit Nießbrauchsbestellung für den überlebenden Ehegatten häufig eine Möglichkeit die gewünschte Verteilung zu erreichen.
DIE ERBSCHAFTSTEUER
Abschließend noch ein Blick auf die für Ehegatten geltenden Steuersätze: Für Ehegatten liegt der Steuerfreibetrag derzeit bei 500.000 EUR. Das bedeutet, dass zwischen Ehegatten Vermögenstransfers bis zur Höhe von 500.000 EUR in einem Zeitraum von 10 Jahren steuerfrei sind. Sind seit der letzten Schenkung mehr als 10 Jahre vergangen, kann der Ehegatte weitere 500.000 EUR steuerfrei erben. Eine interessante Regelung betrifft das so genannte „selbst genutzte Familienheim“. Erbt der Ehegatte das bisher gemeinsam bewohnte Haus und bleibt er für einen Zeitraum von 10 Jahren in dem Haus wohnen, so ist der Erwerb des Hauses erbschaftssteuerlich neutral. Das Haus kann somit zusätzlich zu Vermögenswerten in Höhe des Freibetrags geerbt werden, ohne dass Steuer anfällt. Eine Übertragung des gemeinsam genutzten Hauses zu Lebzeiten beider Ehegatten an den anderen Ehegatten war bisher schon steuerneutral und bleibt es auch. Sollte im Erbfall der überlebende Ehegatte innerhalb der 10-Jahresfrist das Haus nicht mehr bewohnen können, weil er zum Pflegefall wird, wird die Erbschaftsteuer nicht nacherhoben.


Stoffausschnitt der Alltagskleidung von der Bauerntochter Elisabeth Märcz, aus Blaudruckstoffen von ihrer Mutter genäht, Murgau (Ungarn) um 1942.








Eines hatten die Frauen in den Ländern entlang der Donau gemeinsam: Dick wollten sie aussehen. Weil aber leider, leider nicht alle üppiger Natur waren - vielleicht auch, weil die Pfunde beim vielen Arbeiten purzelten -, beschissen sie. Ein offenes Geheimnis. Sie schichteten mehrere Unterröcke übereinander. In der aktuellen Ausstellung „Schwerer StoffFrauen, Trachten, Lebensgeschichten“ im Donauschwäbischen Zentralmuseum in Ulm kann man sich diese weißen Baumwollröcke selbst anziehen.
Dann merkt man schnell, wie unpraktisch sie doch eigentlich waren. Doch Schönheitsideal ist Schönheitsideal. Eine dicke Frau hieß automatisch: Ich bin wohlhabend, denn ich habe genug zu essen. Und ich bin in der Lage, viele Kinder auf die Welt zu bringen. Eigentlich aber war dieses, man könnte es Gefieder nennen, ziemlich unpraktisch. Nichts ging mehr alleine. Nicht hinsetzen, nicht aufstehen, nicht aufs Klo gehen. Auf dem Heiratsmarkt war Üppigkeit trotzdem eine wichtige Währung. Deshalb - und davon soll der Ausdruck „unter den Rock schauen“ kommenüberprüften die Burschen bei der Frau mit einem Blick unter deren Rock, mit wie vielen Schichten sie geschummelt hatte. Eine senfgelbes Seidenkleid mit knallroten, aufgestickten Blumen, verziert mit Spitze und verzierter Schürze ist ein Hingucker zu Be-



Aquarell von Erna Piffl (1904 – 1987): ältere Bäuerin in Sonntagskleidung, um 1935.



























ginn der Ausstellung. Das Kleid gehörte Katharina Just aus Kéty/Giek (in der Schwäbischen Türkei/Ungarn). Als 14-Jährige begleitet sie in den 1940ern ihren Vater in den Nachbarort, wo er eine Kuh verkaufen will. In einem Schaufenster entdeckt sie den „fantastisch gemusterten Stoff“. Sie ist hingerissen. Der Stoff aus Wien ist leider nur sehr teuer. Ihr Vater verspricht, ihr den Stoff unter einer Bedingung zu kaufen: Sie werden die Kuh los. Der senfgelbe Stoff wurde ihr Festgewand. Der Vater war sicherlich auch recht stolz darauf, seine Tochter so zu sehen. Denn es ging ja bei den Bauern um kluge Heiratspolitik, darum, den eigenen Besitz zu vergrößern. Katharinas Chancen dürften also, eingehüllt in die neue, sogenannte Kunstseide - die damals



Foto oben Mitte: Festlich, aber unbequem: 14-jähriges Mädchen in Zăbrani (Rumänien), 1933.






Sonntags-Leibchen von der 13-jährigen Theresia Kresz in Szárász (Ungarn), um 1940.
der letzte Schrei war - gestiegen sein. Was zählte, war „der schöne Schein“. Und „gespart wurde (stattdessen), wo es niemand sieht“, heißt es in der Ausstellung. Wenn dann zwei heirateten, hatte das in Schwarz zu geschehen. Donauschwäbinnen trugen die „Farbe“ zu allen großen Momenten im Leben: Hochzeiten, hohe Kirchenfeste und auf dem Sterbebett dann ein letztes Mal. So ist das bis zum Zweiten Weltkrieg und so ist das auch 1880 bei der Hochzeit von MariaAnna Tremml aus dem Banat, dem heutigen Rumänien. Ihr Kleid ist ebenfalls ausgestellt. Noch in in den 1950ern heirateten traditionsbewusste Bauerntöchter im Banat in Schwarz. Anna Remy ist 1955 die erste im Dorf, die Weiß wagt, kombiniert immerhin mit ein paar schwarzen Zierstreifen (Foto unten rechts). Später braucht ihre Tochter dann eine Tracht fürs Kirchweihfest. Da lässt sie kurzerhand den weißen Stoff mit bunten Blumen bemalen. Das Muster kann man in dem Kleid im Donauschwäbischen Zentralmuseum noch heute, trotz des vielen Waschens, leicht erkennen. Übrigens: Donauschwäbische Bräute schmückten sich oft mit ei-

nem Rosmarinzweig, als Symbol der Liebe. Und war man dann verheiratet, trug man Kopftuch. Zum Arbeiten hatten die Frauen meist einen blau gefärbten Rock an. Und wenn sie schon älter waren, sollten die Ärmel lang sein, keine Haut zeigen. Die Tracht war stets in dunklen Farben gehalten. Es geht in den donauschwäbischen Ländern partout immer darum, Wohlstand zu zeigen, vor allem wenn man jung ist. Katharina Burger gelingt das in den 1930ern im heutigen Serbien. Viele Jahre trägt sie ein rotes Samtkleid mit üppigen Blumen und Goldknöpfen. Das bekommt sie schon mit elf, es passt sich aber wegen des an der Taille zusammen gebundenen Rocks ihrem Wachstum an. Nach dem ersten Kind trägt sie es noch immer. 1944 muss die reiche Bäuerin Katharina allerdings aus Jugoslawien flüchten. In Deutschland geht es erstmal mit ganz wenig los, mit einem Stück Land.

















Verschleppt zur Zwangsarbeit in der Sowjetunion: die Donauschwäbin Katharina Rettig (rechts) mit drei Russinnen, die sie während der Deportation kennengelernt hat, Donezk (heute Ukraine), 1949.




1944 wird die älteste Tochter der in Ungarn lebenden Familie Märcz zur Zwangsarbeit in die UdSSR verschleppt: die 15-jährige Katharina. Sie kommt ums Leben. Kurz darauf, der Krieg ist zu Ende, muss Familie Märcz nach Deutschland zwangsumsiedeln. Katharinas Kleider kommen mit. Die Mutter erlaubt der jüngeren Tochter Elisabeth Katharinas Seidenkleider anzuziehen. Die ist erst ziemlich stolz darauf, doch dann will sie aussehen wie die jungen Mädchen in Deutschland. Sie darf dann aus einigen Röcken neue Outfits schneidern. Etwa das fesche, taillierte grüne Dress mit den bauschigen roten Blumen, das in der Mitte der Ausstellung ins Auge sticht. So wenig Stoff! So leicht! Info: www.dzm-museum.de









Mit der passenden Gehhilfe zu mehr Mobilität und Selbstbestimmung
In der Wohnung hin- und herlaufen, zum Einkaufen oder zum Arzt gehen, Ausflüge mit der Familie machen oder Veranstaltungen besuchen: Mobilität ist ein Grundbedürfnis und gleichzeitig die Basis für ein selbstbestimmtes Leben.

Ist die Gehfähigkeit aufgrund einer Behinderung oder hohen Alters eingeschränkt, können geeignete Hilfsmittel Betroffene dabei unterstützen, mobil zu bleiben. Oft stellt sich dann die Frage: Rollator oder Rollstuhl?


Kombi-Modell: Entweder Rollstuhl ... ... oder Rollator


Leben und wohnen im Alter –bei uns können Sie sich wohlfühlen.
Wir bieten: Dauerpflege, Kurzzeitpflege, Betreutes Wohnen
Heim am Hachel
Kaiser-Wilhelm-Str. 10-12
75179 Pforzheim
Tel. 07231 181-0
Haus Maihälden
Adolf-Merkel-Str. 5
75179 Pforzheim
Tel. 07231 94 45-0
Seniorenzentrum Keltern
Pforzheimer Straße 36
75210 Keltern
Tel. 07236 93 365-0
Seniorenzentrum Sonnhalde
Marxzeller Straße 52
75305 Neuenbürg
Tel. 07082 79 27-0
Mehr Infos unter: www.siloah.de „Altenhilfe“
Für ein persönliches Beratungsgespräch stehen wir Ihnen gerne zur Verfügung.






Grundsätzlich sind Rollatoren für Menschen geeignet, die noch über ausreichend Beinkraft und Beweglichkeit verfügen, um selbst zu gehen. Sie bieten Unterstützung und Sicherheit vor Stürzen, die Möglichkeit zum Befördern von Taschen und Einkäufen sowie eine Sitzgelegenheit für Ruhepausen. Wenn die eigenen Beine nicht mehr tragen, kann man sich im Rollstuhl sitzend fortbewegen –bei eingeschränkter Kraft entweder von einer anderen Person geschoben oder mit Antrieb durch Elektromotor. Nicht immer aber fällt die Entscheidung eindeutig aus: Viele Senioren und gehbehinderte Menschen können kürzere Wege noch gut mit einem Rollator bewältigen, bei längeren Strecken, auf unebenem Boden oder nach einer anstrengenden Unternehmung ist aber doch der Rollstuhl gefragt. Statt ständig zwischen zwei Hilfsmitteln zu wechseln, kann dann ein Kombigerät die richtige Wahl sein. Der MovingStar AllinOne etwa ist Elektrorollstuhl, Rollator und Schiebehilfe in einem, wiegt weniger als 19 Kilo und lässt sich mit praktischen Klappfunktionen ganz einfach zusammenfalten und verstauen. Die beiden Elektromotoren ermöglichen ca. 20 Kilometer Reichweite und schaffen bis zu 15 % Steigung. Sie unterstützen auch beim Schieben, sodass es auch weniger kräftigen Begleitpersonen keine Mühe macht. Die Kombi von Rollstuhl und Rollator hat dabei den Vorteil, dass man jederzeit die passende Mobilitätshilfe dabeihat und nicht zwei Geräte verstauen und transportieren muss. Außerdem unterstützt selbstständiges Gehen mit Rollator den Erhalt der Muskelkraft. Im Fachhandel oder unter www.movingstar.de kann man sich beraten lassen.
Auch im Alter sehnen wir uns nach einem Zuhause, an dem wir ungestört unsere Privatsphäre genießen und unseren eigenen Lebensstil ausleben können – möchten uns dabei aber trotzdem sicher und geborgen fühlen. Seniorinnen und Senioren genau einen solchen Ort zu bieten, hat sich die Residenz Ambiente Pforzheim zum Ziel gesetzt. Hier im Herzen der Goldstadt, am Ufer der malerischen Enz, werden sie liebevoll betreut und genießen dabei den Komfort des Betreuten Wohnens. Die großzügigen Apartments, allesamt mit eigenem Bad und einem Balkon oder Wintergarten ausgestattet, bieten viel Raum für Individualität. Zudem profitieren die Bewohnerinnen und Bewohner von entlastenden Serviceleistungen, die ihnen das Leben im Alter erleichtern.
Dank eines 24-Stunden-Notrufsystems können sie sich immer auf schnelle Hilfe verlassen und so ein gutes Gefühl von Sicherheit genießen. Auf Wunsch steht ihnen der hauseigene Ambulante Pflegedienst zur Seite, der zuverlässig für sie sorgt. Neben kompetenter Pflege hilft er auch bei der Haushaltsführung, bietet Unterstützung bei behördlichen Angelegenheiten oder begleitet die Seniorinnen und Senioren zum Arzt oder zum Einkaufen.
Wenn sie möchten, können die Bewohnerinnen und Bewohner der Apartments auch an dem abwechslungsreichen Freizeit- und Beschäftigungsangebot im Haus teilnehmen. Ob Ausflüge, jahreszeitliche Veranstaltungen, Sport- oder Kreativangebote – Langeweile kommt hier keine auf.



Auch für Menschen, die nach einem Reha- oder Krankenhausaufenthalt Unterstützung benötigen oder sich einfach mal so richtig erholen möchten, finden hier ihren Platz. Sie werden intensiv sowie individuell durch externe Ärzte und Therapeuten betreut und wieder fit für das eigene Zuhause gemacht. Eine Dachterrasse mit herrlichem Blick auf den Schwarzwald macht die Residenz zum perfekten Ort, um wieder neue Kraft zu schöpfen.
Mehr Informationen erhalten Sie unter: pforzheim.residenz-ambiente.de
Bei uns finden Senioren ein attraktives Zuhause
voller Leben: direkt an der Enz, im Herzen Pforzheims, mit guter Verkehrsanbindung.
• großzügige, seniorengerechte Apartments mit Balkon oder Wintergarten
• repräsentative, täglich besetzte Rezeption
• eigener Ambulanter Dienst im Haus
• kompetente Pflege nach einem Reha- oder Krankenhausaufenthalt
• abwechslungsreiche Veranstaltungen
• Einkaufsmöglichkeiten in unmittelbarer Umgebung
Die Schleimhaut, medizinisch Mukosa, kleidet einige Körperhöhlen und auch die Atemwege aus und produziert Schleim, der sie bedeckt und vor Keimen schützt. Im Winterhalbjahr jedoch sind die zarten Schutzbarrieren vermehrt Nässe, Kälte und Wind ausgesetzt. Dadurch trocknen sie aus, werden spröde und damit anfälliger für Viren und Bakterien. Umso wichtiger ist gute Pflege. Neben einer ausgewogenen Ernährung, ausreichender Flüssigkeitszufuhr sowie Bewegung im Freien können tibetische Kräuterrezepturen wie Padma 28 active mit Vitamin C die Schleimhäute gezielt unterstützen: www.padma.de.


KEUCHHUSTEN




JÄHRLICHE GRIPPE-IMPFUNG
Grippe ist eine schwere Krankheit, wird aber oft mit einer Erkältung verwechselt.
Er gilt immer noch als „Kinderkrankheit“, obwohl viele Erwachsene betroffen sind.
Gerade bei Menschen ab 60 Jahren und mit Grunderkrankungen wie Asthma und COPD kann Keuchhusten schwere Komplikationen wie Rippenbrüche, Inkontinenz und Lungenentzündungen verursachen. Die STIKO empfiehlt deshalb allen Erwachsenen eine einmalige Keuchhusten-Auffrischimpfung. Info: www.impfen.de/keuchhusten.
ERKÄLTUNGSSPRAY

Wenn Kinder in die Kita kommen, sind sie die ersten Jahre quasi ständig erkältet. Daher sollten Kinder früh lernen, sich häufig die Hände zu waschen, um Infekte zu vermeiden. Erkältungsviren lassen sich auch mit dem Rotalgen-Wirkstoff Carragelose in algovir Erkältungsspray abblocken. Er bildet einen Schutzfilm auf der Nasenschleimhaut, der Erkältungsviren am Eindringen hindert, wirkt nicht systemisch und ist ab einem Jahr geeignet. Eine vitaminreiche Ernährung und viel Bewegung im Freien helfen zusätzlich, das Immunsystem zu stärken. Mehr unter: www.algovir.de
Die Unterschiede sind deutlich: Während die Grippe meist plötzlich und mit hohem Fieber, schwerer Erschöpfung sowie starken Kopf- und Gliederschmerzen auftritt, beginnt eine Erkältung in der Regel langsam mit eher milden Symptomen. Die Ständige Impfkommission (STIKO) empfiehlt die jährliche Grippe-Impfung Menschen ab 60 Jahren und bei bestehenden Grunderkrankungen.



Selen ist unerlässlich für das Immunsystem, den gesamten Stoffwechsel, die Schilddrüsenfunktion und die Spermienproduktion.
Das Spurenelement kann nur über die Nahrung aufgenommen werden. Da die Ackerböden in Deutschland jedoch arm an Selen sind, ist ein Mangel keine Seltenheit. Um zu hohe oder zu niedrige Dosierungen zu vermeiden, ist ein Test beim Hausarzt ratsam, der den exakten Bedarf ermittelt. Bewährt haben sich etwa selenase-Tabletten in verschiedenen Dosierungen.
Mehr Infos unter www.biosyn.de.
Diese Informationen ersetzen keine ärztliche Beratung und dürfen daher nicht zur Selbsttherapie verwendet werden.










Vor der Inanspruchnahme des Hausnotrufdienstes sollte der Anbieter kostenlos, gründlich und verständlich über seine Dienste, die Technik und die Kosten informieren.


Eine persönliche Beratung in den eigenen vier Wänden ist im Service inbegriffen: Das Hausnotrufsystem wird auf Wunsch dort ausführlich erklärt, installiert und der Ernstfall mit dem Kunden geprobt.




Statistische Erhebungen zeigen, dass viele Unfälle in den eigenen Räumlichkeiten passieren: Jedes Jahr verletzen sich bei Stürzen zu Hause mehr als 400.000 Menschen, die älter als 65 Jahre sind.
Ein Drittel der über 65-Jährigen stürzt einmal im Jahr, bei den über 75-Jährigen ist es sogar jeder Zweite. Und 40 Prozent der Einweisungen ins Pflegeheim sind durch Stürze bedingt. Dabei gibt es eine Alternative, die ein unabhängiges Leben zu Hause möglich macht: Ein Vitakt-Hausnotrufsystem bringt die nötige Sicherheit. Rechtzeitig eingesetzt kann es verhindern, dass an sich oftmals harmlose Stürze schwerwiegende Folgen haben. Außerdem garantiert es, dass im Notfall unverzüglich Hilfe kommt.
Ein Knopfdruck auf den Sender, den der Kunde bei sich trägt –und schon geht ein Notruf an eine Notrufleitstelle. Dort melden sich Mitarbeiter, die an 365 Tagen im Jahr rund um die Uhr eingehende Notrufe beantworten. Über eine Wechselsprechanlage, die in das Hausnotrufsystem eingebaut ist, kann der Kunde frei sprechen, ohne das Telefon
benutzen zu müssen. Die Mitarbeiter der Notrufleitstelle hören mit und können direkt antworten. Im Notfall wird dort unverzüglich nach den Anweisungen gehandelt, die zuvor mit dem Kunden vereinbart worden sind: Entweder wird der Rettungsdienst alarmiert oder es werden – wenn kein akuter Notfall vorliegt – Angehörige, Pflegedienst oder Nachbarn verständigt. Das Vitakt-Hausnotrufsystem ist ein anerkanntes Pflegehilfsmittel. Bei Pflegebedürftigkeit kann, unabhängig vom jeweiligen Pflegegrad, ein Antrag auf Kostenübernahme gestellt werden. Bei Antragsgenehmigung werden die Kosten (eine monatliche Miete) vollständig von der Pflegekasse getragen. Weitere Geld- oder Sachleistungen der Pflegekasse werden davon nicht berührt. Auch Selbstzahler bekommen, je nach Anbieter, ein Hausnotrufsystem für eine monatliche Miete von Euro 25,50.
Die Mitarbeiter in der Notrufzentrale sind freundlich und hilfsbereit und reagieren kompetent auf einen Hilferuf.

Der Vertrag garantiert, dass ein Hausnotrufsystem b ei Mängeln repariert oder ausgetauscht wird. Außerdem sieht der Vertrag keine Mindestlaufzeit, sondern die Möglichkeit einer Kündigung zum jeweiligen Monatsende vor.





Rückhalt und Hilfe auf Knopfdruck
• monatliche Miete 25,50 €, zum Monatsende kündbar
• Kostenübernahme durch die




UNVERBINDLICH INFORMIEREN 0 59 71 - 93 43 53 | vitakt.com






Gesunde Ernährung trägt wesentlich dazu bei, bis ins hohe Alter körperlich und geistig fit zu bleiben. Die angebotenen Speisen des DRK-Menüservice des Kreisverbandes PforzheimEnzkreis e.V. werden nach neuesten ernährungswissenschaftlichen Erkenntnissen zubereitet. Sie sind nicht nur gesund und abwechslungsreich, sondern auch schmackhaft, preiswert und bequem. So spart man sich mühsames Einkaufen, Vorbereiten und Kochen.
Der DRK-Mahlzeitenservice bietet dabei die wohl längste Speisekarte der Stadt! Über 200 vitamin- und nährstoffreiche Menüs – auf Wunsch auch halbe Portionen - können die Kunden aus dem Katalog auswählen. Da ist





für jeden Geschmack etwas dabei. Ob Vollkost oder leichte Vollkost, Menüs für Kalorien- und Cholesterinbewusste oder vegetarische Menüs, Schon- und Sonderkost – beim DRK werden alle kulinarischen Bedürfnisse berücksichtigt. Die Klienten wählen dabei selbst, ob sie täglich mit warmem Essen beliefert werden möchten, oder ob sie die ausgewählten Menüs tiefgekühlt erhalten und bei Bedarf selbst erhitzen.
Anzeige

Zu einem guten Wohlgefühl zuhause gehört auch das Thema Sicherheit. Seit fast 30 Jahren bietet das DRK den Hausnotruf an und gibt älteren, alleinstehenden, gebrechlichen oder anderweitig gefährdeten Menschen jeden Alters sowie deren Angehörigen im Alltag Sicherheit, Selbständigkeit und die Gewissheit, dass man im Notfall kompetente Hilfe von speziell dafür ausgebildeten Mitarbeitern bekommt. Die Gehäuse der Sender sind wasserdicht, so dass mit ihnen problemlos geduscht oder gebadet werden kann. Eine ständige Überwachung der Batterien sichert die Funktionsbereitschaft des Geräts. Die Leistungsvariante „Mobil“ ist für alle, die Sicherheit wollen auch auf Spaziergängen, Reisen, auf der Arbeit, im Freien und auf Wanderungen. Dank der GPSFunktion kann in Notfallsituationen jederzeit und überall eine Ortung erfolgen. Die monatlichen Kosten für diese spezielle Uhr betragen 60 Euro zuzüglich der Anschlussgebühr. Das Modell „James B7“ hat keine Pflegekassenzulassung. Alternativ wird dieses Modell von easierlife mit Pflegekassenzulassung angeboten, das neben dem klassischen Hausnotruf ebenso eine GPS-Ortung ermöglicht und ohne Internet– und Telefonanschluss funktioniert.




Berufsbegleitender Fernlehrgang im Gesundheits- und Sozialwesen
Unternehmen des Gesundheitswesens und der Sozialwirtschaft müssen immer wirtschaftlicher denken. Daher stellen sie hohe Anforderungen an die Qualifikation ihrer Fach- und Führungskräfte. Wer hier weiter vorankommen möchte, kann sich mit einem Fernlehrgang zum Geprüften Fachwirt im Gesundheits- und Sozialwesen fortbilden und sich gute Karrierechancen sichern.
INHALTLICH WEITERKOMMEN
Der Fernlehrgang, der an der IHK-Akademie Koblenz angeboten wird, ist eine Kombination von Selbstlernphasen mit intensiver Betreuung durch Tutoren und Tutorinnen sowie ergänzenden Präsenzveranstaltungen. Die Teilnehmenden erlangen tief reichende Fachkenntnisse in den Bereichen der Gesundheits- und Sozialpolitik, der Sozialgesetzgebung, des (Sozial)-Marketings und der Öffentlichkeitsarbeit. Sie lernen, eigenständig komplexe fachliche und verantwortliche Aufgaben in entsprechenden Unternehmen und Einrichtungen wahrzunehmen, darunter zum Beispiel Planung, Führung, Organisation und Controlling. Dazu gehört auch, Unternehmensziele und -strategien zu entwickeln und auszugestalten, unternehmerische Entscheidungen umzusetzen und Finanzierungs- und Investitionskonzepte zu erarbeiten. Das bringt ihnen Vorteile auf dem Arbeitsmarkt: Die Absolventen des Lehrgangs können Führungsaufgaben in vielen Einrichtungen übernehmen, etwa in Krankenhäusern und Kliniken, Gesundheitszentren, Reha- und Kureinrichtungen, Wohn- und Pflegeheimen, Trägerorganisationen bei ambulanten Pflegediensten, Transport- und Rettungsdiensten, in der Beratung und Koordinierung oder in Verbänden, Krankenkassen und Versicherungen.
BERUFSBEGLEITENDE WEITERBILDUNG
Als Kursvoraussetzung müssen die Teilnehmenden eine einschlägige Berufspraxis nachweisen, deren Dauer von der Art ihres Ausbildungsabschlusses abhängig ist. Nähere Infos dazu findet man auf www.ihk-akademie-koblenz.de. Abgeschlossen wird die Fortbildung mit der entsprechenden Prüfung vor der Industrie- und Handelskammer. Der gesamte Fernlehrgang läuft berufsbegleitend über 18 Monate inklusive Lernpausen. Pro Woche sollte man rund sieben Stunden Zeitaufwand einplanen.
Die Lehrgangs- und Prüfungsgebühren können mit dem Aufstiegs-Bafög des Bundesministeriums fur Bildung und Forschung (BMBF) gefördert werden. Dieses besteht vermögensunabhängig aus einem Zuschuss und einem zinsverbilligten Darlehen. Kostenlose Beratungshotline: 0800/622 36 34 (Mo. – Do. von 8 – 18 Uhr, Fr. von 8 – 16:30 Uhr) oder beim Landratsamt Enzkreis, Amt für Ausbildungsförderung, Bahnhofstr. 28, 75172 Pforzheim, 0 72 31/308 - 94 49 oder - 93 89. Antragsformulare: aufstiegs-bafög.de/antragsformulare



Mit dem erfolgreichen Abschluss zum Geprüften Fachwirt/zur Geprüften Fachwirtin im Gesundheits- und Sozialwesen erfüllt man die Voraussetzungen für die Weiterqualifikation zum/zur Geprüften Betriebswirt/-in.

Anzeige

www.seniorenresidenz-pforzheim.de




Sich wohlfühlen, sich entfalten können, daheim sein ...
Behagliche und großzügige Räumlichkeiten, ein schönes und gepflegtes Umfeld gelten nicht nur für unsere Bewohner:innen, denn wir sind besonders stolz auf unsere gut ausgebildete Belegschaft und das freundliche Miteinander.
Werden Sie unsere neue examinierte Pflegefachkraft (m/w/d) oder unser neuer Pflegehelfer (m/w/d)? Wir heißen Sie jetzt schon willkommen in unseren Häusern. Gerne erwarten wir Ihre Bewerbungsunterlagen per E-Mail – wir freuen uns auf Sie!
SR Senioren-Residenz GmbH
Haus Nagoldblick in Pforzheim-Huchenfeld: info@seniorenresidenz-pforzheim.de
Haus Bergdorf in Pforzheim-Büchenbronn: info@seniorenresidenz-pforzheim.de
Gesundheit lässt sich bis ins hohe Alter maßgeblich beeinflussen. Wie das gelingt, erläutert David Buchmüller, Bewegungsexperte der AOK Nordschwarzwald.
„Dass wir älter werden, können wir nicht aufhalten. Wir können jedoch einiges dafür tun, dass es uns dabei gut geht“, ist der Sporttherapeut überzeugt. Ein wichtiger Faktor sei dabei die innere Einstellung. Forschende der Harvard Universität fanden heraus, dass Dankbarkeit Prozesse ankurbelt, die sich positiv auf den Körper auswirken. Das Gute: Dankbarkeit lässt sich trainieren. Wer täglich drei bis fünf Dinge aufzählt, für die er oder sie dankbar ist, kann das Wohlbefinden steigern. Grundsätzlich nehmen die körperlichen Funktionen mit zunehmendem Alter ab. Wer jedoch jede Gelegenheit nutzt, Bewegung in den Alltag einzubauen, kann dem entgegenwirken. „Denn nur was beansprucht wird, bleibt auch erhalten“, erklärt David Buchmüller. Mit den Kindern rennen, ein paar Liegestützen am Schreibtisch oder eine Dehnübung am Treppengeländer, der Aufwand dafür muss nicht groß sein. „Werden zusätzlich Dauer und Intensität variiert, können damit unterschiedliche Systeme wie Muskeln, Knochen oder der Kreislauf angesprochen werden. Am meisten bringt
das, wenn Bewegung über den Tag verteilt, wird“, rät der AOK-Sportfachmann. Treppen lassen sich zum Beispiel in moderatem Tempo bewältigen, schnell oder indem zwei Stufen auf einmal genommen werden. Auch das Gehirn wird sowohl durch neue als auch durch unterschiedliche Bewegungsabläufe positiv beeinflusst. Ablenkung allein reicht allerdings nicht aus, um zu entspannen. „Wir können nur regenerieren, wenn wir wirklich zur Ruhe kommen“, gibt David Buchmüller zu bedenken, „Hilfreich ist es zum Beispiel, aktiv innezuhalten, sich in der Natur zu bewegen oder zu meditieren.“ Da die Atmung diesen Prozess unterstützt und oftmals zu flach ist, rät er zu entsprechenden Übungen. Sie sorgen nicht nur für Entspannung, sondern auch für mehr Gelassenheit in stressigen Zeiten. Eine einfache Übung ist beispielsweise die Box-Atmung. Dabei atmet man vier Sekunden ein, hält dann vier Sekunden die Luft an, atmet vier Sekunden aus, hält dann erneut vier Sekunden die Luft an und beginnt den Ablauf dann wieder von vorne. Drei weitere Faktoren, die Einfluss auf Gesundheit und Fitness haben, sind ausreichender Schlaf, eine ausgewogene Ernährung und soziale Kontakte. „Acht bis zehn Stunden Schlaf werden empfohlen.
Auch im Alter fit und aktiv bleiben.
Dann sind Sie bei der AOK BadenWürttemberg genau richtig:
Mit speziellen Gesundheitskursen für Senioren unterstützen wir Sie für ein gesundheitsbewusstes und aktives Leben jenseits der 60.
AOK Baden-Württemberg
Die Gesundheitskasse Nordschwarzwald.
Da dies aber individuell unterschiedlich ist, muss jeder für sich herausfinden, wie viel Schlaf er oder sie benötigt“, sagt David Buchmüller. Genauso typabhängig sind die sozialen Kontakte – die einen brauchen mehr, den anderen reichen wenige Kontakte aus. Der Sporttherapeut verweist auf Untersuchungen aus Regionen, in denen Menschen ein besonders hohes Durchschnittsalter erreichen. Buchmüller: „Sie haben ganz unterschiedliche Lebensläufe, jedoch drei Dinge gemeinsam: Sie sind bis an ihr Lebensende sozial eingebunden, haben eine positive Einstellung zum Leben und kein Übergewicht.“
Bei der Ernährung rät David Buchmüller, so naturbelassen wie möglich zu essen – also Lebensmittel zu verwenden, die gar nicht oder nur wenig verarbeitet sind. So haben Milchprodukte meist nur eine kurze und Obst oder Gemüse gar keine Zutatenliste. Gewürze wie Ingwer, Petersilie oder Knoblauch verleihen den Speisen nicht nur Geschmack, sondern tragen mit ihren wertvollen Inhaltsstoffen auch zu einer ausgewogenen Ernährung bei. Das Fazit des AOK-Experten: „Wem es gelingt, diese Erkenntnisse in seinen Alltag zu integrieren, kann positive Auswirkungen auf seine Gesundheit erzielen.“

Dieses Jahr feiert die SPPS Unternehmensgruppe ihr 30-jähriges Bestehen. Die Gründung der heutigen Unternehmensgruppe SPPS geht auf das Jahr 1994 zurück. Damals wie heute lautet das Motto „SPPS – das Plus an Leistung für den Menschen“. Dieses Jubiläum soll als Anlass genommen werden, die Erfolge der letzten 30 Jahre zusammenzufassen.
1994 gründete Susanne Pletowski, gelernte Krankenschwester, den ersten ambulanten Pflegedienst SPPS – Susanne Pletowski PflegeService. Die Resonanz und Nachfrage war von Anfang sehr positiv und schnell wurde klar, dass dies nur der Anfang sein sollte. Das zeigt die Unternehmensgeschichte: 1994: Gründung der SP PS e. K. in Karlsruhe/ Stupferich, 1996: Gründung SPPS Pforzheim GmbH, 1998: Gründung Arche Noah gGmbH, 1998: Gründung SPPS Oberhausen GmbH, 2006: Gründung SPPS Baden-Baden Rastatt GmbH, 2007: Gründung der SPPS Intensiv
GmbH, 2009: Gründung SPPS Sanitätsservice Limited, 2009: Gründung SPPS Service GmbH, 2010: Neubau eigener Büroräumlichkeiten in Karlsruhe/Stupferich mit dem Seminarwesen „Impuls Atelier“ für Tagungen und Seminargestaltung, 2014: Gründung SPPS Hungarian KFT, 2016: Gründung Lysero GmbH (Bau- und Vermietungsgesellschaft), 2017: Übernahme von Notrufgeräten der Firma Recontrol, 2019/20: Umzug der SPPS Baden-Baden Rastatt GmbH in neu errichtete Räumlichkeiten nach Ötigheim und Inbetriebnahme einer Tagespflege, ergänzt durch Serviceleistungen über den ansässigen ambulanten Dienst der SPPS Baden-Baden Rastatt mit barrierefreiem Wohnen sowie Betriebswohnungen (Quartierskonzept).
Durch den Einsatz von geschulten Mitarbeiter/-innen unterschiedlicher Qualifikation, können sich die Kunden, bei optimaler pflegerischer und medizinischer Versorgung, zuhause wohlfühlen. SPPS ist kompetent,
individuell und flexibel für ihre Kundschaft da und das rund um die Uhr an 365 Tagen im Jahr. Alle Einrichtungen werden kontinuierlich überwacht. Ihre Erfahrung, Investitionen und die ständige Weiterbildung ihrer 130 Mitarbeiter haben die SPPS-Unternehmensgruppe zu einem zuverlässigen Partner und Arbeitgeber gemacht, der sich täglich um die Anliegen von bis zu 600 Kunden kümmert. SPPS bedankt sich bei allen, die den bisherigen erfolgreichen Weg mitgegangen sind und zukünftig mitgehen werden.
1994 gründet Susanne Pletowski (im schwarzen Kleid) ihren Pflege-Service SP PS in Karlsruhe. Sie begann damals mit 8 Mitarbeiterinnen. Foto: privat






Dr. Dorothea Zeise-Süss betreibt ihr TherapieHaus
TCM- und AkupunkturBehandlungen.
Freundlich gestaltete Räumlichkeiten.




Training mit dem GigerMD-Therapiegerät.


Ursprünglich geplant als ein Ruhepol für ParkinsonPatienten, als Angebot multimodaler Behandlungen für diese Erkrankung, hat sich das kleine Haus in Remchingen-Singen entschieden, für viel mehr zu stehen: Für Junge und Alte; für Kranke und Gesunde; für große und kleine Künstler und solche, die einfach Spaß am Malen und Gestalten haben; für alle, die Rhythmus und Musik lieben; für alle, die in unserer krisengeplagten Welt Schönes sehen und schaffen möchten.
DIE ANGEBOTE IM SPEZIELLEN:
Im Therapeuticon, der seit über zehn Jahren bestehenden Privatpraxis für integrative Therapie, werden neben Parkinson-Patienten (Schwerpunkt) alle Menschen zu den unterschiedlichsten Therapien eingeladen. Nach ausführlicher Anamnese und Diagnostik lernen Sie die tiefer liegenden – oft chronischen Ursachen – ihrer Beschwerden kennen.

Schädelakupunktur nach Yamamoto (YNSA)


Das TherapieHaus in Remchingen-Singen, Blumenstr. 16


Kunstkurse mit einer Kunsttherapeutin.

Körper & Geist in Einklang bringen mit Qi-Gong.

Trommelkurse mit der Nova-MusicSchool.




www.therapeuticon.de
Zusammen mit Dr. Dorothea Zeise-Süss, die über mehr als 40 Jahre Erfahrung in der Schulmedizin, Naturheilverfahren, Akupunktur und asiatische Heilkunde verfügt, erstellen Sie einen individuellen Behandlungsplan. Sie wählen aus einem umfangreichen Therapieangebot dasjenige aus, das sie anspricht. Ihnen wird auf verschiedene Weise ein Weg gezeigt, sich besser zu fühlen, im Idealfall gesund zu werden und zu bleiben oder einer Verschlechterung einer chronischen Erkrankung entgegenzuwirken. Mit anderen Worten: auf verschiedenen Wegen werden die Selbstheilungskräfte jedes einzelnen angeregt.
DAS TRAININGSPROGRAMM:
Das GIGER-MD-THERAPIEGERÄT (in der Schweiz entwickelt) verbessert die Koordination und die Kraft in Armen und Beinen. Das Training hat sich bewährt bei Morbus Parkinson, Multipler Sklerose, Zustand nach Schlaganfall und anderen Bewegungsstörungen, zum Beispiel nach Unfall oder Operationen. Mit der SIWAVE, einer neuartigen Schwingungsplatte, wird mit sanften Sinusschwingungen die Durchblutung angeregt und je nach Stärke der Schwingungen, die Muskulatur aufgebaut und Verklebungen in den Faszien gelöst. Nach einem speziell für jeden Trainierenden zugeschnittenen Therapieplan wird die für den einzelnen wirkungsvolle und angenehme Frequenz eingestellt und je nach Befinden gesteigert. Messungen über die Wirkung mithilfe der HerzratenVariabilität (HRV) zeigen Ihnen und Ihrer behandelnden Ärztin den Therapieerfolg.


Trainingseinheiten mit der SiWave mit ther. Anleitung

Zur Funktionsweise: Die SiWave unterscheidet sich von so genannten Vibrationsplatten darin, dass das Bewegungstraining mittels Sinuswellen abläuft. Sie sind eine natürliche Form des Bewegungsablaufs unseres Körpers, beispielsweise beim Gehen. Die beiden nebeneinander liegenden Platten ahmen den natürlichen Gang – durch abwechselndes Heben und Senken innerhalb der Sinuswelle – nach. Untrainierte ältere oder kranke Personen scheinen hiervon am meisten zu profitieren, was durch verschiedene Studien belegt wurde. Wohnortnah kann dieses Gerät ausprobiert oder auf Anfrage für zu Hause zur Verfügung gestellt werden: Tel. 0 72 31 - 800 75 20. Der BODY – ebenfalls ein SiWave-Schwingungsgerät – gedacht für Beschwerden in der oberen Körperhälfte, wird in gleicher Weise angewandt, immer unter fachkundiger Anleitung nach individuellem Therapieplan. Zum Gleichgewichtstraining steht in der Praxis auch ein TRAMPOLIN zur Verfügung.
Das ärztliche Angebot im Therapeuticon umfasst zahlreiche Behandlungen, wie z.B.: Infusions-und Injektionsbehandlungen mit schulmedizinisch ausgerichteten und/oder naturheilkundlichen Medikamenten stehen ebenso zur Auswahl wie eine Entgiftung, Schwermetallausleitung, Darmaufbau, eine Eigenblut-Behandlung zur Allergiebehandlung und zur besseren körpereigenen Abwehr. Sowohl ein Post-COVID- als auch ein Post-Covac-Syndrom und chronische Müdigkeit werden behandelt. Ein Schwerpunkt des Tätigkeitsfelds ist die Akupunktur. Im Vordergrund steht die Schädel-Akupunktur nach Yamamoto, aber auch Ohrakupunktur, traditionelle chinesische Akupunktur, chinesische Zungendiagnostik und TCM. Die Innovation: ein speziell für den Patienten erstellter Therapiehelm wird angeboten. Dies ist insbesondere von Bedeutung für Patienten, die weiter entfernt von der Praxis wohnen. Ernährungsberatung und – NEU AB DEZEMBER – PSYCHOLOGISCHE PSYCHOTHERAPIE MIT EINER THERAPEUTIN runden das Angebot ab. In angenehmer Atmosphäre, auf Wunsch mit Musikbegleitung und einem individuellen auf jeden Patienten abgestimmten Kräuter-Tee, kann jeder entspannen. Und vieles Weitere mehr, rufen Sie einfach an: Tel. 0 72 32-7 35 02 60, www.therapeuticon.de
KURSANGEBOTE, von externen Mitarbeitern:
• WALDSPAZIERGANG mit einem Förster und Waldpädagogen oder einer Waldpädagogin
• KUNSTKURSE verschiedenster Art – auch therapeutisch - von einer Kunsttherapeutin
• TROMMELKURSE in Zusammenarbeit mit der Nova-MusicSchool für die ganzheitliche Entspannung
• sowie verschiedene QI-GONG-KURSE Nehmen Sie sich die Zeit für sich und Ihre Gesundheit!
SiWAVE-Schwingungsgeräte mit revolutionärer Technik
Ein therapeutisches Konzept für die Bereiche Prävention, Rehabilitation und Regeneration

Profi- & Reha-Sport Made in Germany



Erfolge durch Studien belegt, z.B. bei:
Parkinson-Erkrankung
Rückenschmerzen
Multipler Sklerose
Lymphödem u.v.m.




Einfache Anwendung mittels Tablet












Wir beraten Sie!
Training auch im hohen Alter möglich
Anwendung wenige Minuten pro Tag
Test unverbindlich bei Ihnen zu Hause
Hocheffizient und schmerzfrei
TEPRO Apparatus GbR · Christian Wacker & Rainer Stiefel Enzstraße 82 – 84 · 75181 Pforzheim-Eutingen Tel. 0 72 31-800 75 20 · info@tepro-apparate.de


Wie Betroffene einfach & sicher aktiv bleiben können
Für Gesundheit und Wohlbefinden sind Sport und körperliche Aktivität unerlässlich. Sie stärken den Bewegungsapparat, das Herz-Kreislauf-System, fördern eine ausgeglichene Psyche und können das Risiko für Erkrankungen wie Diabetes oder Alzheimer senken. Das gilt auch für Menschen mit Hörverlust. Doch viele Betroffene fragen sich, wie sich das im Alltag gestalten lässt. Die gute Nachricht ist: Mit modernen Hörgeräten sind fast alle Trainings unkompliziert möglich.

sollte sich auch auf ein gutes Gehör verlassen können.

Viele Menschen kennen das Problem, wenn sie in der dunklen Jahreszeit unterwegs sind: Der Gegenverkehr blendet, Kontraste verschwimmen und die räumliche Wahrnehmung ist eingeschränkt.
Tatsächlich ist gutes Hören für zahlreiche Sportarten wichtig – beispielsweise, um Warnungen nicht zu verpassen oder im Teamsport Zurufe und Absprachen zu verstehen. Gerade für Letzteres sind Hörgeräte mit Technologien sinnvoll, die Stimmen hervorheben und störende Hintergrundgeräusche reduzieren. So ermöglichen die neuen audibene IX Hörgeräte müheloses Sprachverstehen auch beim Sport. Dies erleichtert die Kommunikation in lauten Umgebungen und verbessert die Interaktion in der Gruppe.
FACHKUNDIG BERATEN LASSEN
Um die Kommunikation im Sport optimal wahrnehmen zu können, sollten Hörsysteme generell regelmäßig und richtig getragen werden. Dafür ist eine fachkundige Anpassung entscheidend. Unter www.audibene.de finden sich geschulte Experten für die ideale Lösung. Zudem kommt es darauf an, die Geräte beim

Klarer sehen in der dunklen Jahreszeit Grauen Star frühzeitig erkennen und behandeln lassen
Blendender Gegenverkehr, schwindende
Kontraste: Bei Grauem Star sinkt die Verkehrstüchtigkeit deutlich. Infos unter www. beyondcataracts.de.




Bei bewegungsintensiven Sportarten wie Tennis ist es oft sinnvoll, das Hörgerät durch ein Stirnband zu schützen.





Training gut zu schützen. Ein Stirnband hält beispielsweise Feuchtigkeit ab und fixiert zusätzlich das Hörgerät bei bewegungsintensiven Sportarten wie Badminton, Tennis oder Laufen. Im Anschluss nicht vergessen, die Geräte von Schweiß, Staub und Schmutz zu reinigen.
ACHTUNG BEI WASSER
Kritisch wird es mit Hörsystemen bei Wassersportarten wie Surfen, Rudern oder Segeln, weil hier Kentern und damit Wasserkontakt nicht ausgeschlossen werden kann. Auch beim Schwimmen oder Aquafitness sollten die Hilfsmittel lieber abgesetzt werden, da sonst ihre feine Technik über die Öffnungen der Mikrofone und des Lautsprechers geschädigt werden kann.
Wer an einem Grauen Star (Katarakt) erkrankt ist, leidet unter einer zunehmenden Sehverminderung durch die fortschreitende Eintrübung der Augenlinse. 90 % aller Menschen entwickeln bis zum 65. Lebensjahr dieses Leiden, das besonders die Sicht in der Dämmerung und Dunkelheit einschränkt. Um weiterhin am Straßenverkehr teilnehmen zu können, sollte man schon bei den ersten Anzeichen aktiv werden. Typische Symptome sind gesteigerte Blendempfindlichkeit, blasser erscheinende Farben, milchige Sicht sowie eine zunehmend schlechtere Sehkraft. Spätestens jetzt ist ein augenärztlicher Check angebracht. Wird ein Katarakt diagnostiziert, muss der Grad der Seheinschränkung regelmäßig untersucht und die Verkehrstüchtigkeit geprüft werden. Doch zu Alltagsproblemen oder dem Entzug der Fahrerlaubnis muss es nicht kommen: Die moderne Augenheilkunde kann den Grauen Star und eine zusätzliche Fehlsichtigkeit erfolgreich therapieren. Dafür wird die eingetrübte Linse durch ein Kunstlinsenimplantat ersetzt, wobei gleichzeitig etwa auch eine Altersweitsichtigkeit und eine Hornhautverkrümmung korrigieren werden kann. Gute Ergebnisse erzielte hier etwa die Kunstlinsenimplantate TECNIS Eyhance IOL von Johnson & Johnson Vision in einer aktuellen Studie der Hochschule Aalen. Bei Vergleichstests im Nachtsimulator überzeugte hier die Monofokal Plus IOL vor allem beim Fahren unter schlechten Lichtverhältnissen. Patienten können dank einer speziellen Optik nicht nur Straßenschilder gut erkennen, sondern sich auch im Alltag wieder besser orientieren.
Diese Informationen ersetzen keine ärztliche Beratung und
So bedeutet Kälte Stress für den Körper, und die ausgeschütteten Stresshormone bremsen die Insulinproduktion. Grippe- und Erkältungskrankheiten können ebenfalls dazu beitragen.
Wenn im Winter die Temperaturen nach unten sinken, steigt bei vielen Menschen
Typ
der Blutzuckerspiegel an. Dafür gibt es mehrere Gründe.


süßer und fetter als im Sommer und bewegen uns weniger. Und Kekse auf der Couch lassen den Blutzucker schneller steigen als Sport und Salat. Er sollte deshalb im Winter besonders sorgfältig beobachtet werden.
Um überhöhte Werte zu vermeiden, gilt es auch bei frostigen Temperaturen in Bewegung zu bleiben – vielleicht mit mehr Indoor-Sport in der Halle, im Fitnessstudio oder einem Gymnastikvideo im Wohnzimmer. Aber auch regelmäßige Zeit im Freien ist wichtig, denn Tageslicht fördert die Erzeugung von Vitamin D, das die Insulinproduktion stabilisiert und die Ausbildung einer Insulinresistenz vermindert. Das Hormon Insulin reguliert den Blutzucker, indem es Zucker (Glu -
Stress-Futtern bei der Arbeit, gemütlich Chips knabbern auf dem Sofa, beiläufige Nascherei oder die ein Gläschen Bier oder Wein zum Feierabend: Oft merken wir gar nicht, welche Mengen Kalorien wir so ganz nebenbei zu uns nehmen.
portiert, wo er zur Energiegewinnung dient. Damit das Vitamin D seine Wirkung entfalten kann, muss es allerdings erst in seine aktive Form überführt werden. Dafür wird Magnesium benötigt. Eine gute Versorgung mit dem Mineralstoff ist also ebenfalls wichtig für einen normalen Zuckerstoffwechsel. Zusätzlich verringert Magnesium die Insulinresistenz, indem es die Zellen bei der Glucoseaufnahme unterstützt, und es trägt zu einer effektiven Verwertung des Zuckers bei. Für Menschen mit Diabetes oder einer Vorstufe der Krankheit kann deshalb eine Nahrungsergänzung wie Magnesium sinnvoll sein. Auch in Vollkornprodukten, Nüssen, Hülsenfrüchten, grünem Gemüse und Mineralwasser steckt viel von dem Mineralstoff.
geht es ebenso um das Genießen als auch ums Essverhalten. Man sollte darum genau in sich hineinhören: Will ich jetzt wirklich essen? Was für Signale gibt mir mein Körper? Tut mir dieses Essen gut? Habe ich noch Hunger? Das führt
Das kann sich schnell auf der Waage niederschlagen – was besonders für Arthrosepatienten ungünstig ist. Denn Übergewicht zählt zu den Hauptrisikofaktoren für Gelenkverschleiß. Umso wichtiger ist es, auf mehr Achtsamkeit zu setzen. „Mindful Eating“ (achtsam essen) ist darauf angelegt, sich beim Essen nur auf den Moment zu konzentrieren und ganz bewusst Geschmack, Konsistenz, Farbe, Form und Aromen wahrzunehmen. Dabei
dazu, ungünstige Ernährungsgewohnheiten zu erkennen und abzulegen, wie z.B. nebenbei am Computer zu essen. Eher schlecht für Arthrosepatienten sind Fleisch und Wurstwaren, da diese entzündungsfördernde und gelenkschädigende Arachidonsäure enthalten. Auch Süßigkeiten und Fast Food sollte man möglichst meiden. Empfehlenswert sind Gemüse, Salat, Fisch, Vollkornprodukte, Pilze, Nüsse und frisches Obst. Sie liefern
dürfen daher nicht zur Selbsttherapie verwendet werden.



Generell sollten Diabetes-Betroffene darauf achten, im Winter das Schlemmen nicht zu übertreiben. Wärmende Suppen und -eintöpfe mit winterlichen Gemüsen wie Kohl, Rote Beete, Kürbis und Karotten tun gut. Auch ist es empfehlenswert, sich warm zu halten und Infekte zu vermeiden. Die herbstlichen Impfungen gegen Grippe und Co. sind deshalb Pflicht. Infos: www.biolectra-magnesium.de
wichtige Vitamine, Mineralstoffe und Antioxidantien. Weiterhin können bioaktive Kollagen-Peptide mit Hagebuttenextrakt zur Gelenkgesundheit beitragen, indem sie die Kollagenneubildung anregen. Hagebuttenextrakt wird eine entzün-
dungshemmende Wirkung zugeschrieben. Rund 550 Teilnehmer einer Praxisstudie bestätigen die positiven Effekte in puncto Beweglichkeit und Schmerzreduktion.
Tipp: Wer gemächlich und gründlich kaut, spart meist Kalorien. Denn das erste Sättigungsgefühl setzt erst nach ungefähr 20 Minuten ein. Infos über CH-Alpha-Trinkampullen: www.ch-alpha.de.



Schön, wenn man die Enkelin wieder versteht.




Demenzerkrankungen wie Alzheimer werden in unserer alternden Gesellschaft zu einem immer größeren Gesundheitsproblem. Dabei müssen sie kein unabwendbares Schicksal sein. Denn laut der renommierten LancetKommission sind fast die Hälfte aller weltweiten Demenzerkrankungen auf 14 beeinflussbare Risikofaktoren zurückzuführen.
Zu diesen gehören unter anderem geringe Bildung, Depressionen, Bewegungsmangel, Diabetes und Rauchen. „Als größter Risikofaktor gemeinsam mit erhöhten LDL-Cholesterinwerten wurde Hörverlust identifiziert“, erklärt die Neurowissenschaftlerin Dr. Maren Stropahl von Sonova/Geers. „Ein gutes Gehör kann also helfen, das Risiko eine Demenz zu entwickeln, zu verringern.“
HÖRGERÄTE KÖNNEN GEISTIGE FITNESS FÖRDERN
Generell empfiehlt es sich, ab 50 Jahren auch ohne besonderen Anlass, regelmäßig zum Hörtest zu gehen. Rundes Foto oben: fizkesstock.adobe.com · großes Foto oben: DJD/Geers/Anchiy

sen, um aus den verstandenen Bruchstücken Sinn zu ziehen. Die Höranstrengung nimmt häufig zu, Betroffene ziehen sich daraufhin oftmals zurück und meiden soziale Anlässe – was sich negativ auf die geistigen Funktionen auswirken kann. „All dies kann durch eine geeignete Hörversorgung verbessert werden“, weiß Dr. Victoria Sanchez, promovierte Audiologin und Forscherin an der Universität von Südflorida. Sie ist Mitautorin einer kürzlich veröffentlichten Studie, die den Zusammenhang zwischen Hörversorgung und kognitiver Gesundheit genauer untersucht hat. „Es zeigte sich, dass die Versorgung mit Hörgeräten bei älteren Menschen mit erhöhtem Demenzrisiko die Abnahme der Denk- und Gedächtnisfähigkeiten über einen Zeitraum von drei Jahren um 48 Prozent verlangsamt hat.“
Hörbeeinträchtigungen sind vor allem unter älteren Menschen weit verbreitet. Nach Angaben der Weltgesundheitsorganisation WHO sind 65 Prozent der Über60-Jährigen davon betroffen. Das bedeutet häufig, dass sie Gesprächen schlecht folgen können und sich anstrengen müs-
Damit ein Hörverlust wirksam behandelt werden kann, muss er aber zunächst einmal bemerkt werden. Verständnisschwierigkeiten bei Gesprächen in größeren Gruppen, bei Hintergrundgeräuschen oder hellen Kinderstimmen können erste Anzeichen sein. Auch wenn gefühlt alle
Menschen nuscheln oder sich Familienmitglieder über die Lautstärke von Radio oder Fernseher beschweren, sollte man aufmerksam werden und einen Hörtest machen. Dieser wird bei vielen Hörakustikern kostenlos angeboten. „Generell empfiehlt es sich, ab 50 Jahren auch ohne besonderen Anlass, regelmäßig zum Hörtest zu gehen“, so Stropahl. „So kann man einfach und effektiv etwas für die eigene Lebensqualität und kognitive Gesundheit tun.“
FRAUEN HÖREN ANDERS ALS MÄNNER Früher wurden Kinder medizinisch einfach als kleine Erwachsene angesehen und behandelt. Dann waren jahrhundertelang Männer der Maßstab für Medizin und Pharmaindustrie. Mittlerweile ist endlich die Gendermedizin auf dem Vormarsch. In der Hörakustik weiß man immerhin bereits seit 2009: Frauen und Männer hören anders, wie eine Studie aus Texas damals feststellte. Ein Jahr später legte eine Studie der Universität Tübingen nach: Anhand von Versuchen wurde bewiesen, dass Frauen beim Richtungshören deutlich schlechter abschneiden. Männer können aber Hintergrundgeräusche besser ausblenden.
WARUM FRAUEN HOHE TÖNE
BESSER HÖREN
Dafür verarbeitet das weibliche Gehirn Gehörtes rascher. Man weiß außerdem heute, dass Frauen in allen Altersgruppen hohe Töne im Frequenzbereich von mehr als 2000 Hz besser hören, Männer dagegen tiefe Töne unter 1000 – 2000 Hz. Dieses Phänomen nimmt mit dem Alter noch zu. Dass Frauen im höheren und leisen Tonbereich leichter hören und emotionaler reagieren, ist biologisch bedingt –damit sie hohe, zarte Babystimmen schneller hören und darauf reagieren. Aber es hat auch physiologische Gründe. Erstens ist die weibliche Hörschnecke kürzer und verarbeitet daher Schall schneller. Zweitens verschafft das Östrogen Frauen einen Hörvorteil, sodass deren Altersschwerhörigkeit meist später einsetzt als bei Männern.
INDIVIDUELL EINSTELLBARE TECHNOLOGIE
Mittlerweile hat sich auch die Hörgeräteindustrie auf diese Tatsachen eingestellt: So gibt es jetzt beispielsweise das moderne Hörsystem IX von audibene, das als erstes Gerät dank zweier Echtzeitprozessoren eine individuelle Trennung von Sprachverstehen und Störgeräusch erlaubt. Per App kann jeder Träger seine persönliche Einstellung wählen – sogar auch nach geschlechterspezifischen Stärken und Schwächen. Das Richtungshören ist so ausgefeilt, dass es Stimmen präzise und in Echtzeit erfasst und sogar mitverfolgt, wenn der Sprecher sich im Raum bewegt.
KOSTENLOSES PROBETRAGEN
Gute Hörhilfen werden in unserer alternden Gesellschaft immer wichtiger, denn jeder Dritte über
50 hat eine Hörminderung. Betroffene merken dies jedoch selbst oft sehr spät, da die Schwerhörigkeit meist schleichend voranschreitet. Umso wichtiger sind regelmäßige Checks. Hörakustiker bieten meist eine unverbindliche Beratung sowie ein kostenloses Probetragen eines Hörgeräts an. Denn je früher ein nachlassendes Gehör technisch unterstützt wird, umso erfolgversprechender ist das Ergebnis. Musik, Naturgeräusche und Unterhaltungen können wieder genossen werden – und das verbindet. Weitere Infos: www.audibene.de
KINDEROHREN GUT VOR
LÄRM
Ob im Fußballstadion oder bei anderen Großveranstaltungen, beim gemeinsamen Musizieren, einem Freiluftkonzert oder im Vergnügungspark: Bei vielen Freizeitaktivitäten, an denen auch Kinder teilnehmen, kann es sehr laut werden. So werden etwa in einem Stadion durch das Gemisch von Gesängen, Geschrei, Pyrotechnik und Co. Schallpegel von bis zu 120 Dezibel erreicht. Zum Vergleich: Eine vorbeifahrende U-Bahn kommt immerhin auf 100 dB. Solche Lautstärken können schon bei relativ kurzer Einwirkung herausfordernd für die Ohren sein. Daher ist es wichtig, in lauter Umgebung auf einen effektiven Gehörschutz zu achten. Da die Kleinen häufig noch nicht selbst das Bewusstsein für die eigene Hörgesundheit haben oder für ihren Schutz sorgen können, sollten Eltern darauf
achten, bei Aktivitäten und Veranstaltungen mit hohem Schallpegel passenden Gehörschutz für den Nachwuchs dabeizuhaben – und am besten auch für sich selbst. Fachspezialisten empfehlen für Kinder einen Kapselgehörschutz. „Dieser dichtet gut ab, da er die Ohrmuschel einschließt und so auch den sogenannten Knochenschall über den Schädelknochen abdämpft”, erklärt Anja Dreßen, Pädakustikexpertin beim deutschen Hörakustikunternehmen Geers. Noch dazu sehen die auch als „Mickey Mäuse“ bekannten Schutzkapseln mit ihren bunten Farben cool aus und geben Kindern in ungewohnter und lauter Umgebung ein Gefühl von Sicherheit. „Kopfhörer, die nicht als Gehörschutz ausgewiesen sind, sollten dagegen nicht verwendet werden, da sie den Schall nicht adäquat dämpfen“, rät die Expertin.
MIT GUTEM BEISPIEL
VORANGEHEN

Bei lautstarken Veranstaltungen an Gehörschutz für die Kinder denken.
Als Alternative zum Kapselgehörschutz sorgen Ohrenstöpsel für ausreichend Schalldämmung. „Die handelsüblichen Modelle aus Schaumstoff haben jedoch eine schwächere Dämmwirkung. Durch ihre Passform sind sie für die häufig etwas kleine -ren Kinderohren nicht optimal ausgelegt. Dennoch sind sie besser als gar kein Schutz“, weiß Dreßen. Wichtig ist, dem Nachwuchs zu erklären, warum ein Gehörschutz sinnvoll ist. Das kann dann gleich der Anlass für die Erwachsenen sein, auch auf das eigene Gehör zu achten, um die Hörgesundheit in jedem Alter zu
fördern. Selbst gut geschützt ist man nämlich gleichzeitig auch das beste Beispiel für Kinder. Mehr Infos: www.geers.de.
HILFE DURCH IMPLANTAT
Ein Implantat kann eine Option sein, Sprache wieder besser zu verstehen, Geräusche wahrzunehmen und somit auch die mentale Gesundheit und die Lebensqualität zu verbessern. Das CI-System imitiert die Funktion eines gesunden Innenohrs, der Cochlea. Es sendet anders als Hörgeräte elektrische Signale an den Hörnerv – und ersetzt damit die beschädigten Haarzellen im Innenohr. Die Kosten zahlt in der Regel die gesetzliche Krankenkasse.
Allein in Deutschland leben heute mehr als 55.000 Kinder und Erwachsene mit der Innenohrprothese; Experten gehen davon aus, dass hierzulande bis zu einer Million schwerhörige Menschen vom CI profitieren könnten. Anzeichen für eine Hörbeeinträchtigung können sein, wenn man z.B. die Gäste auf einer Feier nicht mehr so gut versteht. Vermuten Sie, dass Ihr Kind oder Enkel eine Hörminderung hat? Dann am besten zum Hörtest beim Akustiker. Oftmals stellt sich auch heraus, dass viele Menschen mit ihrem Hörgerät unzufrieden sind.
Unter dem Motto „HEAR Together“ fanden Betroffene auf der Cochlear-Hörmesse Berlin Informationen, die ihnen weiterhelfen könnten. Im Fokus standen Hörgeräte und Hörlösungen wie Cochlea-Implantate (CI). Gefeiert wurde auch das 40-jährige Jubiläum von Cochlea-Implantaten in Deutschland. Die Messe sieht sich als Plattform für Austausch und Vernetzung.

im Ristorante Comedia, ab € 89,–/Pers.

Tickets online & im Kartenbüro des Kulturhauses Osterfeld.









ALLE KÜNSTLER DES VARIETÉPROGRAMMS AUF EINEN BLICK:
Tobias Gnacke - Moderation
Eine Show mit Parodie, Bauchreden, Quatsch und jeder Menge Musik. Sein Programm bewegt sich zwischen Comedy, Kabarett und klassischer Unterhaltungsshow.
Cecilia Hedlund - Equilibristik
In schwindelerregender Höhe präsentiert sie einen beeindruckenden Balan-
ceakt. Auf einer wackligen Konstruktion übereinander getürmter Stühle zeigt die elegante Schwedin außergewöhnliche und faszinierende Handstände.
Charlotte de la Bretèque - Multicordes Die Luftnummer „Multicordes“ ist eine besondere Mischung aus Strapaten, Handstand und Akrobatik. Charlotte de la Bretèque entwickelte diese neue und faszinierende Disziplin eines Vorhangs aus vielen Seilen während ihrer Ausbildung an der Zirkusschule in Brüssel.
Herr Strunk - Diabolo
Herr Strunk versteht es, seinen Diabolos ein wahres Eigenleben einzuhauchen und in so atemberaubender Geschwindigkeit fliegen zu lassen, dass das Zuschauerauge ihren rasenden Bewegungen kaum folgen kann.
Duo Nat & Jo - Vertikalseil
Die spektakuläre Darbietung zieht das Publikum mit Stil und Tempo in ihren Bann. Im Mittelpunkt steht die Idee, dass sich zwei Körper gemeinsam bewegen


Cecilia Hedlund
Equilibristik

Tobias Gnacke Moderation









Das „Varieté zwischen den Jahren“ knüpft an die großen Erfolge der Vorjahre an. Auch in diesem Jahr ist es dem Kulturhaus wieder gelungen, die Stars der internationalen Varieté-Szene auf die OsterfeldBühne zu bringen. Mit Vertikalseil, Zauberei, Hand auf Hand, Diabolo, Equilibristik, Multicordes und Einrad entführen sie uns in ihre „Winterträume“.

und sich gegenseitig beim Auf- und Abstieg und beim Durchhalten helfen.
Duo Bénélo - Hand auf Hand „Die Diva“ Die Diva ist eine Ode an Kraft und Anmut – ein schwebender Moment purer Magie. Lyrik, Reinheit, Ästhetik und die Schönheit der Körper verschmelzen zu einer Symbiose.
Duo Nat & Jo- Einrad Die Duo-Einrad-Darbietung verbindet nahtlos Akrobatik, Hebefiguren, fließende

Charlotte de la Bretèque Multicordes


Bewegungen, Tanz und kreative Einradmanöver. Diese Darbietung fasziniert mit ihrer innovativen Herangehensweise.
Topas - Zauberei
Topas ist jüngster Weltmeister der Manipulation in der Geschichte der Zauberkunst. Mit virtuoser Fingerfertigkeit, neuartigen Effekten und großen Illusionen feiert er Erfolge im In- und Ausland: Las Vegas, Yokohama, Monte Carlo ... und Pforzheim.

Duo Bénélo Hand auf Hand »Die Diva«






Duo Nat & Jo Einrad
www.kulturhaus-osterfeld.de und an allen Reservix-VVK-Stellen

Sa. 11.01 18.00 Uhr

Physik Event Das ultimative Physik-Erlebnis
Fr. 14.02. 20.00 Uhr

Tobias Gnacke Wer jagt gewinnt Comedy

Alfons Jetzt noch deutscherer


Hans Gerzlich Ich hatte mich früher jünger in Erinnerung



Wartke Wunderpunkt Musik-Kabarett
Do. 16.01. Die Feisten 20.00 Uhr Familienfest · Musik-Comedy
Sa. 18.01. Marty Hall 20.00 Uhr The High Art of Minimalism · Konzert
Do. 30.01. Helge Thun 19.30 Uhr Nah dran · Schwindelnd flinke Finger-Dinger
Fr. 31.01. Café del Mundo 20.00 Uhr Winterhauch · Akustik-Gitarren-Konzert
So. 02.02. Friedas Weltuntergang 18.00 Uhr Theater unter der Dauseck e.V.
Do. 13.02. Lisa Federle & Bernd Kohlhepp 19.00 Uhr Das Lese-Erlebnis · Kabarett
Sa. 15.02. Werner Koczwara 20.00 Uhr Sternhagelschwäbisch · Kabarett
So. 16.02. Alles nur Magie 19.00 Uhr Zauber-Gala
Sa. 08.03. Jonas Greiner 19.30 Uhr Greiner für alle · Comedy
Do. 13.03. Backblech
20.00 Uhr Heimspiel - Die Familie, die ich rief · Comedy
Fr. 14.03. Willy Astor


20.00 Uhr Reimart & Lachkunde – Prädikat wortvoll · Comedy
Sa. 15.03. Tauschrausch
20.00 Uhr Impro-Comedy
Sa. 22.03. Abdelkarim 20.00 Uhr Plan Z - jetzt will er´s wissen! · Kabarett
Fr. 28.03. Boris Stijelja 19.30 Uhr Die Cevapcici-Therapie · Comedy
Sa. 29.03. Jasmin Tabatabai & David Klein Quartett 20.00 Uhr Jagd auf Rehe · Konzert







Gernot Leibold (1955 - 2020, geb. in Karlsruhe) bezeichnete sich selbst als Goldschmied und mit einem Augenzwinkern als Ebenisten „mit ausgeprägtem Cardillac-Syndrom und einer Leidenschaft für geschlossene Werkgruppen“. In seiner Diplomarbeit 1986 schrieb er: „Nichts auf der Welt hat mich je mehr fasziniert als Schmuck.“

Brosche »Piet«: Kunststoff, Citrin; Gernot Leibold, Karlsruhe 2016; 2016 fur den Staatspreis »Gestaltung Kunst Handwerk« Baden-Wurttemberg nominiert; Foto: Carsten Birnbaum



Broschen »Gruß an Louise«: Kunststoff, Farbsteine; Gernot Leibold, Karlsruhe 2016; Fotos: Carsten Birnbaum


















„Bereits als Kind krallte ich mir den Strassschmuck meiner Mutter, dessen Glitzern mich fesselte. Ich konnte nie genug davon bekommen, und so zehrte diese frühe Leidenschaft mein gesamtes Taschengeld auf… Die Begeisterung für Glitzerzeug jeder Art ist mir bis heute geblieben, und jede Anhäufung von Brillanten, egal ob echt oder unecht, lässt diese Leidenschaft wieder aufflammen.“
Nicht nur die Freude an Glitzerzeug, sondern auch seine Passion für das Aufstöbern und Sammeln von unterschiedlichsten, oft farbenfrohen Materialien und Gegenständen, wie Bauklötzchen, Legosteine, Garnrollen, Murmeln, Lüster oder bunte Kunststoffteile, begleiteten ihn ein Leben lang. Es war sein Fundus und die Basis für seine Schmuckgestaltung.

Brosche »Schwarze Struktur Nr. 6«: Ebenholz, Kunststoff, Silber, Stahl; Gernot Leibold, Karlsruhe 2017; 2018 mit dem HerbertHofmann-Preis ausgezeichnet; Foto: Carsten Birnbaum






Anhänger »Milch, Honig, Blut«: Elfenbein, Perlmutt, Zuchtperlen; Aluminium, Bernstein, Kunststoff; Granat, Turmalin, Kunststoff; Gernot Leibold, Karlsruhe 2013; Fotos: Carsten Birnbaum






„Interessant an seinem Werk ist, dass es sich durch zwei Bereiche auszeichnet“, erläutert Museumsleiterin Cornelie Holzach. „Zum einen fertigte Leibold hochwertigen Juwelenschmuck mit eigener Handschrift; zum anderen entwickelte er künstlerische Arbeiten in hochpräziser Technik.“
Für seine quadratische Brosche »Schwarze Struktur Nr. 6« erhielt Gernot Leibold 2018 den Herbert-Hofmann-Preis. Sie überzeugte die Jury durch ihre Materialkombination und die Formgebung. Kunststoff, Ebenholz, Silber und Stahl sind wie zu einer halbgeöffneten Schachtel zusammengefügt, deren schwarzes Innenleben aufgrund seiner geheimnisvollen Struktur neugierig macht, es zu erkunden.
Die Ausstellung im Schmuckmuseum Pforzheim, in der Arbeiten aus Gernot Leibolds Nachlass gezeigt werden, richtet den Fokus auf seine künstlerischen Arbeiten sowie auf frühe Stücke, die während seines Studiums in Pforzheim entstanden sind. »Legoschnitt und Glitzerzeug« ist kuratiert von Elisabeth Heine und Cornelie Holzach und läuft noch bis zum 23. Februar 2025. Die Schau findet in Kooperation mit der »Galerie für Schmuck · Kunst · Design in den Schmuckwelten Pforzheim« statt. Dort können Stücke aus Gernot Leibolds Nachlass erworben werden. Der Eintrittspreis ist im Besuch der Dauerausstellung inbegriffen.
Öffnungszeiten: Di. – So. & feiertags 10 – 17 Uhr (außer Hl. Abend & Silvester) • Eintritt in die Dauerausstellung: 4,50 €, ermäßigt 2,50 € • Familienkarte: 7,50 € • bis 14 Jahre und mit Museums-Pass-Musées: frei • Gruppenführungen auf Anfrage • Öffentliche Führung durch die Dauerausstellung, sonntags 15 Uhr: 6,50 €, ermäßigt 4,50 € • Förderverein ISSP: www.issp-schmuckmuseum.de • Medienbzw. Kulturpartner des Schmuckmuseums sind Pforzheimer Zeitung & SWR Kultur • Weitere Informationen unter www.schmuckmuseum.de









Das Theater Pforzheim hat wieder ein sinnliches, abwechslungsreiches Programm für die Weihnachtszeit zusammengestellt: Theaterfreunde können sich auf ein schillerndes Festtags-Paket voller OpernDramatik, Musical-Songs und Komödien-Feuerwerk freuen. Viele der Produktionen sind auch im kommenden Jahr noch zu sehen und bescheren schöne Stunden voller Unterhaltung und Abwechslung. Und wer sich regelmäßig die interessanten Stücke im Repertoire nicht entgehen lassen will, kann auch jetzt noch bei einem der 33 Abonnements oder erst einmal in ein kleines, feines Weihnachtsabo einsteigen!


„STILLE NACHT, HEILIGE NACHT“ Montag, 23.12.24, um 19.30 Uhr
„Stille Nacht, Heilige Nacht“ – so heißt es auch diesmal wieder, wenn das Theater Pforzheim zu seinem traditionellen Weihnachts-Benefizkonzert einlädt. Auch in diesem Jahr gehen sämtliche Einnahmen an die PZ-Aktion „Menschen in Not“.
„AIDA“ – OPER VON GIUSEPPE VERDI Mittwoch, 25.12.24, um 19 Uhr und Freitag, 27.12.24, um 19.30 Uhr Es ist eine der berühmtesten Dreiecksgeschichten auf der Opernbühne: Der Feldheer Radamès liebt die Sklavin Aida, soll aber die ägyptische Prinzessin Am-
mit großen Chornummern und dem berühmten Triumphmarsch mit Trompetensoli ist eine der beliebtesten Werke der Musikgeschichte.

„DER GESTIEFELTE KATER“ –FAMILIENSTÜCK NACH DEN GEBRÜDERN GRIMM Donnerstag, 26.12.24, um 15 Uhr Mit „Der gestiefelte Kater“ zeigt das Theater Pforzheim eine charmante Geschichte rund um einen gewitzten Kater. In dem klassischen Märchen finden sich Motive, die auch in der heutigen Zeit Bestand haben: Ungerechtigkeit zwischen Arm und Reich, Anwenden einer List, Freundschaft, Dankbarkeit und Glück.

Karten für alle Vorstellungen: Ticketcenter am Pforzheimer Waisenhausplatz, Tel. 0 72 31 / 39 - 24 40 • www.theater-pforzheim.de •



„HOW TO DATE A FEMINIST“ KOMÖDIE VON SAMANTHA ELLIS

Freitag, 27.12.24, Samstag, 28.12.24 und Sonntag, 29.12.24, um 20 Uhr
Sie ist Wonder Woman, er Robin Hood: Kate flirtet auf einer trendigen Mottoparty mit Steve, um ihrem Ex-Freund eins auszuwischen. Und Steve, Bäcker und überzeugter Feminist, weil als Sohn einer alternativ bewegten Mutter im Frauencamp aufgewachsen, ist hingerissen. Die rasante Komödie der Britin Samantha Ellis stellt inmitten der Genderdebatte lustvoll alle Rollenklischees auf den Kopf – und ihren Figuren auf der Suche nach dem Glück ein Bein nach dem anderen.

„A CHRISTMAS CAROL – EINE WEIHNACHTSGESCHICHTE“ – MUSICAL VON ALAN MENKEN & LYNN AHRENS
Samstag, 28.12.24, um 19.30 Uhr und Sonntag, 29.12.24, um 15 Uhr „Bah! Humbug, dieses Fest!“ Der geizige und grausame Geldverleiher Ebenezer Scrooge hasst Weihnachten. Nicht einmal das Fest der Liebe kann bei ihm Mitgefühl für Mitmenschen wecken. Doch da erscheint ihm ein Geist …. Das bezaubernde Musical für die ganze Familie wurde 1994 in New York uraufgeführt, 2016 erlebte es in London seine europäische Premiere; in Pforzheim ist es erstmals in deutscher Sprache zu erleben.
„FAME – DAS MUSICAL“ –MUSICAL VON STEVE MARGOSHES UND JACQUES LEVY



Montag, 30.12.24, um 20 Uhr und SILVESTER, Dienstag, 31.12.24, um 19 Uhr Ewiger Ruhm – wer will ihn nicht? Die multikulturelle und diverse Truppe, die jüngst die

Aufnahmeprüfung der High School of Performancing Arts in New York bestanden hat, will ihn auf jeden Fall. Für die Geschichte um die sechs Studierenden hat Steve Margoshes eine mitreißende Musik kom poniert, die das Publikum zurück ins New York der 80er Jahre versetzt.
„ICH
GERN MIR GÄSTE EIN –GOLDENE OPERETTEN-PERLEN“


EIN GLANZVOLLER SILVESTERABEND SILVESTER, Dienstag, 31.12.24, um 18 + 21 Uhr Das Jahr 2024 klingt im Dreivierteltakt aus: Bei dem Operettenabend erklingen die schönsten Arien aus Opern und Operetten von Jacques Offenbach, Johann Strauß und vielen anderen mehr. Es singen die Ensemblemitglieder des Theaters Pforzheim; freuen kann man sich auf einen unvergesslichen Silvesterabend!
DIE VORTEILE AUF EINEN BLICK
• Künstler unmittelbar live erleben
• vielfältiges Angebot, auch jenseits der „Spielplan-Klassiker“
• Gemeinschaftserlebnis: zu diesen Preisermäßigungen bis zu zwei Begleitpersonen zur Abovorstellung mitnehmen
• 25 bis 35 % Preisermäßigung gegenüber Tageskassen-Preisen
• ca. 15 % Preisermäßigung für Sinfoniekonzerte des Theaters
• Stammplatz-Garantie
• übertragbare Abo-Ausweise
• großzügige Umtauschmöglichkeit
• günstige Ratenzahlung möglich
• bargeldlose Zahlungsmöglichkeit
• Sonderbusse aus über 140 Gemeinden
• Abo-Plus: Preisvorteile auch an anderen Theatern
• Schwerbehinderte ab GdB 80 erhalten Abos zum JugendaboPreis (mit bis zu 63 % Preisvorteil gegenüber der Tageskasse)

AM THEATER
WEIHNACHTSABO DIENSTAG AB 48,00 € jeweils um 20 Uhr im Großen Haus 21.01.25 Tristan und Isolde 18.02.25 Fame – Das Musical 11.03.25 Parzival 08.04.25 Die Legende von Georgia McBride
WEIHNACHTSABO SAMSTAG AB 52,50 € jeweils um 19:30 Uhr im Großen Haus 08.03.25 Così fan tutte 29.03.25 Singin’ in the rain
26.04.25 Die Legende von Georgia McBride 07.06.25 Cavalleria rusticana / Der Bajazzo
WEIHNACHTSABO SONNTAGNACHMITTAG AB 51,00 € jeweils um 15 Uhr im Großen Haus 09.02.25 Parzival 23.03.25 Black Swan / Wonder 04.05.25 Singin’ in the rain 29.06.25 Cavalleria rusticana / Der Bajazzo
WEIHNACHTSABO SONNTAGABEND AB 48,00 € jeweils um 19 Uhr im Großen Haus 16.03.25 Fame – Das Musical 06.04.25 Die Legende von Georgia McBride 18.05.25 Die verlorene Ehre der Katharina Blum 15.06.25 Singin’ in the rain
WEIHNACHTSABO KONZERT AB 42,90 € jeweils um 18 Uhr im CCP 13.04.25 4. Sinfoniekonzert „Mozart Mon Ami“ 01.06.25 5. Sinfoniekonzert „Aus der Neuen Welt“ 13.07.25 6. Sinfoniekonzert „Mahlers Fünfte“
Unser Aboservice berät Sie gerne!
Di. - Fr. 10 – 16 Uhr Tel.: 07231 / 39 22 56 abo@pforzheim.de www.theater-pforzheim.de



Eine gesunde Ernährung fällt vielen im Winter schwer, insbesondere während der Weihnachtszeit. Kein Wunder: Überall Lebkuchen und Plätzchen. Auch die herzhaften Gerichte werden mit Aufläufen und Braten wieder mächtiger. Eine gesunde und einfache Lösung kann mit Hafer gelingen, er enthält viele Proteine, Vitamine und Ballaststoffe.
Hafer gehört seit Jahrhunderten zu unserer Ernährung, meistens essen wir ihn in Form von Haferflocken. Diese sind Vollkornprodukte und enthalten den Ballaststoff Hafer-Beta-Glucan: Er bildet mit der Flüssigkeit aus der Nahrung ein Gel, das den Magen beruhigt und die Darmwand schützt. Dadurch werden Nährstoffe langsamer ab-

Hafer-Ingwer-SchokoCookies und Hafer-BananeSchoko-Riegel

gebaut und Cholesterin-, Blutzucker- und Insulinspiegel reguliert. Ob in herzhaften oder süßen Gerichten, Hafer kann vielfältig in Rezepten genutzt werden, ohne dabei auf Genuss zu verzichten.Haferflocken können beim Backen bis zu einem Drittel der Mehlmenge ersetzen und so die Ballaststoffmenge erhöhen. Wie das konkret funktioniert, zeigen z.B. die Rezepte für Hafer-Banane-SchokoRiegel und Hafer-Ingwer-SchokoCookies unter www.hafer-diealleskoerner.de.
Auch lassen sich Nüsse durch Haferflocken ersetzen, da das Getreide einen leicht nussigen Geschmack hat. Dadurch werden weihnachtliche Gerichte für Nussallergiker verträglich.
REZEPT WINTERLICHE HAFER-WRAPS Sie sind innerhalb von etwa 30 Minuten leicht zuzubereiten, plus zwei Stunden Ruhezeit.
Zutaten für 4 Portionen: 90 g zarte Haferflocken, 2 kleine Eier, 160 – 200 ml Milch 1,5 % Fett, 4 TL Rapsöl, ½ Kopf Rotkohl, 10 Datteln, 80 g Walnüsse, 150 g Frischkäse, 1 EL Honig, Salz, Pfeffer Zubereitung (ca. 30 Minuten): Haferflocken im Mixer oder Mörser zermahlen. Eier mit Milch und 1/4 TL Salz verquirlen und Haferflocken zugeben. Den Teig zehn Minuten quellen lassen. Nacheinander je 1 TL Öl in einer beschichteten Pfanne erhitzen und aus dem Teig vier Wraps (Pfannkuchen) ausbacken und auskühlen lassen. In der Zwischenzeit den Rotkohlstrunk entfernen und Rotkohl in sehr dünne Streifen schneiden, waschen und durchkneten. Die Datteln fein würfeln und die Walnüsse hacken. Alle Zutaten mit dem Frischkäse mischen und mit Honig, Pfeffer und Salz abschmecken. Füllung auf die Wraps streichen, eng zusammenrollen und zwei Stunden kühl stellen.
Weitere Infos: www.alleskoerner.de




Besonders beliebt sind Dips, die sowohl Fleisch und knuspriges Baguette zu einer echten Köstlichkeit machen. Selbst gemachter Frischkäse ist dafür eine tolle Basis. Die Grundzutaten: Milch und Lab. Die Milch wird auf 30 bis 36° C erwärmt und mit dem Lab versetzt. Nach einigen Stunden Ruhe an einem warmen Ort (Masse zwischendurch einmal schneiden) ist der Frischkäse fertig und muss nur noch abtropfen. Jetzt können daraus herrlich frische Dips kreiert werden. Weitere Infos: alpenrose-kaeselab.de
PAPRIKACREME „TRICOLORE“
Zutaten: 50 g Quark, 300 g Frischkäse, 20-50 g Chilisoße Sweet, 1 EL Tomatenmark, Salz & Pfeffer, je 1 rote, grüne, gelbe Paprika Zubereitung: Quark und Frischkäse mit dem Schneebesen zu einer cremigen Masse verrühren. Paprikas waschen und entkernen. Ein paar Streifen für die Garnitur beiseitelegen. Den Rest sehr fein würfeln, unter die Käsemasse ziehen und mit süßer Chilisoße, Ketchup, Salz und Pfeffer abschmecken.
FRISCHKÄSECREME „MEDITERRANE“
Zutaten: 100 g Quark, 300 g Frischkäse, 100 g Sardellen in Öl, 6 Tomaten, 4 EL grüne Oliven ohne Stein, Pfeffer Zubereitung: Sardellen trocken tupfen und fein hacken. Den Quark mit dem selbst gemachten Frischkäse verrühren. Tomaten waschen und in kleine Würfel schneiden. Tomaten, Oliven und Sardellen in die Frischkäsemasse rühren, mit Salz und Pfeffer abschmecken.
MEERRETTICHCREME
Zutaten: 100 g Quark, 300 g Frischkäse, 100 g Meerrettich gerieben, Schnittlauch, Salz, 1 Spritzer Zitronensaft
Zubereitung: Quark und Frischkäse mit dem Schneebesen cremig verrühren. Meerrettich langsam unterrühren. Anschließend mit Salz abschmecken und je nach Geschmack einen Spritzer Zitronensaft hinzugeben. Mit fein gehacktem Schnittlauch verfeinern.
Köstliche Dips gehören zu jedem Buffet. Eine tolle Basis dafür ist selbst gemachter Frischkäse.
FranzbrötchenLikör ist eine leckere Zutat für köstliche Shakes.






Zimtig-zuckrig, aromatisch duftend und köstlich klebrig – so muss es sein, das perfekte Franzbrötchen. Und längst ist das Kult-Gebäck aus Hamburg nicht nur im hohen Norden beliebt, sondern hat seinen Eroberungsfeldzug durch die Republik angetreten. Zum Beispiel in flüssiger Form mit dem Hamburger Sahnelikör Franzi. Die Geschwister Ann-Katrin und Johann Dallmeyer haben gemeinsam die krümelfreie Version des Franzbrötchens auf Sahnebasis entwickelt. Neben Zimt, karamellisiertem Zucker, Butter, Teigaromen, 15 Prozent Alkohol und einem Hauch Vanille kann man den leckeren Klassiker jetzt auch trinken. Passend zum Winter gibt es die Variante „Gebrannte Mandel“. Alle Versionen lassen sich pur genießen oder für köstliche Desserts, Eis- und Backvariationen, als Soße oder Zutat verwenden.

Gebrannte Mandel zum Winter: Es gibt limitierte Liköre passend zu jeder Jahreszeit.





Rezepte: www.franzi-likoer.de.
Zutaten in etwa selben Mengen (je ca. 200 ml/g): Franzi Franzbrötchenlikör, Vanille-Eis, Apfelmus. Optional: Eiswürfel, Milch, 1 Löffel Zimt, 1 halbes Franzbrötchen für mehr Textur. Zubereitung: Alle Zutaten in einen Mixer geben und kurz und kräftig mixen. Bei längerem Mixen entsteht eine festere Creme, die auch sehr gut für Desserts verwendet werden kann. Nun noch garnieren, zum Beispiel mit karamellisierten Apfelstückchen, Erdbeeren, Minzblättchen oder Schoko-Sticks.







In der dunklen Jahreszeit und speziell im Trauermonat November beschäftigen sich viele Menschen mit der eigenen letzten Reise und machen sich Gedanken über die Wünsche für die eigene Bestattung.
Dafür gibt es nicht nur emotionale, sondern auch sachliche Gründe: Die Gesamtkosten einer Beerdigung belaufen sich nach Angaben der Webseite TodesfallCheckliste.de auf aktuell durchschnittlich rund 13.000 Euro, durch frühzeitige Planung und Absicherung können sie besser kalkuliert und abgesichert werden. Wer frühzeitig seine persönlichen Wünsche für die eigene Bestattung festlegt, stellt sicher, dass sie umgesetzt werden. Mit einer Bestattungsvorsorge entlastet man seine Angehörigen von Entscheidungen und finanziellen Belastungen.

ERINNERUNGSDIAMANT UND CO.
Bei besonderen Formen des Gedenkens wie einem Erinnerungsdiamanten ist
Fachgeschäft für Floristik
Fleurop-Service Grabpflege Wir beraten Sie gern!
Hachelallee 3 · 75179 Pforzheim
Tel. 0 72 31 - 31 34 55
info@blumenschaefer.de www.blumenschaefer.de
Vorsorge noch wichtiger. Denn schon zu Lebzeiten wird die Auswahl über Größe, Anzahl und passenden Schliff getroffen, die Angehörigen erhalten nach dem Tod den oder die Diamanten. Das Verfahren zur Umwandlung von Kremationsasche oder von Haaren in einen Diamanten wurde von der Firma Algordanza in der Schweiz entwickelt. Im Rahmen der Vorsorgegarantie kann man zu Lebzeiten durch einen Vertrag mit einem rechtlich selbstständigen Partnerunternehmen festlegen, welche und wie viele Diamanten aus der Asche oder den Haaren transformiert werden sollen. Bei der Finanzierung ist eine Anzahlung in Höhe von 50 % der Gesamtsumme möglich, der Rest wird nach Erstellung des Diamanten fällig. Wer die Angehörigen komplett entlasten möchte, zahlt bei Vertragsabschluss den Gesamtbetrag auf ein unabhängig verwaltetes Konto ein.
lenserklärung sollte man in seine Dokumentenmappe legen – wo sich auch Geburts- und Heiratsurkunden befinden. Denn dies sind die ersten Dokumente, die ein Bestatter im Sterbefall benötigt. Den eigenen Bestattungswunsch im Testament zu verfügen, reicht nicht aus, da die Testamentseröffnung meist Wochen nach dem Tod beziehungsweise der Beisetzung stattfindet.

WARUM BESTATTUNGSVORSORGE
BESSER IST ALS DAS SPARBUCH Legt man statt einer Bestattungsvorsorge Geld auf dem Sparbuch zurück, so haben die Angehörigen darauf nicht automatisch Anspruch, denn die Summe wurde nicht „zweckgebunden“ angelegt. Ein weiterer Vorzug der Bestattungsvorsorge gegenüber dem Sparbuch: Sie gehört zum Schonvermögen und muss nicht für andere Zwecke angetastet werden, denn sie dient nur der Finanzierung der Bestattungskosten. Die im Rahmen der Bestattungsvorsorge unterzeichnete Wil-
SCHMUCKSTÜCKE MIT DEM AUSGEWÄHLTEN ERINNERUNGSDIAMANTEN Das Schweizer Unternehmen Algordanza bietet bereits seit 20 Jahren Erinnerungsdiamanten an, die dort auch legal hergestellt werden. Jeder Erinnerungsdiamant verkörpert individuell die Erinnerung an einen geliebten Menschen. Für die Schweizer war es daher wichtig, dass auch das Schmuckstück, das den Diamanten umgibt, einmalig ist und gut mit ihm harmoniert. Entstanden sind zwei Kollektionen aus Ringen, Anhängern, Broschen sowie Colliers, die in hochwertigem Rot-, Weiß- und Gelbgold oder in Platin angeboten werden. Bei der Auswahl des Schmuckstücks ist die bestellte Größe des jeweiligen Erinnerungsdiamanten zu beachten. Für die Ringe gibt es auch die Möglichkeit einer Gravur auf der Innenseite der Ringschiene. Interessenten wenden sich in Deutschland an ein Bestattungsunternehmen ihrer Wahl. Um eine Diamantbestattung durchführen zu können, werden 250 Gramm Kremationsasche oder fünf bis zehn Gramm Haare benötigt. Daraus wird der verbliebene Kohlenstoff extrahiert, der zunächst in Grafit umgewandelt und später bei extremem Druck und sehr hohen Temperaturen zu einem Diamanten transformiert wird.
Unter www.algordanza.com gibt es alle weiteren Infos über die Auswahl der Schmuckstücke und ihre Verarbeitung.
Im Rahmen einer Bestattungsvorsorge kann man sich bereits zu Lebzeiten für einen Erinnerungsdiamanten aus Asche oder Haaren entscheiden. Dies sind noch recht ungewöhnliche Optionen des Gedenkens an eine oder einen Verstorbenen.

AUSTAUSCH MIT FAMILIE UND FREUNDEN



ERINNERUNGSSCHMUCK ALS ALLTAGSBEGLEITER
Wer eine geliebte Person verliert, muss mit starken Emotionen fertig werden. Damit geht jeder anders um: Die einen lassen ihrer Verzweiflung freien Lauf, andere wiederum wollen ihre Gefühle lieber nicht offen zeigen. Viele Menschen suchen Wege, dem Verstorbenen während des Alltags in Gedanken nahe zu sein.
SYMBOLISCHE ERINNERUNGSSTÜCKE
Auch das Familienunternehmen Pur Solutions in Nettetal am Niederrhein hat hier eine eigene Trauerschmuck-Kollektion im Repertoire, denn beim Umgang mit schmerzlichen Emotionen können nicht nur symbolische Erinnerungsstücke wie Ringe oder Amulette mit Fotos helfen, sondern auch Trauerschmuck mit individuellem Inhalt oder Fingerabdruck. Bei diesen Schmuckstücken aus hochwertigem Edelstahl mit Gold- und Silberakzenten oder edlen Steinen werden Haarlocken, Blüten oder Asche des Verstorbenen in eine unsichtbare Kammer eingeschlossen.
Persönliche Erinnerungen können sich auch auf einer kleinen Platte befinden, die Arm oder Hals unauffällig schmückt. Darauf wurde ein Fingerabdruck des Verstorbenen mit einem Laser aufgetragen. Ausgewählter Trauerschmuck findet sich unter: nano-erinnerungsschmuck.de.
STILLE BEGLEITER IM ALLTAG

In einer Kammer können Haare oder Asche des Verstorbenen eingeschlossen sein.
Auf dem steinigen Weg, Trauer zu bewältigen, ist dieser Schmuck für Hinterbliebene ein stiller Begleiter. Eva Deppe von Pur Solutions sagt: „Der Abschied und die Akzeptanz der neuen Lebensumstände können durch Trauerschmuck erleichtert werden. Die Menschen tragen ja quasi einen Teil des Verstorbenen im Alltag mit sich.“ Es gibt nach ihren Worten noch viele weitere Beispiele für individuelle Erinnerungsstücke: So können etwa Kleidungsstücke wie Omas Lieblingskittel oder Papas kariertes Lieblingshemd einfach zu Trauer-Kuscheltieren umgearbeitet werden. Manchem helfen auch Rituale wie das Anzünden einer Trauerkerze zu bestimmten Tageszeiten.
Dr. med. Steffen Häfner ist Facharzt für Psychosomatische Medizin und Psychotherapie und ärztlicher Direktor der Klinik „Am schönen Moos“ im baden-württembergischen Bad Saulgau. Er rät Trauernden zu einem Austausch über ihre Emotionen: „Wer dazu bereit ist, sollte mit Familie und Freunden reden und seine Empfindungen teilen. Seine Gefühle zu unterdrücken erschwert hingegen, das Erlebte zu verarbeiten.
Trauernde sollten zudem darauf achten, weiterhin gut für sich zu sorgen. Dazu zählt ausreichend Schlaf, gesunde Ernährung und auch Zeit für Aktivitäten, die Freude bereiten. Durch ein gesundes Maß an Ablenkung lässt sich neue Kraft schöpfen. Außerdem gilt es, geduldig mit sich zu sein, denn eine festgelegte Dauer für die schmerzlichen Emotionen gibt es nicht.“

GRABGESTALTUNG
Wir gestalten und pflegen Ihr Grab individuell nach Ihren Wünschen
DAUERGRABPFLEGE
Garantiert ein gepflegtes Grab über Jahrzehnte
TRAUERBEGLEITUNG
Unterstützung, um den Verlust eines geliebten Menschen zu verarbeiten
Telefon: 0 72 31 - 10 69 18 Ispringer Str. 42 b · 75177 Pforzheim www.friedhofsgaertnerei-hilligardt.de Mo - Fr 8 –18 Uhr · Sa 8 –16 Uhr · So 10 -12 Uhr


Wenn es um Kapitalanlagen geht, stehen viele vor dem Dilemma: Wählen sie ein kostengünstiges, passives Investment, das sich eins zu eins an einem Index orientiert? Oder entscheiden sie sich für eine aktiv gemanagte, aber dafür teurere Anlage? Die gute Nachricht: Es ist beides gleichzeitig möglich und das ohne höhere Kosten. Dafür sorgen aktive Exchange Traded Funds (ETFs). J.P. Morgan Asset Management etwa ist ein Pionier aktiv gemanagter ETFs mit einem breiten und vielfach ausgezeichneten Angebot. Infos unter www.jpmam.de.


RENTENLÜCKE NOCH SCHNELL SCHLIESSEN?


Immer beliebter bei der privaten Vorsorge werden Einmalbeitragsprodukte. Man zahlt kurz vor Renteneintritt eine größere Summe in eine private Rentenversicherung ein und kann damit auf einen Schlag einen Teil der Rentenlücke schließen. Viele Menschen wollen zudem flexibel bleiben: Bei vielen Versicherungsgesellschaften kann man bei bestimmten Neuverträgen schon nach zwei Jahren eine Kapitalzahlung erhalten oder eine Rente beziehen. Infos: www.allianz.de.
DIGITAL ZAHLEN UND ANONYM BLEIBEN
Mit dem digitalen Euro will die EZB eine digitale Alternative zum Bargeld schaffen. Beispielsweise an der Supermarktkasse kann man dann anonym zahlen, nur eben in digitaler Form. „Weil der digitale Euro ein technisch und rechtlich anspruchsvolles Projekt ist, ist die Einführung frühestens ab 2028 oder 2029 realistisch“, so Dr. Andreas Bley vom Bundesverband der Volksbanken und Raiffeisenbanken (BVR). Mit dem digitalen Euro kann man digital zahlen, ohne dass die entsprechenden Daten von Zahlungsdienstleistern oder Händlern gespeichert werden. Wer eine PayApp nutzt, kann dort auch den Bestand abfragen.
In turbulenten wirtschaftlichen Zeiten wird es immer schwieriger, Entscheidungen in Sachen Geldanlage zu treffen. Eine gute Beratung ist gefragter denn je. Die Vermögensberater bieten genau das. Gemeinsam mit ihren Kunden entwickeln sie passgenaue Finanzkonzepte. So behalten die Kundinnen und Kunden jederzeit den Überblick im Finanz-Dschungel.
Mehr Informationen: www.dvag.de.


SPARSCHWEIN FÜTTERN
Ein finanzielles Polster hilft bei unvorhersehbaren Ausgaben. Warum aus dem Sparen nicht einen sportlichen Wettbewerb machen? Wer sich vornimmt, Restgeld nicht direkt wieder auszugeben, sondern ins Sparschwein zu stecken, kommt dem Ziel schrittweise näher. Wichtig ist es, sich mehr Transparenz über die eigene Finanzlage zu verschaffen. Hilfreich ist dafür ein Haushaltsbuch, entweder auf Papier oder online. Infos: www.geldundhaushalt.de



PFORZHEIM TurmQuartier
14.02.25
Benefizkonzert InnerWheel
20.02.25 Führung „Kunst im TurmQuartier“
27.03.25
03.04.25
Multivisionsshow
AfterWork Führung „Frühlingsbrise“
PFORZHEIM CongressCentrum (Stadthalle)
15.12.24
Paul Potts Piano: The Greatest Hits
17.12.24 Tribute to Ella Fitzgerald
22.12.24
Nussknacker – Der Ballettklassiker
€ 12,00 - 25,00
€ 15,00
€ 10,00 - 15,00
€ 19,00
€ 50,90
€ 25,40 - 34,20
13.11.25 Kastelruther Spatzen – Frieden-
€ 50,90 - 88,90 sadler – live on Tour 2025“
29.11.25 Bülent Ceylan – Yallah hopp!
14.12.25 Kaya Yanar – Lost
PFORZHEIM Kulturhaus Osterfeld
19.12.24 bis Winter Träume
06.01.25
€ 41,70 - 57,80
€ 58,40
€ 19,00 - 39,50
€ 50,00 - 60,00 für die ganze Familie
17.01.25 Heinrich del Core – Juhuu, meine
€ 50,00 - 60,00
€ 29,00 - 35,00 Frau wird Oma!
19.01.25 Tarzan – Das Musical
22.01.24
Dr. Mark Benecke – Blutspuren
25.01.25 62. Goldstadtpokal 2025
29.01.25 ABBA – Mamma Mia and much more
02.02.25 Time changes – 3. Abonnement-
€ 25,00 - 33,00
€ 41,80
€ 15,00 -100,00
€ 43,60 - 76,60
€ 30,00 - 59,00 konzert SWDKO
04.02.25 Schwanensee
11.02.25 The Music of Hans Zimmer & Others
€ 39,50 - 64,50
€ 38,40 - 78,40
13.02.25 Romantischer Jazz für zwei Herzen – € 20,00 - 25,00 Piano show & Sand show
14.02.25 Die Nacht der Musicals
15.02.25 SIXX PAXX – Colors Tour 24/25
16.02.25 Das Phantom der Oper
23.02.25 3. Sinfoniekonzert – Krieg und
€ 43,60 - 76,60
€ 45,90 -120,90
€ 66,70 - 86,50
€ 20,00 - 41,00 Versöhnung
28.02.25 The Spirit of Freddie Mercury
18.01.25 Marty Hall – The High Art of € 20,00 Minimalism
30.01.25 Helge Thun – Nah dran € 22,00
13.02.25 Lisa Federle & Bernd Kohlhepp – € 24,00 Das Lese-Erlebnis
15.02.25 Werner Koczwara – Sternhagel-
€ 24,00 schwäbisch
08.03.25 Jonas Greiner – Greiner für alle € 22,00
13.03.25 Backblech – Heimspiel – die Familie, € 23,20 die ich rief
03.+04.04.25 Sandie Wollasch & Matthias Hautsch – € 19,00 the simple live
09.04.25 Irish Spring – Festival € 34,50
03.05.25 „Cover up mit special guest Shelly € 25,00 Bonet Benefizkonzert“
16.05.25 Michael Hatzius – Echsklusiv € 26,00
BRÖTZINGEN Mottenkäfig
22.12.24 Besinnliche Weihnachten – Last Minute € 19,00
28.+29.12.24 Die kleine Hexe € 9,00
€ 43,60 - 76,60
€ 43,60 - 76,60 featuring Queen Sensation
15.03.25 Jan & Henry 2 – Ein neuer Fall für die € 31,00 - 34,00 Erdmännchen
16.03.25 Lords of The Elements – Musical
€ 45,10 - 78,10 Fantasy Show
19.03.25 Dr. Eckart von Hirschhausen: Mensch
€ 40,85 - 51,85 Erde! Wir könnten es so schön haben
20.03.25 Bodo Wardtke – Das 7. Klavier-
17.+18.01.25 Die Gesänge der Wale € 16,00
31.01. bis Dracula € 16,00
01.02.25
REMCHINGEN Kulturhalle
20.12.24 Phil – The Genesis & Phil Collins € 30,00 Tribute Show
19.01.25 1. Remchinge Lachnacht € 27,00
€ 35,00 - 45,00
€ 35,00 - 45,00 kabarett-Programm
23.03.25 Helvetia – 4. Abonnementkonzert
€ 25,00 - 56,00 SWDKO
26.03.25 Johann König: Wer Pläne macht
€ 35,15 - 43,95 wird ausgelacht!
30.03.25 Ernst Hutter & Die Egerländer
€ 55,00 - 69,00 Musikanten
05.04.25 Nico Stank – Akte Ex
€ 47,95
13.04.25 4. Sinfoniekonzert – Mozart Mon Ami € 20,00 - 41,00
22.04.25 Prime Orchestra – Rock Sympho Show € 30,00 - 70,00
18.05.25 British Accent – 5. Abonnement- € 25,00 - 56,00 konzert SWDKO
27.05.25
The Scottish Music Parade
01.06.25 5. Sinfoniekonzert – Aus der
€ 36,80 - 78,10
€ 20,00 - 41,00 Neuen Welt
29.06.25 Sommerträume – 6. Abonnement-
13.07.25
€ 30,00 - 59,00 konzert SWDKO
6. Sinfoniekonzert – Mahlers Fünfte
12.11.25 Alexander Stevens & Constantin
€ 20,00 - 41,00
€ 38,40 - 98,40 Schreiber: Angeklagt – Schuldig oder nicht? LIVE
08.02.25 Herr Stumphes Zieh & Zupf Kapelle – € 30,00 - 33,00 Abschiedstour
15.02.25 Noah Leonne – Live in Concert € 26,00 - 29,00
20.03.25 Oropax – Ordentlich Chaos € 23,00 - 27,00
STUTTGART Schleyerhalle
14.12.24 Deichkind € 63,95 - 67,95
15.12.24 Trettmann € 60,95
17.01.25 Alligatoah € 70,90
22.+23.02.25 Cavalluna – Grand Moments € 56,45 -205,79
25.02.25 Ludovico Einaudi € 68,50 -153,50
25.03.25 David Garrett € 83,40 -158,40
28.03.25 Avantasia € 72,20 - 82,20
25.04.25 Roland Kaiser €110,90 -140,90
28.09.25 Parkway Drive € 56,00 - 93,40
09.10.25 FiNCH
€ 59,90 - 69,90
26.10.25 Simply Red € 73,30 -137,75
27.10.25 Nina Chuba € 53,10 - 72,65
28.11.25 SDP € 72,14
02.12.25 Kontra K. € 56,50 - 86,40
Preise inkl. Gebühren und ges. MwSt. Angaben ohne Gewähr.
















































Jetzzt beraten n lassen wie Sie
Mehr f Ihre ina auf energeti nzieren. f sparkas n lassen, ische San se-pfcw.de/s , wie Sie nierung anieren
Weil’s um mehr p r als Geld geht
Weil s um mehr geht.













orzheim Ca Pf Sparkasse alw e